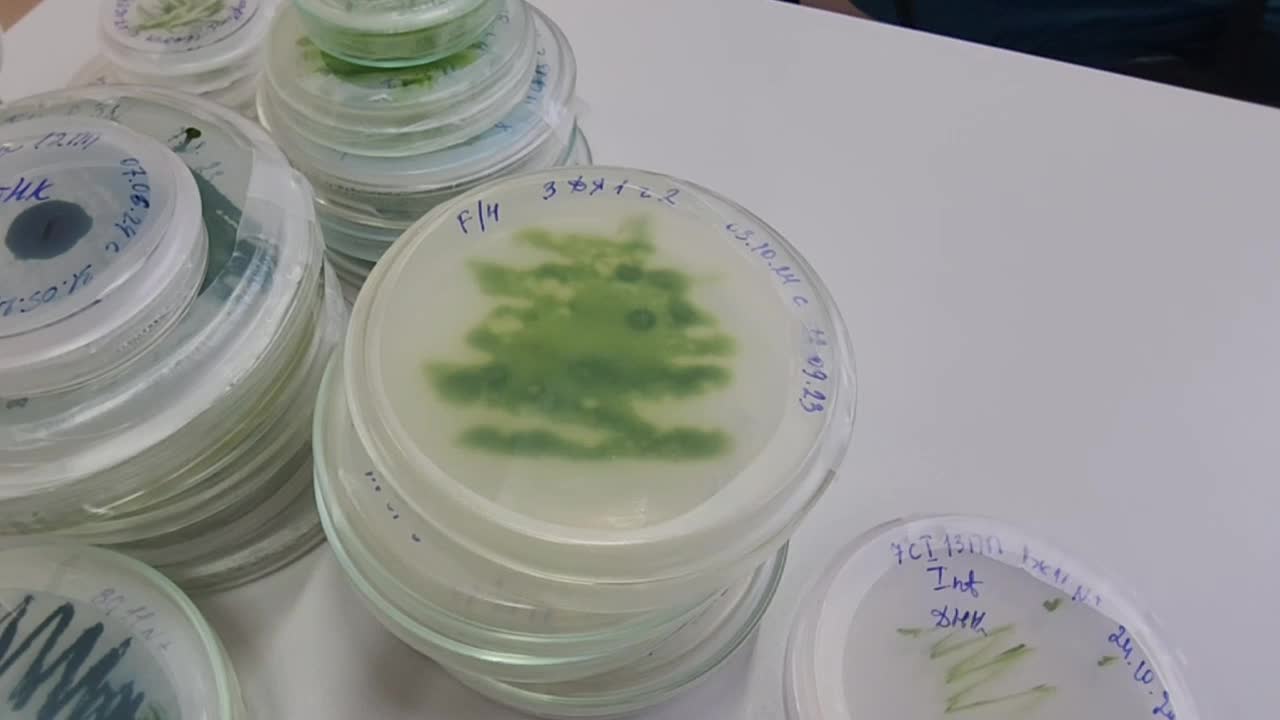

Общество
Экономика
Спецоперация
Медицина
Образование
ЖКХ
Эксклюзив
Города
волонтеры
мусор
Выездная администрация
видео с коптера
теракт
этап отбора в общественную палату
Каникулы в Подмосков
Гастрономические бренды
Приют для кошек
Приют лучик
СК РФ по РВСН
нелегальные мигранты
птицефабрика Петелино
сезон самокатов
сепзонэлектросамокатов
заведующий
личное первенство
спортсмены с овз
молодые журналисты
профилактика онкологии
портреты героев
Герои города С
Московский политех
Производство домов
Деревянные дома
Книжный клуб
тренеровка
памятник воробьеву
чемпионатное движение профессионалы
Уникальное оборудование в детском саду
младшие классы
новый путепровод
путепровод в красногорске
путепровод в аникеевке
Власиха ЖКХ и благоустройство
алла прима
Лухоицы
памятник летчику
каяки
студия народных промыслов
городецкая роспись
производство крахмала
переработка кукурузы
конструкторское бюро
ограждения
установка оград
изготовление ограждений
сварочные работы
экскурсовод
всероссийский конкурс лучших проектов создания ко
беседа с волонтрами
Опора
конвейер
сортировка тюльпанов
приемка тюльпанов
обвязка
вязальные аппараты
Анна попова
ремонт участка канализационной сети
красноармейская 27
новый врач-педиатр
китель героя
массовая атака беспилотников
Атака бпла
прокат самокатов
сезон проката самокатов
балет тодес
Спецслужбы потушили огонь
комната боевой славы
трофей
дрон
Обломки
Всу
дренажные канавы
уборка улицы Захаркина
жк малая истра
Госархив МО
шумозащитный экран
замена шумозащитных экранов
замена шумозащитных экранов на новорижском шоссе
новорижское шоссе
викторина про вов
гимназия 4 лыткарино
Весенний бал
хастл
Замена дорожных знаков
котельная в истре
Игры для детей
большая игра
рыбаков фонд
форсайт-сессия
капремонт лицея
китайское образование
россия и китай
Дом после атаки БПЛА
покровская школа в истре
пристройка к школе в истре
ЖК Ильинойс
строительство в красногорске
центр мещерякова
жк кембридж
тренировка по гольфу
Народная программа
пешеходный надземный переход
стройготовность детского сада
выездной прием областного НИКИ детства
смет мусора
Подметально-уборочная машина
поливочная машина
Евгений Зубов
злой город
сергей февралев
дом-музей народных увеселений
скоморошьяслобода
татьянасмирнова
вертеп виктора назарити
Сельхозпредприятие
Коровье молоко
миниатюра
курилы
Власиха ХВС
ГНБ во Власихе
новый трубопровод
Рустехнобизнес
Фильтры водоотведения
Ассоциация ветеранов СВО
Власиха ветераны СВО
чеспионат
службы
Ремонт Новой Риги
Шумовы экраны
Замена шумовых экранов
чемпонат для школьников
детская писательница
Подъезды к лицею имени Долгих
Промывка
тепловизоры
поврежденные квартиры
презентация фильма
грибная ферма
шатурский краеведческий музей
шатурский центр созвездие
ДШИ шатура
бурение
нижняя площадка
Спортивная ходьба
исторический квест
города герои
патриотические мероприятия
фотовыставка городов героев
подготовка к паводку
ФК Сатурн
геральдика
будем жить
троянцы
новое павлино
ФОК Салют
свечка
обучение игре на флейте
почетная грамота президента рф
государственная награда
Стритарт
стройтрансгаз
БРИКС
Автовладельцы
Подготовка машин к лету
фошань
русско-китайская дружба
шатурская детская библиотека
шатурская дши
музыкальный
Ризница
Кирилло-белозерский музей-заповедник
Женщины России
грязная вода
живая классика
проза
дмитрий кожушко
улица Ильича 38
капитальный ремонт кровли
капремонт крыши
новый каркас
покрытие кровли
Фонд капитального ремонта Московской области
Фонд капремонта Московской области
Выставка техники
музей техники Вадима Задорожного
МИГ-25 БМ
военный самолет
новый экспонат в музее техники Задорожного
Пешие проогулки
Истомкино
поливка улиц
физическая культура
Санитарная вырубка
макет
капсула
союз мс
продажа
освещение больницы
капремонт стадиона полет
влажная уборка улиц
Мастер-классы по профессиям
Дубаи
аварийное дерево
Эндокринологический центр в Одинцово
ЖК Большое Путилково
Паровой котел
Центральная модельная библиотека
72-летний мужчина на СВО
Вячеслав Шевяков
Книга Мобилизация
авария водопровод
отдел Краеведческая среда
культурные коды
Алексей Прокин
архив газет
Средняя школа 1
Федеральная программа Школьный автобус
Котел
Модернизация систем теплоснабжения
Летний театр
аджимукай
аджимукайские каменоломни
Обоащения жителей к администрации
Встреча жителей с представителями администрации
Платная парковка
парк лобни
безопасность жизнедеятельности на судне
фок в лобне
МЦД-4 Ольгино
Родительство
психоневрологический диспансер
Врач-пульмонолог
Дом урядника
История хотьково
плотины в Красногорске
плотина на реке Синичка
плотина на реке Банька
Гидроузлы
проверка гидроузлов
ХК Торнадо
Село макарово
декларация
новый склад
соляная комната
подготовка к посевной
весенний период
пункт управления обеспечением транспортной безопа
инвентарь
средства малой механизации
подготовка к весенне-летнему сезону
укус клеща
детская поликлиника Власиха
ЭГЭ для родителей
Одинцовская гимназия 4
пироплазмоз
замена труб в в домах
замена коммуникаций
приборы учета
территориальный отдел Видное
несанкционированные объекты торговли
Андрей Михайлов
Присяга главы
Перемены Молодежный
день Спартакиада
кск
кервский дом культуры
хор полюшка
день сдачи егэ родителями
парковки для инвалидов
егэ с родителями
за кулисами театра
школа 29
издательство ad marginem
книжный маркет
михаил семенов
Моют памятники
почетный гражданин Наро-Фоминска
Светлана Малыхина
группа компаний Гранель
новые лифты
замена лифтов в Оптическом переулке
замена лифтов в Красногорске
юбиляр
Строительство физкультурно-оздоровительного компле
Внутрення отделка ФОК
Утепление фасада эллинга
гимназия 7 лыткарино
Текстурные картины
яхрома взу
проверка готовности к пожароопасному периоду
капремонт крыши в Зарайске
Квартал Южный
мартовский снег
комитет по жкх наро-фоминск
спортивные соревнования
дворец спорта борисоглебский
китель победы
память поколений
детский педиатр
моу сош 2 лыткарино
патриотическая игра катюша
Что делать при укусе змеи
Военно-патриотическая автомат Калашников
снаряжение
костюм ОЗК
первенство по карате
демонтаж катка
вучетич
спасательная станция
дежурство
власиха медицина
запрись к врачу
озеро исток
ЕМИАС
Воссоединение Крыма
зона сво
боброво
самовольная постройка
профилактическая акция
кожно-венерологический диспансер
Высадка лука
Диджеинг
Молодежный центр Шатура
лагоустройство
боксер Ян Богданов
спортшкола Витязь
Кубок мира по боксу
мусорный бак
Черногория
спортивный клуб тигры на базе раменского колледжа
набор детей в секции спортивных игр
кикшерингнапаузе
электросамокаты на паузе
какшеринг на паузе
прокат электросамокатов
студия танцев
Тарасов-Арбатский
тренеровки
одц октябрь
крымская весна
мемориал памяти
ремонт гимназии 23
медиа-матч
музей милиции
дворец культуры родина
лицей 7 детский сад
глава администрации городского округа Владимир Во
детский сад химки
капремонт детского сада наследие
поле
берзовый сок
Собак-проводники
чарково
Самара
Севастопольский вальс
11 лет в родной гавани
Конкурс логистов
концерт с родителями
играем вместе
открытый урок истории
СУНЦ МГУ
улица кожевенная
гигиена полости рта
зубы
Воссоединение Крыма с Россией
день воссоединения крыма с россией
ЖК Малина
строительство в Нахабино
строительство в ЖК Малина
Музыкальное мероприятие
Турнир по самбо
Проект Твой герой
Горизонтально направленное бурение
11-я годовщина воссоединения крыма с россии
будущий рукопашник
Пакетти-Групп
собаки-проводники
Мастер года 2025
Ангелово
Биннофарм групп
пресс-тур
Погружение в Коломну
Выставка в ДШИ имени Голубкиной
крым и россия
воссоединение
Крым наш
Крым Россия
Референдум в Крыму
спасение ребенка
ЖК М-5
группа компаний Садовое кольцо
раменская школа 35 вектор успеха
урок по колокольному искусству
спортивная секция
баки-колокола
отделка
Публичные слушания
центр формирования и сохранения диализного доступа
эстакада в Аникеевке
Дом культуры веселево
школьная весна
Маршрут автобуса 1
смена резины
замена змней резины
пораипереобуваться
Маршрут 21
маршрут 43
молодые люди
довоенная подготовка
занятия по первой медицинской помощи
Пожарные учения
коломна благоустройство
набережная реки коломенка
парк мира в коломне
тарнспорт
Автобус 46 сергиев посад
пристройка на 200 мест
профилактика туберкулеза
театр ангел
проверка автобусов мострансавто
новоград
Зарайск - Котельники
Маршрут 330
льгота
единый день эвакуации
котельниковская поликлиника
лыткаринская теплосеть
Конноспортивный клуб
сезон посадки
театральная неделя
тугофест2025
foodexpo
мастерклассы
MITT
международная выставка туризма
монтаж инженерных сетей
слаботочные системы
мультимедиа
лотки под кабель
слаботочные сети
зеленоград
александр меус
вопрос священнику
частный музей
молодежный перемены
Новый школьный автобус
наро-фоминское патп
конкурс безалкогольных вин
выставка MITT
безалкогольное вино
улица энтузиастов
ручные пылесосы
46 Заозерная Власиха
транспорт лыткарино
автостанция лыткарино
лыткарино автобус 1
Термоленд МКД
Валлаби
крестьянская улица
Кенгуру
Лихачевский проспект
автобус 542П
проверка маршрута
автобус в Красногорске
помещение для поделок
Мануфактуры Гарднеръ в Вербилках
Фарфоровый завод
полигон царево
школьный спорт
Мойка остановок
благоустройство в озерах
карьер западный
молодежная ярмарка вакансий
улица Весенняя 20
протечка трубы ГВС
устранение проблемы
просушка подвала
дезинфекция
Фряновская больница
косилка-плющилка
график движения
салон
детский сад в подлипки-город
левый берег
временная выставка
печень
МАП 5
обеды
Кровли
счетчики
гибдд руза
синяя птица гжели
лыткарино спорт
дворец спорта арена лыткарино
многоборье гто
зубово
секреты дружного класса
конкурс для всех
щелковские очистные сооружения
экология щелково
Пассажир
Встреча с жителями фряново
Автобус 368-У
Автостанция Бронницы
Маршрут 5 Бронницы
новые котлы и насосы
демонтаж старого оборудования
вечер
счастье
автобус 520
установка новых знаков
новый заведующий
строительство в Красногрске
дублел пятницкого шоссе
Городской автобус
Речная улица
соревнования по художественной гимнастике
весенние цветы
сквер пушкина
дендропарк
собака повадырь
собака друг
школа1100
новая школа в Павшинской пойме
новая школа в Красногорске
строителсьтво
Власиха ДК
выездная администрация успенский
День поэзии
Котельная в Ермолино
общежитие
памятник героям сво
галомера
Власиха центр СВО
Некрасовский сквер
школьный конкурс
специальности
шейный платок
весенний сезон
предприятие по производству куриной продукции в к
блогерство
попугай
тоннель в Путилково
Строительство тоннеля
Строительство в Путилково
стоматологи
здоровье полости рта
лидия жарова
писатели подмосковья
всемирный день поэзии
выпускники 2025
акция 100 баллов для победы
школа центр
площадь славы Балашиха
медицина красногорска
образование в химках
строительство новогорск
школа 8 в химках
капремонт школы 8 в химках
капремонт роддома в химках
детский сад 9 в химках
реконструкция детского сада
проектная мастерская
всероссийский конкурс проектов
Там на неведомых дорожках
Фестиваль сказок
стадион луч
фк артист
Катан е на лошадях
послок Зарайский
Врач построила дом
поселок Зарайский
остановка Восход
автобус 60
состояние автобуса
чистые реки
постные блюда
незаконное строение
Выездная бригада врачей
флейтистка юлия зарщикова
флейтистка ева зарщикова
отселение из ЗАТО
сертификат на отселение
Власиха ЗАТО
маршрут 827
проверка маршрута 827
автобус 827
маршрут в Красногорске
МЦД Павшино - МЦД Нахабино
тяжелое медицинское оборудование
конфликты
чат-бот
бесконфликтная школа
ФОК Власиха
муниципальные соревнования
дивизия дзержинского
народный художественный промысел
Дом вверх дном
улица Ильича 33
капитальный ремонт фундамента
цоколь
заполнение пустот
укрепление и усиление фундамента
Новые светофоры
ЦБДД Подмосковья
уборка остановок
новый стационар
дубна орбита
топливные баки
ройгас
дамба
ВСОШ по астрономии
лавриненко
благодарный шкаф лыткарино
экологичный образ жизни
улица почтовая
лито шатура
шатурская библиотека
дети на уборке
день писателя
работник культуры
бегун
кладовая солнца
фолк-рок
школа 16
Дорога к участкам многодетных семей
стадион зоркий
стадион в красногорске
щукин
фок в кашире
фок с ледовой ареной
трубопровод в кашире
канализационная сеть в кашире
ремонт напорной канализационной сети
кашира ремонт трубопровода
ремонт канализационного трубопровода
ремонт канализационной сети в кашире
православный театр
Баскетбольный клуб
Спарта энд К
день работников культуры
школа1
Танк-маршрут
Чемпионка мира по самбо
открытие бани
лыткаринские бани
Моют остановки
Влажная уборка города
аграрный техникум
весенние работы
Детские кресла
валежник
строительство бмк
Власиха Заозерная 5
дом ветерана ВОВ
цветная бумага
очистные в дмитрове
строительство очистных
уличная мозаика
Николо-Угрешский монастырь
лук-севок
стационар краткосрочного пребывания
Чипирование собак
челюскин
Мемориал Героям
микрорайон Школьный
микрорайон Тополек
детская школа искусств рапсодия
Автослесарь
Автослесарь для скорой
поселок андреевка
андреевская поликлиника
первый мед
александр кирин
Врач-стоматолог
благоустройство сквера в дубне
Пилотирование
Бездомный
Жк 1-й Донской
богородская резьба
владимир алманов
резьба по льду
Строительство завода
Леся Ярославская
выездная алминистрация
футбольные фанаты
водосточная труба
подъемный кран
противопожарный период
ситуационный центр
борьба с пажарами
очистные в дубне
работники культуры
новый собор
фалеристика
белые журавли
наталья мозерова
фларфики
Зарайский кремль
Экскурсии для школьников
Власиха Фоменко
Власиха почетный житель
звание почетный житель
победа в олимпиаде
Инспектор ПДН
Власиха спорткомплекс
футбол Власиха
СВОим
подземный пешеходный переход в Удельной
микрорайон силикат
кузьминский лесопарк
клуб фадеристов
красногорск медицина
реабилитация детей в красногорске
образовательный центр созвездие
деревня Люторецкое
завод Электрощит
печки для участников СВО
печки для обогрева и приготовления пищи
центр военной подготовки Рокот
лагерь и полигон
обучение бойцов
электротехническое оборудование
подстанции
клуб фалеристов
новая дорого в Путилково
Пиятницкое шоссе - Путилково
Мост через реку Журавка
Строительство новой дороги
наркоз
Поведение
Оценки
Тарковский
Киноклуб
90-летние со дня образования службы ПДН
ремонт спорткомплекса
академия тенниса в Красногорске
академия тенниса Шамиля Тарпищева
спортивный реабилитационый центр
гимназия 1 рузы
юрисконсульт
пенсия
Участок для врачей
Построили дом
арт-встречи
ИХТИС
Майкл Джексон
ремонт мемориала
ЛОР-комбайн
Фряновская поликлиника
неделя детской книги
Лекция о бпла
Встреча с Росгвардией
строительство взу
день рожденья оияи
Березняки
Дк юность
труженицы тыла
ларёк
молодежный день донора
восстановление пешеходной дорожки на улице михале
Развязка на Дмитровском шоссе
весенняя охота
охота на селезня
охота на гуся
охота на вальдшнепа
Открытие охоты в Зарайске
пункт приема вторсырья
Девушка водитель автобуса
Бронницкое АТП
хор мальчиков и юношей
пионерия
Сборка автомата
80 летие победы
день театра
ЖК Одинбург
Новая школа в Одинцово
строительство в Одинцово
ногинский колледж
c sharp
Власиха остановочные павильоны
ремонт остановок
Подготовка к 1 классу
Кабельный завод
день росгвардии
Власиха Заозрный
модернизация сетей водоснабжения
новые специалисты
ремонт тротуара на улице михалевича
петровская усадьба
врач-нефролог
День работников театра
театральная студия сказка
сценическое искусство
Открытый микрофон
Доначисления за гвс и хвс
кают компания
история российского флота
боцман
Сезонная аллергия
Поллиноз
Врач-аллерголог-иммунолог
Багги
бизнес в дмитрове
завод по производству еды в дмитрове
медиашкола
благоустройство дубны
центральная улица дубны
велопешеходный маршрут в дубне
образование в щелково
детский сад космос в щелково
детский сад в щелково
детский сад на улице Неделина
Врач аллерголог-иммунолог
Новый врач-аллерголог
Музей брендов
Музей спички
древний водопровод
перемены наро-фоминск
благоустройство города
история одного памятника
Красят лавочки
платные парковки в Одинцово
парковаться в Одинцово
поддержка семей участников сво
Золотые россыпи
школьная НПК
7-я школа
Леший
генетическая болезнь
витя ивко
священнослужители
болагоустройство
месяц чистоты
ремонт дома на Школьной улице
ремонт дома в Красногорске
Ежегодный отчет главы
семейный фестиваль
белка
орехи
семечки
ип
встреча с бизнесом
общественная палата Балашихи
Платные парковки в Видном
всероссийский пленэр
дк силикат
капремонт школы 24 в Монино
школы в щелково
школа 21 в щелково
капремонт школы в серково
беларусь
стация болшево
улица Заводская
час военной истории
военная история
битва при курской дуге
Советник
Уборки
Месячник
молодые инженеры
Единый день диспансеризации
Соревнования по гиревому спорту
международный день птиц
дуплянки
дома для птиц
весенне-полевые работы
подкормка озимых
корабль Иван Папанин
Арктика
Гусляры России
история праздника
фронтовые песни
бедрос киркоров
Кубок квн
юмористы со всей России
спорсмены
сборная команда Московской области
группа Авантюра
фестиваль Добрый рок
экспозиции
уникальные артифакты
Военно-патриотический клуб
ПСЧ 343
федорцово
Экспериментальная музыка
мать-и-мачеха
цветение растений
лекарственные растения
Ковровая вышивка
региональный портал госуслуг
электронная заявка
условия
документы
титаны
технологическое предпринимательство
видеосвязь
прикосновение на расстоянии
скамейка
Шлюзовая
звезды футбола
щелковский перепляс
автограф сессия
Лукино-Варино
свердловский
Зарайская весна
Фестиваль искусств в Зарайске
3D -принтер
система сброса
нефопам
памятник подольским курсантам
присвоение звания
комиссариат
аэрокобра
истребитель
1 апреля
замена бордюров
ргазу
новый физкультурно-оздоровительный комплекс на ма
Власиха весенняя уборка
молочное такси
Ночь в театре
юные инженеры
лови волну
Интересные люди Звенигорода
школа 19 в щелково
Кружок кVадрокоптер»
олимпиада по испанскому языку
печатная продукция
Шуховская башня
Луговая
Утилизация батареек
Чехо
юные патриоты
строительство жилого кластера в истре
завтра была война
нюрнбергский процесс
образовательный центр Сабурово
прием первоклассников
школа в Сабурово
капремонт лицея 14 в щелково
Валентина Яньшина
Знаменитость
стадион для регби в щелково
строительство стадиона для регби
строительство бассейна в монино
строительство фока в щелково
вандализм
уединение
опашка деревень
защита от пожаров
1-й класс
Поступление в 1-й класс
Военно-патриатический клуб
Работа с молодежью
ремонт дамбы в талдоме
ремонт дамбы в парке солнечный берег
запись в 1 класс
образовательный комплекс
запись ребенка в школу
учитель китайского языка
Власиха образование
Власиха торговля
магазины Власиха
ЖК Большевик
прием в школу
бесшовный переход
домики в миниатюре
поликлиника в Нахабино
инженерное оборудование в коломне
изготовления трубопроводной арматуры
КДЦ в Дмитрове
всероссийские соревнования по бадминтону
тропинки
велодорожки
ОЦ Успех
кототерапия
звезда израненная
памятники вов
Котокафе
порт
плавучий госпиталь
заводы
посёлок биокомбината
набережная наро-фоминск
Благоустройство 2025
юный вундеркинд
прием заявлений
из сада в школу
улица крупской
замена кабеля
госпиталь в балашихе
строительство госпиталя в ольгино
этап зачисления
межзональный конкурс вокалистов
рассада овощей
растениеводство
перцы
баклажаны
капуста
форум классных руководителей
Сбор мукулатуры
парк Бугрова в Ногинске
благоустройство парка Бугрова
новый фельдшер
капремонт школы 30 в Электроуглях
гимназия города раменское
подстанция скорой помощи в Ногинске
медицина Ногинска
новый корпус ЦО 5 в Ногинске
ремонт центра образования 5 в Ногинске
медицина в ногинске
строительство поликлиники в Ногинске
сно
Новое оборудование в больнице
Загорянский
дети детям
тимофята
Реставрация трактора У-2
балет на льду
ледовый балет пируэт
ледовый дворец имени шалимова
фигурно катание в наро-фоминске
физико-технический класс
Опалиховский лесопарк
кино победы
реконструкция теплотрассы
Сквер вдоль пролетарского проспекта
Новые дорожки
строительство моста через оку
федеральная трасса М2
Всемирный день здоровья
Мойка отбойников
Пристройка к лицею
прим документов в школу
Николо-Урюпино
единая школьная лигаа
педагог-художник
строительство газопровода
удаление опухоли почки у пациента
развитие инфраструктуры
новые дома
капремонт центра образования 23 в богородском горо
мелитополь
пэмз
капремонт центра образования 29 в богородском окр
Взрыв в школе
вск университет
Экомилк
буревестник
сергиево-посадский колледж
николай гришин
Новый кабинет флюорографии
Новый аппарат флюорографии в Зарайске
Музей советского детства
Спокойной ночи малыши
Степашка и хрюша
спартакиада теннис
чемпионат Профессионалы-2025
студент филиала авиационного техникума в раменско
капремонт детского сада 35 в богородском округе
Молодежный клуб
Бронницкая казачья сотня
Фестиваль Люди как люди
Синий
Ксцор домодедовский
сергиево-посадский музейный комплекс
человек года 2025
семен жильцов
Программа 100 прудов и озер
пожар в МКД
Власиха ЧП
мисс весна
Уборка неликвидной древесины
Бронницкое лесничество
музыкальное образование
тушение
семен янин
моют улицы
северный микрорайон
родные
спортивный комплекс Надежды России
здоровое питание спортсменов
училища олимпийского резерва
кулинарный поединок
призеры и чемпионы олимпиад
национальная кухня стран БРИКС
улица тельнова
патриотический урок
кофейная кантата
вазоны
Лучший по професссии
Общестао
Газпром Вниигаз
травмотология
Комната матери и ребенка
газонокосилка
начни свой бизнес
Неделя здоровья матери и ребенка
ВсОШ
Система Честный знак
никто кроме нас
спортивный стадион полет
президентская награда
Арт-макет
Соревнования по стрельбе
утренняя зарядка в парке
рентгенохирургическая система С-дуга
день здоровья в раменском парке
мобильный центр здоровья
диспансеризация жителей
горение травы
Чемпионат по программированию
на улице мира прокладывают ливневую канализацию
поселок Васькино
деревня Васькино
улица Восточная
новая улица наро-фоминска
автомобильный мост
новый микрорайон города
Переврнутый дом
Реставрация трактора
У-2 ВТЗ
маскировочные сво
тросовые ограждения
реконструкция моста в деревне Поречье
ремонт моста в Рузе
ремонт крыш многоквартирных домов
дом для переселенцев в Талдоме
усадьба сенницы
верховая езда
конно-спортивный клуб
аптечный пункт
капремонт детского сада аленка в талдоме
сдача макулатуры
Техобслуживание Вечного огня
неонатолог
день неонатолога
Дети с РАС
деревянные настилы
диктант жкх
Гимназия 2 Щелково
ремонт коммуникаций
Нападение медведя
летний отдых детей
дети участников СВО
аграрно-промышленный техникум
детская литература
конкурс для жителей
мемориал вечный огонь
поликлиника Минобороны
Власихи медицина
современное исксусство
УДТ-Техника
экскаваторы
Раменский приборостроительный завод
веди родителей в музей
урок добра
аутисты
Всемирный день распространения информации о пробл
викторина покорители космоса
центральная библиотека лыткарино
лытккарино
историческая викторина
ученики против учителей
турнир по водному поло
Культуоа
Выставки Подмосковья
улица Победы 16
необычные фигуры
Владимир Журбас
Светлана Журбас
Эко-тропа
комплексное благоустройство дворов в кратово
поселок кратово улица мичурина
монтажники
лихачевское шоссе
ЧП на улице Аллейная
блохинка
день гарри поттера
снег весной
мособлэксплуатация
Школа вожатых
мастер-шоу
строительство путепровода
врач ЛФК
Александр Гиндин
Сельскохозяйственная техника
Выставка сельхозтехники
День еосмонавтики
альберт тинис
яркарка вакансий
открытие охотничьего сезона
стендовая стрельба
кубок балашихи по армрестлингу
очистка дорог от снега
Красногорск-открой и запомни
новая игра
школа 15 Красногорск
всероссийское первенство по бадминтону среди юни
Выставка сельскохозяйственной техники
Уникальная машина для опрыскивания
Фестиваль будущих мам
день беременных
кубок драйва
танцевальный турнир
Россия-Китай
Китайский автопром
Китай авто
зион
Доступное жилье
циклон зион
лодки
фрегат
талантливый педагог
Строительство автовокзала
открытие магазина
снег в апреле
юниорпрофи крэт умные каникулы
самоходный опрыскиватель
оранжерея пальм
Павильон проката
мопц
Полиция глазами детей
Новая экспозиция
электромонтаж
Щелковский колледж
Чемпионат по сборке двигателей
роды двойни
гусары
золушка
школьники подмосковья
Мария Барсученко
Станция Бронницы
Ремонт железнодорожных путей
городская медиашкола
История одного мемориала
поликлиника в котельниках
школа и детский сад в котельниках
строительство в котельниках
строительство производственного предприятия в мож
строительство съездов
дорог и
боковые съезды
меры поддержки бизнеса
день здорового ребенка
конкурс юных конструкторов
онкоскрининг полости рта
поликлиника в Дрожжино
работа во власихе
власиха ищу работу
Водители Бронниц
заслуженный работник образования
годовщина образования военного комиссариата
дошкольное отделение гимназии1
детский сад в волоколамске
поликлиника в боброво
дошкольное отделение 21
обучение детей с расстройством аутистического спе
Школа на Московской
Новая школа в Зарайске
турист
поисковый отряд вымпел
судьба солдата
небо родины
безымянный солдат
волоколамская больница
строительство осташевского отделения
медицина волоколамска
пехорка
браслеты жизни
предприятие по производству безалкогольных напитк
бочкари
авицация
портетка
фап в ботово
Музей детский народный календарь
апрельский снег
уборка снега власиха
сбор электротехники
уникальные экспонаты
школа-конференция
новый врач в стоматологической поликлинике
хотьковский соловей
конкурс вокалистов
дом зайца
дикие животные
георгий кольцов
функциональная диагностика
Школа искусств Зарайск
укулеле
укулеле для дошкольников
обучение игре на укулеле
библиотека оияи
саногенное мышление
отари аршба
петровакс фарм
Коммунальные службы Бронниц
купеческий дом
сход снега
апрельский снегопад
стеклопакеты
Завод Сектор
Готовые обеды
эстафеты
единая диспетчерская служба
операторы скорой помощи
операторы службы спасения
Трасса А-104
Росавтодор
Хлыновские дачи
Загородный отдых
потолки
Эстакада в Красногорске
год культуры китая
маджонг
китайский маджонг
тяжелая травма
нпк региональный этап
школьный этап нпк
фриволите
арена пехорка
площадь космонавтов в дубне
школа 1 в дубне
капремонт школы в дубне
центр подготовки космонавтов
фарфоровый завод в талдоме
производство фарфора
благоустройство талдома
фап в селе спасс
медицина в волоколамске
ракета победы
фок лидер в волоколамске
хоккей в волоколамске
капремонт детского сада в рузе
детский сад в Колюбакино
расширение трассы м-1
строительные работы на м-1
замена балконной плиты
завод в рузе
завод железобетонных конструкций
Объездная дорога в Тучково
установка стелы в рузе
стела на центральной площади рузы
малая планета
Чуйковия
хирурги прооперировали пожилую пациентку со сложн
первый дачный автобусный маршрут
Пожар в Заворово
Ночной пожар в Раменском округе
усадьба за рубль
Любановская усадьба
комплексный центр можайский
песочная терапия
современные методы терапии
интерактивная песочница
Рисование песком на световых столах
новая жизнь
реставрация мебели
замена лифта
Новые лифты на Оптическом переулке
новые лифты в Красногорске
молодежный конкурс
бульвар космонавтов
тренер по плаванью
Унихимтек
МС-21
композиты
центр социальной реабилитации
Патриотическое воспитание детей
конференция власиха
оценка качества медицины
куаркоды
гис жкх
онлайн ОСС
цветотерапия
Индустриальный парк Орудьево
плавание власиха
открытое первенство плавание
стела воинской доблести
люди космоса
балково
новый передвижной диагностический комплекс
межрегиональный семинар
Строительство КДЦ
юношеский турнир по греко-римской борьбе в спортк
поэты ВОВ
библиотека тютчева
библиохолл
обмен
день космоса
50 лет музыкалке
гагаринцы
гагаринские чтения
Медвежьи озера
неделя экологических знаний
никольское кладбище
ремонт школы искусств
закалка
оружие и предметы ВОВ
бионическая кисть
Познавательная игра для детей
Биннофарм
формацевтическая компания в красногорске
создание лекарств
походы
детские походы
Мелодии вместо звонков
газпром спка
Награждение сотрудников
Производство космических аппаратов
областной медицинский колледж в раменском
практика студентов в стоматологической поликлиник
власиха елецкий
малолетний узник
концлагерь
центр лепсе
памятник Дорохову
реставрация памятника
юные гении
распознавание лиц
изообретариум
поиск людей
сбор гуманитарки
Вышивка бисером
Открытый Чемпионат России по тяжелой атлетике
узники фашистских лагерей
бывшие узники концлагерей
сош 2 шатура
бах
космический досуг
фонд защита
Работа в Зарайске
браво
наш успех
Морево
день труда власиха
торжественное день труда
патриотическое кино
фильм записка
фильм 346
узник
детский сад на молодежной
благоустройства сквера в лыткарине
сквер им А И Чернышва
гимназия 4 в лыткарине
очистные в лыткарине
экология лыткарино
ремонт стадиона в лыткарине
улыбка гагарина
волонтры победы
Мисс муниципального округа Луховицы 2025
Школьный спутник
Лавочкина
промтех-дубна
Квест-выставка
опыт
концерт педагогов
Центральный парк Щелково
Химическое шоу
Юбилей отряда
Музей ВВС в Монино
спортсмен-колясочник
дом кувльтуры
кц елизавета мамонтова
выставка ангел дома
ветеранские коллективы
и нисколько мы с тобой не постарели
Школьная обсерватория
творчество без возраста
мелочь
монетная неделя
Варяг
городской суд
централизованная библиотечная система
трактир
харчевня
константин филимонов
филиал авиационного техникума в раменском
день открытых дверей в техникуме
Поселок Буденновец
сад-новостройка
сезон клещей
Энцефалит
репеллент
Украшение автобуса к 9 мая
власиха спорт
секция футбола
Габовская лыжня
инспекция объектов
проверка объектов
линзовые объективы
vr-кабинки
МедиаМол
культура и туризм Подмосковья
дошколята в музее
дни науки
ддт лыткарино
хоровой фестиваль имени струве
хоровой конкурс-фестиваль
Дороги Зарайска
приют для бездомных животных
светлана астахова
улица Мира 9а
спортивная форма
атрибутика
аксессуары
автографы
чемпионы олимпийских игр
клуб Чеховские медведи
Александр Черноиванов
7Я
телемедицинская консультация
соцподдержка
арт терапия
пор де бра
комбинат благоустройства и ЖКХ
мойка пешеходных переходов
Село Заворово
Реконструкция мемориала
Мемориал воинской славы
убрали дерево
переселенцы из аварийного фонда
новостройки
фрезерование дороги
скрининг
студент-победитель чемпионата абилимпикс
кирилловка
армейский рукопашный бой
секция по рукопашному бою
вербный ангел
детские игрушки
Трактор Универсал-2
Реставрация памятника технике
Летние смены
Капремонт лагеря
Подготовка лагеря к лету
курс
Клуб Максима Парк
Кубок Кремля по конкуру
Федерация конного спорта
редкое заболевание
Детский оздоровительный лагерь
школьные отряды спасателей
Одинцовская епархия
места памяти
Мастерская Валерия Гришанова
ветеран великой отечественной войны
капремонт фундамента
капитальный ремонт цоколя
Путепровод в Сабурово
Дублер Пятницкого шоссе
Открытие выставки ВОВ
Благоустройство Часцы
день экологических знаний
Преподаватель музыки
Скрипач
Детский педагог
Фабрика Гарднер
международное сотрудничество
внешние коммуникации
Федерация дзюдо России
Мой первый пояс
всероссийский этап соревнований
пожароопасный сезон 2025
Льготы многодетным семьям
очистка проездов
центр химкинский
реабилитация детей
хаски из белгорода
гумпомощь бойцам
рецепт кулича
Руны
Скандинавская культура
Скандинавия
трудовой подвиг шатуры
врачи-урологи
на улице чехова и улице кооперативной заасфальтир
Пасха в Звенигороде
Подарок бойцам
деревня тимоново
музей куклы и игрушки
Новый ПНД
политзавод
экология шатуры
хореографический коллектив
лига армейского рукопашного боя
переработка батареек
противогаз
выгул собак
урны для уборки
питомец
праздничное оформление
разлив воды
дренажная система
строительсво
постановка на воинский учт
следственный комитет по рвсн
волонтеры лыткарино
Центр переливания крови
Памятник бойцам СВО
Автомобиль для Зарайский бойцов
Помощь на СВО
военные оркестры
центр созвездие
Ремонт часовни
Часланя Николая Чудотворца в Бронницах
Ремонт крыши часовни
кпитальный ремонт
тротуары по программе народные тропы
улица космонавтов
последствия атаки беспилотников
Герои Красногорск
премия парки россии
муниципальный этап зарницы 2 0
сеть водоснабжения
лыткарино 8 школа
Капитаны образования кадровый резерв Подмосковья
советник-методист
логинова полина
совы
Неясыть
Бронницкая казачья молодежная сотня
плац-концерт
всероссийский фестиваль
второй этап
коррекционные классы
нечаевцы
первые молодогвардейцы подмосковья
Почетный гражданин Дмитровского округа
Анатолий Хомич
Дом доброты
стихов победных звон
Спасский мост
съемка
Обработка парка от клещей
украшение куличей
антиклещевая обработка
Спасательный центр МЧС
3д-моделирование
Поджоги травы
президентские спортивные игры
восстановление благоустройства территории после р
тематическая ярмарка
образование в королеве
Люди Одинцовского округа
илья погребняк
mad wave classic
полимеханика и автоматизация
Канализационные сети
центр отбразования
ярослав дронов
открытый урок музыки
нацизм
познавательный урок
трудоквест
готовность к лету
сафари-парк в можайске
туризм можайска
эко-отель подмосковья
эко-отель под можайском
Субботники Звенигород
игумново
переезд врачей
перенос приема
новый адрес
улица Пионерская 4
поликлиника в микрорайоне Венюково
сквер на улице Побратимов
артист Леонид Серебренников
капитальный ремонт дк
цдк имени нариманова
кедр
яблоня
ОКБКП
александр савушкин
гто в можайске
памятник в можайске
чп власиха
дтп власиха
власиха спортивный
власиха авария
авария власиха
Лекция о здоровье
Каширский переулок 59
новые тротуары
памятник вов в деревне васильевское
штукатурка по маячкам
Жилье и городская средаt
мистер и мисс университет 2025
Детская библиотека Звенигорода
Лицей 5
бмк мочилы
Зацвели первые нарциссы
новый милет
кончура
Власиха фонари
Клинический центр Рошаля
кедры россии
улица красноармейская
Алексей Пьяница
мы за чистоту
депутат Госдумы РФ
реконструкция музея
сбор макулатуры в поддержку российских военных
раменская средняя школа 1
карбокситерапия
поворотное кресло
излучатель
лаборант-рентгенолог
Спецопперация
заведение общепита
строительство в шатуре
впр
всероссийские проверочные работы
забота о памятниках
спецоперации
улица Литейная
компания Орбита
торговая марка Royal Mubarak
продукты здорового питания
орехи и сухофрукты
освящение яиц
праздничные богослужения
Дом офицеров монино
Юбилей дома офицеров
Образцовый коллектив
остановись и гордись
студенты городу
Участник СВО детям
ретро
пасхальные зайцы
сбор пожертвований
парк константиновский
Розы Зарайска
Благоустройство улиц
Благоустройство Зарайска
Изменение расписания
подарки в зону сво
гуманитарная помощь сво
гуманитарная помощь к пасхе
страстная суббота
Люберецы
Преображенский собор в Люберцах
благочинный церквей Люберецкого округа иерей Вяч
куличи для бойцов
пасха христова
пасхальная палитра
поздравление бойцов
Пасхальная ярмарка
плащаница Иисуса Христа
автодром
георгиевская церковь
освящение пасхальных явств в храме в загорново
пасха 2025
фонд друзей коломны
праздничные приготовления в храме в загорново
библиотека компас
власиха дети
атлет
Троицкий собор в Яхроме
арт
Освещение куличей
гравировка
ферма цветковых
вечернее богослужение
Конкурс пасхальное яйцо
андрей мардасов
тимофей лагутин
Москворецкий гребной марафон
власиха храм
Успенский собор в Дмитрове
чайки
воспоминания ветеранов
реконсипукция мемориала
Москва-река-2025
площадь партизан
капитальный ремонт трассы
стела трудовой доблести
Парк березки
квест профессий
конная школа
трандиции
всероссийский проект
83-я годовщина битвы под Москвой
митинг на площади Тимофеева
пасхальный концерт
журавли памяти
выставка в парке
Субботник на воде
ремонт дворов
Мемориал воинам погибшим в войнах и локальных кон
Стаирс Профи
Стремянки и лестницы
Мангалы
мкд шатура
пост скорой медицинской помощи
встреча с бойцами
экскурсии по ферме
заборы
живой карандаш
зеленая школа
Юрий Поэта
проходы
новая поликлиника в Глухово
Гранель строит
строительство в Бронницах
полиция власиха
профриентация
экологические игры 2025
экомобиль
сквер поколений
аппарат для кормления уток
mr mattress
социальный центр шатурский
сбор пластика
переработка отходов
автопробе
Музпросвет
брендирование
городской шрифт
дтп а-107
дтп Раменский округ
дтп Нестерово
дтп с возгоранием авто
Проект Дмитров Дом
Группа Самолет
дороги победы
подготовка к 9 мая
Vместе zа наших
пожар в Красногорске
пожар в Изумрудных холмах
новая котельная в Глухово
строительство в Глухово
уборка площади имени Тимофеева
новый рентген аппарат
80-летие великой победы
Бог
кабинет льготных рецептов
кабинет прикрепления
кабинет вакцинации
вокальное искусство
Мариам Мерабова
Дачный сезон
дом совы
день рождения Ленина
красновские выселки
Кашира-Серебряные Пруды-Узловая
разделительная полоса
28км Волоколамское шоссе
чистый берег
власиха озеро
детский сад в домодедове
годовщина со дня рождения Ленина
первый памятник Ленину
новая разметка
больница в домодедове
спорт в домодедове
образование в домодедове
ту-144
завод МолоПак
картонная упаковка
изготовление
пищевая промышленность
аналог Тетра Пак
аналог Пюр-Пак
форматы и виды упаковки
сирень победы
высадка саженцев
производительность предприятия
асептическая упаковка
упаковка из картона
упаковка для молочных продуктов соков и воды
структура предприятия
история завода
школ искусств в Растуново
школа искусств домодедово
гигантские овощи
демонтаж здания
Дорстрой-12
Недропользование
Горнодобывающее оборудование
Туристические узлы
водные прогулки
студентам показали коммунальную технику
мемориал аллея памяти
Консалтинговый центр
Колбаса
Фестиваль Истра
Понихайкинг
Свободная ипповенция
Деревня Глебово
пешком в подмосковье
тротуар в поселке совхоза раменское
Их осталось мало
Поздравили ветерана
супергонка GT Cup
автодром Moscow Raceway
кабельный завод в воскресенске
оптоволоконный завод
выставка в туристско-информационном центре
старосты серебряных прудов
городской округ дмитровский
покраска бордюров
новое пищевое производство
торговая марка Роял Мубарак
каркас здания
земля за 1 рубль
Глуховская библиотека
каретный двор
тропинки и дорожки
металлический каркас
доски из сосны
ледовый дворец воскресенск
спорт в воскресенске
власиха диктант победы
Усадьба Обольяниновых
Минимущества
автопросвещение
смотр парковой техники
мемориал вов
регистрация животных
баннер
герои шатуры
военные подвиги
плетение маскировочных сетей
мастер-класс по плетению маскировочных сетей
Спортивный клуб Витязь
Жители мкд
школа 25
игра на ложках
турнир дмитрия двали
ледовый дворец балашиха
улмца баранова
герои среди нас
учения в Красногорске
учения спецслужб
ученик года 2025
больница хотьково
кдц хотьково
игра мафия
медицина сергиев посад
Самбо в школу
мемориал славы сергиев посад
РТА
реконструкция храма в сергиевом посаде
снос торгового объекта
музей истории шатурской грэс
капремонт детского сада в мытищах
пристройка к школе 12
школа в мытищах
городской этап
детский сад в мытищах
строительство детского сада в шолохово
конкурс пасхальная радость
детский сад в мкр 20
ЖК Ярославский квартал
ЖК Новое Медведково
жк ярославский
строительство поликлиники в мытищи парк
школа в мытищи парк
строительство школы в мытищах
мурал на бельском
возведение каркаса
Черновые работы
театр зазеркалье наро-фоминск
юбилей музея
уборка к 9 мая
итоги 2024 года
отчет перед населением
покраска остановок
рочль
уборка мемориалов
незаконные торговые точки
обелиск воинской славы в малышево
экопарк губайлово
детский парк в наро-фоминске
мемориал павшим
строительство мдк
комплексное благоустройство дворов многоквартирны
мичурина-чурилина
снос зданий
обработка против клещей
Мелки
именные таблички
партизаны
смерть фашизму
новый комплекс
производство картонной упаковки
дополнительные налоги
значки ГТО
алабушево
музей крылатых ракет
палеонтология
Зоя Космодемьянская
весенне-летний сезон
зоны ответственности
Демонтаж торгового павильона
Торговый павильон
ЩелковоХлеб
завод аравия в протвине
производство косметической продукции
серебрыне пруды
посевная 2025
спк деметра
парк сказка протвино
благоустройство парка сказка
Школа 24
Дом-Школа-Дом
выставка к 80-летию Победы
ополченцы
наука и технологии
Встреча с ветеранами СВО
импровизация
капустник
школа импро
салют пасхальной радости
день пожарной безопасности в раменском
кашира-8
орнаменталика
патриарх сербский
петрушка на войне
вопросы о войне
петрушка
московский театр кукол
выездное чипирование
выездная вакцинация
Парк Экстрим
школа 26
фанфары победы
Плакатная графика
общероссийский субботник
Урашение города
всероссийский субботник в бронницах
бэтмен
чистые игры
сад памяти
Посадка кедров
26 апреля
Субботник в Зарайске
создание эко-кормушек
весенний суббботник
весенний забег
голосование за объекты благоустройства 2026
субботник в серебряных прудах
общнобластное голосование
экоточка
репинские пруды
места боевой славы четвртой Московской стрелковой
Чкаловское озеро
сибирское здоровье
декоративная подсыпка дорожек
субботник власиха
ДвижениеПервыхЗарайск
ПоходПервых
ВремяОткрытий
Дети Подмосковья
Экологический десант
парковая атлетика
студенты раменского колледжа победили в межрегио
набережная озера
Высадка сосен
Кладбище
эко марафон
Акция Мы за чистоту
субботник в Красногорске
дорога к лавре
акция диктант победы 2025
спасибо за победу
табличка на доме в честь ветерана
богородское
фок лотос
канал для гребного слалома
забег победы
соревнования по бегу
хронотоп
чеканка монет
раменские хирурги прооперировали пациента с ущемл
Арт пространство восход
Фонд защита Балашиха
информационная табличка
сергей андрияки
Мособлизберком
макеевка
подари ребенку книгу
синий платочек
виола
Почетный житель Дмитрова
Дом доброты в Дмитрове
Таблички в честь ветеранов ВОВ
рак толстой кишки
цветение
техническое состояние
аллея славы раменской больницы
радиостанция
центр романтик
спасение на воде
конкурс под крылом поэзии
кирсанов
Центр Фавор в Дмитрове
инженерно-технический корпус
слаботочная сеть
системы связи и безопасности
охранно-пожарная сигнализация
эко-туризм
По следам героев
термопластик разметка
власиха нанесение разметки
пристройка к школе 10 в Мытищах
производство полимеров
ремонт школы 6 серпухов
школы в серпухове
общественное голосование
ремонт детского сада серпухов
рекорд победы
Памятная табличка
новая школа на улице Мира
искуственный интеллект
Орехово-Зуевский лицей
ремонт школы 17 в Серпухове
учители
московский компас
новая школа в мытищах
подольский краеведческий музей
ветераны Вооруженных сил РФ
сервис
дерматология
врач-дерматолог
венеролог
стихи о родине
юный разведчик
кабинет рентгенографии
Мисс Одинцово
послание потомкам
знаменские барабанщики
победа на музыкальном конкурсе
знаменские барабанщики едут в артек
красноармейская
памятник-самолет
ансамбль танца радость
конкурс инсценировок
6-я школа
Международный день танца
детский квиз
бар филин
малахит
завод малахит
аналоги тетра пак и пюр-пак
российское сырье
отечественные материалы и технологии
локализация производства
новые комплексы
фонд развития промышленности
тренировочная эвакуация в средней школе 22 в дубо
Адам Булгучев
Лаврентий Берия
чернильное царство
вакансии в шатуре
работа в шатуре
ко дню победы
школьная перестрелка
забота о сотрудниках
Стела населенный пункт воинской доблести
Политехнический колледж
Дропперы
Памятные таблички участникам ВОВ
Ветераны ВОВ Краснознаменска
обряд
дефиле-спорт
ремонт дороги в серпухове
новый бассейн
ихимена остануться в веках
м-2 крым
ученическое самоуправление
президент школы
росдетцентр
власиха илья муромец
лучший молодой специалист
педагогический олимп
герои отечества-связь поколений
Усадьба Плещеево
Папа мама я
пожарная техника
мост Подольских курсантов
ремонт моста в серпухове
театральная завалинка
Скетч-рисование
Именная табличка
Ремонта моста
пригородные поезда
изменения в графике работы
расписание выходного дня
героизм
горящее поле
молодежь против нацизма
артур орлов
владислав головин
Эхо Победы
сточные воды
духовые инструменты
военная медицина
пожарная часть Красногорск
благотворительные фонды
Зарайская баранка
Музей зарайской баранки
садовый сезон
садовые цветы
молодежный центр наро-фоминска
зарядка героя
очистка дна
юные ученые
Зкология
тренировочная эвакуация в раменском колледже
новая развязка
город воинской доблести
стриж-7
открытие переправы
Музей Победы Красногорск
Программа Музея Победы
музыка ком
PRO Женщин
праздник победы
украшения города
Московска область
Новый фонтан
Пушкинский городской округ
танцы скелетов в шкафу
цифровая гигиена
праздник весны и труда
всероссийское голосование за объекты благоустройс
сквер у дк орбита
Ретро-дефиле
сквер Долгова
долгопрудненцы герои
Аттракцион
Шухов
аллея приборостроителей
измельчение веток
компания СрубСтрой
благотворительная точка добра Манаим
пункт варварушки
под крышей
поющее подмосковье
манглал
80 лет
врач-терапевт
шатурское патп
летние маршруты автобусов
летние автобусные маршруты
воображение
клоун
акриловые краски
Талицы
скандинавский циклон
задержки
карла маркса
майский снег
Североатлантический циклон
молельная комната
деньфизтеха
бизнес-лекторий
Сбой расписания работы поездов
упало
капитальный ремонт школы в Белоомуте
юниоры и юниорки
разные весовые категории
17-18 лет
Александр Поветкин
карьер волкуша
акватория волкуши
обследование дна
подводный дрон
Богтродский городской округ
Павел Штыренко
символ Победы
братья Чудиновы
зам главы округа Виталий Шишкин
Устранение последствий снегопада
Матрона московская
семен золотарев
коза
клуб winterlion
тематические плакаты
праздничные баннеры
транспаранты
акция Георгиевская ленточка
Дизель-генератор
ярославское направление
Линии электропередач
Генератор
деревня дубки
музей колокольного искусства
поисковый отряд пересвет
плацдарм
Деревня Гришино
Поселок Луговой
Село Рогачево
Поселок Раменское
Психиатрическая больница 5
Засыпало снегом
Россеть
Табличка ветерану
ураган в Талдоме
снегопал в Талдоме
ЧС в Талдоме
Болотоход
ликвидация последствий стихии
талдом чс
мастер-класс по плетению браслетов выживания
офтальмолог
офтальмологический кабинет
схемы мошенников
ликвидация последствий урагана
непогода в Талдоме
ветер в Талдоме
падение деревьев в Талдоме
белые вороны
фабрика 1830
мастер-класс по медицине
наследники победы
аварийная машина
засоры
аккумулятор
Троссовое ограждение
ВахтаПамяти
АллеяСлавы
ПомнимГордимся
мемориал скорбящая мать
Оживший кадр
проекционная разметка
танцевальный флешмоб
Аллея многодетных мам
Аллея многодетных семей
николай чудотворец
Власиха Жуков
памятник Жукову власиха
красные утки
деревня Сергеево
производственно-складской комплекс
завод ПолимерИзделия
развитие округа
изделия из полимерных материалов
Снаряд
снт метролог
марш победы
ДК Дружба
обелиск воинской славы
чиновники
заместитель главы округа Ольга Щукина
акция Вахта Памяти
таблички ветеранам
Дошкольное дзюдо
дети-детям
КолоколаПамяти
80летПобеды
ЛуховицыПомнит
НаследникиПобеды
спортивный забег
80-я годовщина победы
береговая зона озера пионер
власиха 80 лет победе
проект стена памяти
новый детский сад в жк Малина
Черемуха
Афиша мероприятий Звенигород
лыткаринский планетарий
летчик покрышкин
покрышкин формула победы
турник
бал победителей
МГАФК
мемориал защитникам отечества
знамя памяти
Падение беспилотника
елена кабардина
коммунистическая 36-39
ремонт памятника
воинское захоронение
капитальный ремонт воинского захоронения
майский вальс
ремонт Павшинского моста
Павшинский мост
робокафе
Движение транспорта
виноградов
своя в доску
кондитеры Зарайска
кондитерский цех в зарайске
Зарайские торты
памятная
экономика Зарайск
сквер боевой славы
автопробег победы
внутренняя отделка
сереборяные пруды
школа в селе подхожее
иванов иван петрович
подвиг сусанина
весенний сезон сбора грибов
Ногинское лесничество
Лес памяти
Эколого-патриотическая акция
я помню я горжусь
верните память
никто не забыт ничто не забыто
рвсн власиха
Мемориал воинам хлопчатобумажного комбината
акция сад памяти
Пыльца березы
Полиноз
Выставка работ ветеранов
Завод Тензор
Прокурор Дубны
Кибермошенники
фк родина
Луховицы 80летПобеды ЭстафетаПобеды Спорт Патриоти
плац-парад рвсн
возложение цветов к обелиску герою великой отечес
мероприятие на территории кратовской школы 98
ваи
власиха бессмертный полк
бессмертный полк онлайн
служба качества
отдел технического контроля
тесты
проверки
многоэтапная система
качество продукции
сырье и материалы
процессы производства
хранение и отгрузка
ОЭЗ
сценка
радиолинейка
музей военной техники
флаг РФ
поклонимся великим тем годам
фтс
федеральная таможенная служба
СадПамяти2024
ЖиваяПамять
ВолонтерыМО
НаследиеПобеды
Эстафета по плаванию
мемориал в кузовлево
памятные таблчки ветеранам ВОВ
Места памяти Великой Отечественной войны
Патриотичнские акции
конкурс дн
посадка елей
газета правда
Читаем письма с фронта
Мероприятия ко Дню Победы
мемориал Героям-панфиловцам
Обелиск славы в домодедове
памятник штурмовику ИЛ-2
Всероссийское общество знание
мемориальный парк коломны
памятник героям ВОВ в серпухове
Вечный огонь в королеве
Клара Богатова
загорск
клементьевская
тучковский политех
Стела генералу Кузнецову
Участковый терапевт
песенный флешмоб
т-34
макет танка
ДК Саввино
украсили город к 9 мая
Подготовка к мероприятиям
Табличка ветерана
стропила и перекрытия
каркас кровли
очистные в пущине
военные врачи
военный хирург
госпиталь одинцово
Юлион
посадить дерево
новый сад в Опалихе
выставка масштабных моделей
капремонт школы 1 в серпухове
Игра Победа
военный госпиталь одинцово
капремонт школы 2 в серпухове
китайские студенты
песня катюша
капремонт школы 9 в серпухове
частный музей меуса
выставка о вов
площадь пухова
бессмертный автополк
венок
василий теркин
Хор девочек Алые паруса
хор девочек
музыкальная школа Алые паруса
митинг к 9 мая
лыткарино гимназия 7
лыткарино школа 2
дом культуры выстрел
второй этап реконструкции площади победы
митинг ко дню победы
моу гимназия 1
перекрытие движения
михаил зорин
Модернизация канализации
стрелковое многоборье
трофеи сво
Победа в лицах
веревочный парк
norway park
чемпионат мира по тяжелой атлетике
частный сектор
Русские сезоны пересвет
митинги к 9 мая
моу гимназия 7 лыткарино
80 дет победы
рыночный комплекс в бронницах
мост в серпухове
центр обслуживания грузового транспорта в Бронни
художник-фронтовик
спасибо
ветеран вов бронницы
ветеран вов Валентина Копосова
Мемориальный ансамбль
дк космос
возложение венков
торжественная церемония
велопробег памяти
прямая трансляция парада
день победы в бронницах
баянист в автобусе
георгий фоменко
Братская могила в деревне Василево
Сергей Поляков
котельная в пущине
парк победы пущино
центр культурного развития вертикаль
День Победы в Наро-Фоминске
полевой госпиталь
парк питомник в серпухове
раздача еды
возложение цветов к мемориалу в сафоново
гвоздики
9 мая в бронницах
боевая техника
прадеды
фоменко василий
власиха почетный гражданин
мемориал воина Великой Отечественной войны
мемориал героям Великой Отечественной войны
Ярмарка мастериц
онлайн акция
возложение цветов в день победы
шатурская гибдд
возложение цветов к мемориалу в деревне поповка
семен золотарев власиха
власиха герой ссср
Полевая почта
ДеньПобеды
фронтовая бригада
узник фашизма
Мастер-классы для детей
победный май
великая отечественная
день победы 2025
рукопашный армейский бой
показательное выступление
Бесплатная экскурсия
Советские летчики
Театрализованный спектакль
Выставка ко дню победы
Подвиг летчиков
возложение цветов к памятнику в деревне старково
Праздник во дворе
Союз помощи многодетным и приемным семьям Мы
мемориальные доски
бой на мечах
белые медведи
знамя победы Долгопрудного
группа пятеро
бал ветеранов
треугольники надежды
Виктория Цыганова
лесной бульвар в протвине
поликлиника в королеве
медицина в королеве
пешеходная зона на улице Ленина в Протвине
озеленение улицы в протвине
благоустройство пешеходных дорожек в протвине
насос
деревня салтыково
конный клуб салтыково
лодочная станция балашиха
семхоз
Здехово
Обновление остановок
Выставка творческих работ
Автобан
Гимназия имени подольских курсантов
врач-аллерголог
Власиха улица солнечная
октябрьская 6
перезахоронение красноармейцев
Квест-марафон
власиха уборка дорог
коммунальные службы власихи
ретро-гараж
жильцов
шериф-балка
мигалка
чистый двор
мелодии
гудки
логотип 80-летия Победы
скачать
Сухая гребля
Кросфит
гибдд власиха
дети на дороге
ЖК Люберецкий
бульвар левашова
Зуша
соревнования школа безопасности
скоростная трасса
освоение луны
кейс-чемпионат
Русская классика
статуя
Люберецкий завод Монтажавтоматика
целевой договор
Монтаж и эксплуатация газового оборудования.
газопровод
детская школа искусств бронницы
Прликлиника
замена хвс
магистральный трубопровод
власиха замена сетей
цветение сосны
пыльцы
Чипирование животных
власиха теплоэнергетика
бтп
установка бтп
Элекстрасталь
Победители всош
Дети герои вов
гипертония
плодородный грунт
Снос аварийного жилья
Пролетарский проспект
код донора
песцы
выставка животных
Телефонное мошенничество
ветврач
ниипа
детский хор
улица калинина в поселке кратово
парк аттракционов
каталог
альманах
80-лет Победы
элестросталь
Подолы
русский рок
жк белый город
вишня
автомобиль ветерану
фонд защитников отечества
ночь музеев в бронницах
шатурская секция гребли
софтлайн
выставка декоративно-прикладного искусства
котельные бронниц
отключение отопления на лето
молодой промышленник
прокладка сетей
кондиционирование
Старая руза
День рождения ветерана вов
бульвар кузнецова
Паралимпийский спорт
Парафест
Поиск нарушителей
асфальтирование дворов
Деаэрационная установка
коррозия
Школа рядом с домом
Лауреаты премии
Мобильный Сбер
капремонт спорткомлекса в Шаховской
зал единоборств в шаховской
трасса М-9 Балтия
прикладная акустика
выставка продукции
выставка рукоделия
тропинки и тротуары
Победа будет Zа нами
посев ярового рапса
Агрокомплекс в шаховском
анималистическая выставка в дк сатурн
права человека
подмосковье 2025
железня
площадь у спорткомплекса старт
соревнования на кубок городского округа Бронницы
Городская поликлиника
выездная администрация Люберцы
безопасное колесо балашиха
парк гжель
ук наш дом
система
парк водно-болотных птиц
туризм подмосковья
поселок птицефабрика
газдевайс
промэкскурсия
евгений фадин
мурал прапорщику евгению фадину
правовое просвещение
космические пещеры
робот-спелеолог
торфяники
посевная в шаховской
посев кукурузы
выездная регистрация брака в Бронницах
семейный парад
Плещеево
день открытых дверей в раменском дорожно-строител
студент раменского дорожно-строительного техникум
участники
мотофристайл-шоу
команда fmx13
кванториум в королеве
космороботс
город танцет
дк авиатор
танцевальный ансамбль вдохновение
владычная слобода
Вечер в усадьбе
Усадьба Фряново
СноваМолодой
ДекоративныеРастения
ПосадочныйМатериал
ЛандшафтныйДизайн
ТепличноеХозяйство
СемейноеПредприятие
лучники
роман лобанов
домашний матч
военно-патриотический квест
программа импортозамещения
отечественное сырье
российские станки
емкости ванны фильтры
пластиковые изделия
новая купавна
природа подмосковья
ОрлятаРоссии
ДетскоеДвижение
ПатриотическоеВоспитание
ЮныеЛидеры
ГодЗащитникаОтечества
ДетскиеОрганизации
БудущееРоссии
НашиДети
СлаваГероям
ПоколениеПобедителей
строительство нового корпуса лицея
Ретротранспорт
общетво
клин общество
препятствия
кимры
моделизм
день детских общественных организаций
Юные гагаринцы
Руза чудесная
Музей мебельной фабрики
День пионерии
Ремонт асфальта
поисковый отряд русь
театр на площади
сергей суворов
ганди молчал по субботам
переходный возраст
дорожки на сваях
укладка настилов
музей фабрики мебели
Наукоградусно
Павел Федосов
интерактивность
История мироздания
Динозавры
чемпионат россии по кикбоксингу
федерация кикбоксинга
фрезерная машина
гудрон
Котята
вхл
кубок чемпиона россии
МорскиеКадеты
ВоенноМорскиеТрадиции
овсень
анастасия новакова
КраснаяПойма
РемонтДорог
ДорожныеРаботы
ГородскаяСреда
музей частных коллекций
Люберецкая областная больница
остеосинтез
лагерь вали котика
подвиги детей
кондитерское производство
финики с миндалем в глазури
вкус карамели
белый молочный темный шоколад
турнир по баскетболу среди юношей
new style
корпус сил и средств стран снг
власиха гумконвой
Новая пешеходная дорожка
модуль
стопа
Полипластик
Трубный завод
Новая плитка
центр поддержки грудного вскармливания
саввинский роддом
межквартальные дороги
ямочный ремон
международные учения СНГ
чемпионат мастер-крэт 2025
всемирный день пчеловодства
бронницкие девятиклассники
творчество жителей
виталий гусаков
микрорайон заря балашиха
клуб азимут краснознаменск
краснознаменск помощь сво
военные следователи по рвсн
гуманитарный конвой краснознаменск
Южный поселок
ДОЛ Литвиново
Движение первых московской области
главное управление МЧС России по Московской облас
дерево жизни
сажаем правильно
передаем память
полянка
книги о войне
выставка книг
КапремонтШкол
ОбразованиеМО
вода в Шатуре
экскурсия по администрации
М-8 Холмогоры
детская группа хореографического коллектива
восточный танец
цыганский танец
алдан
актер дмитрий дюжев
кинотеатр октябрь в люберцах
спецпоказ фильма
центр обслуживания грузового транспорта
благоутройство
индастриал сити
электростанция
турбина
огнеборцы
власиха огнеборцы
пожарные власихи
профориентация школьников
козленок
страны мира
Суперниндзя
бтп во власихе
власиха теплоснабжение
Комитет по архитектуре и градостроительству
дуб волконских
дерево года - 2025
усадьба суханово
доращивание декоративных растений
аллейные деревья для озеленения
перезахоронение
солдаты красной армии
обрели вечный покой
деревня костино
ремонт тротуара в Каширском переулке
стадион протва
Предпринимательские курсы для школьников
сергей доля
Новые очистные сооружения
Капремонт очистных Протекино
Новый зал музея
бархатцы
Бронницкий лицей
образование в бронницах
конкурс арктур
шилово
центр протезирования
отечественный автопром
ретро машина
Микрорайон Дзержинского
Всероссийское голосование
дворец культуры мир
демонтаж асфальта
NICA
врач-отоларинголог
фок в бронницах
жк оптима
гюнай
20-ти томник истории России
историк Виктор Захаров
перемены 2025
Бесплатный концерт
ЛисьиНоры
ТранспортнаяИнфраструктура
сходка
БорьбаСБорщевиком
Фонд Троя
ремонт котельной в Бронницах
МЖД
наружная отделка фасада
студент-победитель чемпионата профессионалы 2025
модернизация ХВС
фонд новые имена
пианистка
получение льготных лекарств
мкд капремонт
келарская набережная
цифровой маммограф
Арт-обект
Изделия из стали
школа здоровое материнство
микрорайон Северный
театр на долгих прудах
марьино поле
военный недострой
Открытие нового цеха
передовые технологии
автоматизированные линии
уникальные разработки
выводка быков
Аркадий Зюзин
профессиональный чемпионат Мастер-КРЭТ 2025
победитель в компетенции электроника
дубненская городская больница
Лицей Авиатика
Федерация Дзюдо и Самбо
Дорога в мечту
дикое
животное
сурдокамера
спускаемый аппарат
невесомость
Земский почтальон
страусы
эму
Агрохимия
Щелково агрохим
территория власихи
Поликлиника рузы
то вкго
эгс в гис жкх
котельная гэмз
фонд дорога жизни
Добрый ангел мира
река битца
никольский храм 190 лет
отделение офтальмологии в Бронницах
врач-офтальмолог
школы дубны
отдых для детей
расчистка оврага
Катание на лодке
окна войны
почетный химик
дворец культуры победа
Блогер
Дмитрий Губерниев
Концерт для сотрудников
художники-графики
иллюстрации
метченко
найденко
харламов
реабилитация взрослых
Победа у каждого в сердце живет
Ферма в Походкино
кирилл и мефодий
Концерт ко дню химика
Заслуженная артистка России
забег рф
дрэг рейсинг
RDRC Racepark
Чемпионат России по дрэг-рейсингу
ильинская средняя школа 26
петр пророков
музей-заповедник абрамцево
производители
дары земли сергия
мелиховская весна
программа фестиваля
мария пророкова
художник-постановщик
лицей стрельцова
олег сотник
МДЖД
Паралимпийскаясборная России
Интересные люди
Домашние дивотные
Выставка кошек и собак
Акции зооактивистов
АкцияВодаРоссии
ЧистыеБерега
велозаезд
автотуризм
фонд защитники отечества в наро-фоминске
спаржа
двери
СПКимЛенина
Агропром
ПосадкаКартофеля
Конное представление
Трюки на лошади
Русские просторы
ремонт дороги от деревни Семеновское
московское долголетие
вакцинация животных от бешенства
лыткаринская участковая ветеринарная лечебница
13 гимназия
атп
завершение работ
новый рентген-аппарат в центральной поликлинике
лодки дракон
Подолськ
детский сад в подольске
встреча с участниками сво и их семьями
Защита от солнца
Завод РТИ
Переработка шин
соревнования по гребле на драконах
кубок по гребле
голосование за благоустройство территорий раменск
общественная территория в поселке совхоза раменс
фонтан будущего
3D-фонтан
диагностический кабинет
передвижной комплекс
кдп
K-pop
новое оборудование в автомобильно-дорожном коллед
школа попова валсиха
первомайская улица
Сердца отдаю детям
лидия лебедева
автобиография
александр кравченко
микрорайон Березки
состояние территории
автомобильный колледж в бронницах
общественное пространство в поселке совхоза раменс
Рельефные картины
Колледж Никулина
улица Маяковского
заливка асфальта
Рисование на ткани
устранение последствий прилета бпла
работа спецслужб
кандидат медицинских наук
благоустройство дворов в бронницах
стадион сокол
кубок по гребле на лодках дракон
поселок совхоза раменское улица центральная
билетные кассы
терминалы
сувенирный и книжный магазин
студенческий бизнес
кирбезопасть
СНИЛС
дракон мастерс 2025
брызги
покраска забора
Аквакультура
СельскоеХозяйствоПодмосковья
НовыеРабочиеМеста
фестиваль мелиховская весна
спектакль метаморфозы святая простота
чехов писатель на все времена
обзорные экскурсии
крокодиловая ферма
хозпостройки
призер олимпиады по истории
летний лагерь при школе
отдых детей
выпсукной в музыкальной школе
лыткаринская музыкальная школа
егэ по математике
передвижной кинофестиваль в Бронницах
открытие кинофестиваля
на службе Отечеству
строительство дорожной развязки
сквер по улице крупешина
ангелы в погонах
премьера фильма
документальное кино
125 лет библиотеке Звенигорода
95 лет детской библиотеке Звенигорода
путепровод в апрелевке
детский сад в ленинском
производство магнитопроводов в Бронницах
красково
клишино
капитальный ремонт школы искусств
проект nica
сергей мерц
курыжов
программа благоустройства
книговыдача
оздоровительная гимнастика
комплексный ремонт двора
покраска газовых труб
футбол в шатуре
стадион энергия
Монтументализм
Сграффито
министерство физической культуры и спорта
день пограничника
природный заповедник
Дзюдо и Самбо
Индустриальный парк Орудьево-2
школа 16 Серпухов
маммография в бронницах
имена
никифор марков
Отделка многоквартирного дома
библиотеки подмосковья
каратисты
атеросклероз
Реконструкция фонтана
городской стадион спартак
детский сад на 350 детей
м-7 волга
великий май
конкурс 9 мая
власиха фестиваль
советская мозаика
деревня ходаево
траснформаторная подстанция
замена трансформатора
надежность и качество энергоснабжения
программа модернизации
городская клумба
уход за растениями
обрезка кустарника
причал
куранты
встреча врачей с жителями
марк маилян
центр гимнастики смайл
никола ратный
зарядные станции
вай-фай
константин гарницарик
живая родина
фольклорный фестиваль
м-10
защита проектов
Танцевальные коллективы
Танцы народов мира
детские сады Ленинского округа
декоративное панно
парк бригантины
канатная дорога
столы для шахмат
летний душ
поливомоечные машины
Эстрадно-джазовое пение
сквер бугрова
загорские дали
электромобиль
зарядка для электромобиля
лыткарино советская 14
пункт обеспечения транспортной безопасности в уде
Транспортная улица
жители просят
остановка почта власиха
477 киевский власиха
телемедицинские консультации
компьютерная томография в бронницах
власиха жилой фонд
росжилкомплекс
военные общежития
филиал кубинский
дома во власихе
Эко-сплав
школа актерского мастерства волна
призрак оперы
студент-победитель всероссийского чемпионата проф
серебряный призер международного чемпионата профм
техникум казакова
21 научно-исследовательский испытательный институ
юбилей военных автомобилистов
очистка пруда в заворово
экологический субботник на пруду
улица запрудная
фестиваль в чехове
остекление здания
установка оконных блоков
утрамбовка асфальта
ассирийские художники
джуна
древний мир
франц рубо
музей-панорама бородинская битва
Выходные в Мураново
Забег на беговелах и самокатах
Детский забег
Масс-старт
Федеральный исследовательский центр животноводств
Уникальные породы
Школьные пятницы
Екатерина Кашникова
музей картинка Железнодорожный
Дорожный рейд
памяти воинов
быть воином
подвигу защитников Отечества
Барельефы
екатерина дашкова
отец вячеслав осипов
долгопрудненское благочиние
во славу росссии
виктор дувидов
РобоСити
Робототехника в Одинцово
Линогравюры
Russian Extreme Dog Trail
забег с собакой
усадьба мелихово
музей-заповедник в чехове
праздник сирени
жк 1-й южный
школа в жк 1-й южный
школа в ленинском
школа в жк горки парк
Кубок России по футболу
школа в жк пригород лесное
власиха фкр мо
старый жилой фонд
открытый урок для родителей
дошколята поповки
день сварщика
кед концерт
танцор брайан
коллектив banda
фестиваль каникулы
вэйци
исторический облик города
студенты-победители международного чемпионата
квидич
панорама
жк томилинский бульвар
Ловцы солнца
ремонт проездов и проходов
ремонт потолка
газфикация
питьевые фонтаны
раменский коллледж
системы умного дома
турецкая кухня
японский язык
Руад
конный центр
лучик добра
коннодосуговый центр
ДеньЗащитыДетей
ДетскийПраздник
ЛучикДобра
МероприятияПодмосковья
лепка из глины
лето 2025
именами героев
нейроонкология
ильинский пляж
зоны отдыха у воды
лето для тебя
федоровская икона
Агрогрант
РазвитиеСельскогоХозяйства
Сердечный ритм
садовые культуры
жимолость
приусадебный участок
солнечная поляна
колонна
Москва-Алтай
80-летия Победы в Великой Отечественной войне
Театр моды
система безопасный регион
торговый центр курс
малая родина
аотай
предки
Красивый подъезд
быть а не казаться
конкурс наставников
беговые дорожки
зона для прыжков
постановка на воинский учет
власиха военные следователи
одинцовский военкомат
новое ограждение
бункер для КГО
дополнительные баки
твердое покрытие
наро-фоминский городской прокурор
мозаики леже
мбу сдх шатура
поселок красный октябрь
обновление котельной
власиха подготовка к зиме
модернизация системы теплоснабжения
реализация мероприятий по развитию инженерной инф
летние клумбы
благоустройство мемориала
тротуар в куниловском переулке
неискусственный интеллект
алексей чадов
лагерь терра ностра
интерьерные куклы
выход
озеро дивное
михаил объедков
видновская больница
врип главы Олег Сотник
rising star
кудрявцев михаил
Эко-неделя в музее
косметический ремонт подъездов в Бронницах
пряничная мастерская
мастерская софи
музей пряника
макет троице-сергиевой лавры
ПлемзаводПойма
отключения горячей воды
профилактические работы в котельной
обустройство полов
стяжка полов
прокладка инженерных сетей
окна и двери
дирекция парков
Сквер имени Пушкина
занятие в дк сатурн
профилактика сердечно-сосудистых заболеваний
сезонная ярмарка товаров
власиха продовольственная ярмарка
ярмарка во власихе
товары на ярмарке
выездная ярмарка
однолетние цветы
Первый Рузский казачий кадетский корпус
мемориал в таширове
отключение воды
Академия дзюдо
аэрофлот
доноры подмосковья
кдц подмосковные вечера
улица чехова 2
активное долголетие балашиха
подушки косточки для сво
Вокзал в Талдоме
профилактика мошенничества
забег в Назарьево
Забег в память маршала Мерецкова
комплексное благоустройство дворов многоквартирн
ногина 6
сверчково
свиноферма
семейный центр преображение
приемные родители
школа приемных родителей
фетиваль
администрация власихи
Субсидирование
демонстрационный экзамен
итоговая аттестация
николаевка
торговые ларьки
монтаж перемычек
оконные проемы
обновление инженерных сетей
жк алексеевская роща
гранель
предприниматели Рузы
домашний поросенок
стрелино
мкр Солнечный
дивный сад
молодежная улица
день эколога
Уникальный объект
профилактика травматизма
Мобильный офис Сбербанка
тетрис
система вентиляции
воздуховоды
ремонт водопропуска
в движении - вместе
чистота и порядок
содержание детских игровых площадок
солнечная 6
ремонт труб в квартирах
шоколадный дом
юкотан
мбук компас
власиха компас
Семья Самоцуповых
Клуб Дмитровская дружина
артель мастеров подмосковья
добровольчество
очистные в солнечногорске
тротуар в кратово вдоль раменского шоссе
дтп на трассе м5 урал
авария с двумя большегрузами
московский областной центр крови
врачи подмосковья
электровелосипед
прокат электровелосипедов
велопрокат
победитель межрегионального этапа всероссийского
Вакцинация диких животных
школьный поход
соревнования по туризму
курбан-байрам
зип-лайн в лыткарино
покос травы в бронницах
отлов животных
пожар в сафоново
Прокурора
безопастность
РусскаяЯгода
ЯгодныйСезон
МосковскаяОбласть
инженерная
цтп спортивный
микрорайон спортивный власиха
вейксерф
слет-лагерь
культурное лето
день рождения пушкина
Библиотеки Звенигорода
марафонзеленыхдел
движениеэкосистема
ПДК Южный
Развязка на ЦКАД
снос недостроев
верхнее озеро власиха
торгово-промышленная палата балашихи
фестиваль бизнеса
Уборка автобусов
Чистый автобус
балгодарность
ручей
Катание верхом
летний чемпионат
раменский ипподром
испытания лошадей рысистых пород
международный день русского языка
регулировка светофора
лыткарно
урок безопасности в школе
школа в ЖК Золотые ворота
школа долгострой в королеве
детский сад при Лицее 4 в королеве
детский сад при лицее 5 в Королеве
ремонт детского сада в королеве
Поликлиника 1 в Королеве
капремонт поликлиники королев
детская школа искусств в Королеве
пристройка к школе 1 в Королеве
У троицы
демонтаж старых окон
замена оконных блоков
внутренняя отделка помещений
фасадные и кровельные работы
Место для купания
музей усадьба лопасня-зачатьевское
день рождения александра пушкина
бесплатные обзорные экскурсии
потомки поэта
поэт александр пушкин
некрополь
сын александра пушкина
заупокойное богослужение
танцы на тнт
Решетникова
строительство 2025
экскурсии по фабрике
озвучивание
undertale
Дары дуба
сказки пушкина
дни деревень
кидс кросс
скейт кросс
роллер
роллер спорт
Дмитровский суд
Мособлсуд
мусульмане
Чистая река
вейк-парк
спартакиада пенсионеров
кадетская школа
Элетросталь
ледовая площадка
пляжи в ленинском округе
открытие лагерной смены
ливневая система
капремонт дк исток
Луховицы Инфраструктура РемонтМоста
лагерь в школе перспектива
новый флюорограф в речицкой поликлинике
улетные каникулы для подростков
летний лагерь в бронницах
Российская кинологическая федерация
Спорткомплекс Максима Парк
фонтанчики
рамспас
Пересадка деревьев
многомама сергиев посад
занятие для будущих мам
сбор сумок в роддом
мфц власиха
услуги в мфц
власиха мфц
surf spot
roki-2
строительная 10
медиапритяжение
автомат с питьевой водой
ЕГЭ по химии
Лесные пожары
Центр мониторинга лесных пожаров
черновая отделка
аниматор
лагерь в школе
грантовая поддержка
власиха дорог
Би энд би
Писатель Евгений Курочкин
общественный совет больницы
Конкурс отрядных визиток
парк аттракционов в Бронницах
5d кинотеатр в Бронницах
Фабрика спортивных изделий
питомник служебного собаководства
места отдыха у воды
шестиугольное футбольное поле
научись плавать
тополиный пух
баскетбольная площадка
Власти
выставка к дню медицинского работника
айвазовский
море великих
поздравили врачей
детский сад Малыш
ремонт сада в шаховской
котельная в шаховской
стела шаховская
ремонт лицея 10
лицей 10 в клину
ремонт стадиона в клину
очистка реки Сестра
школа олимпийского резерва в клину
спорт в клину
сборная омана по футболу
гимназия им ВН Татищева
образование в клину
школа содружество высоковск
снос трц в клину
благоустройство в клину
Лилия Белова
Марафон зеленых дел
наследие предков
лето в парках
усадьба графов разумовских
Каникулы в подмосковье
новый корпус лицея в бронницах
АграрныйТехникум
МолодыеСпециалисты
ЛетнийОтдых
БезопасностьНаВоде
невьянские мастера
невьянский музей
уральская пизанская башня
башня демидовых
Награждение врачей
геймерские кресла
кресло-авиасимулятор
симулятор гонок
vr в библиотеке
vr-шлем
музей ретрогараж
ушастый запорожец
советское кино
выравнивание стен
оштукатуривание стен
трассировка стен
замена инженерных сетей
эковелозаезд
досугвдубне
дубнанаукоград
каякинг
иваньковскоеводохранилище
гипсовыекашко
туризмвдубне
ремонт детского сада клин
клубничная луна
крутовец
Строительство фока
живой уголок
выставка импульс творчества
Кинофестиваль Движение по вертикали
символы
сыры ручной работы
ремонт фундамента
красногорье
заливка полов
травмпункт
бочно-модульный теплопункт
строительство бтп
капремонт отмостки и цоколя
купание в озерах
запрет купаний в озере
Повесили флаги
Государственный праздник
пешеходная дорога
уличный спорт
авиационный техникум в раменском
студент авиационного техникума в раменском вышел
писатель алексей плотников
библиотека видного
деньроссии
украшениедубны
союз Содействие женскому предпринимательству
Нежная клумба
новый цветник на площади имени Тимофеева
наталья трофимова
ремонт региональной дороги
детскиеплощадки
парксемейногоотдыха
северная улица
9-й детский сад
перепланировка
чистовая отделка стен
коммунистическая 27
Талицкий лес
тюбинговая трасса в клину
ремонт канализационного коллектора
экология солнечногорска
школа в поварово
школа в солнечногорске
гимназия 6 в солнечногорске
промышленный коворкинг
детский сад в поварово
производство спортивного оборудования
мост через реку Скалба
нина лунева
флэшмоб
Герой России Александр Бородин
юнармия наро-фоминск
гидрокостюм
дыхательная система
пионовый фестиваль
пионы
пионовый рай любови аристарховой
Клуб Саланг
терветуправление 2
автостоянки
детские и спортивные площадки
алексеевка
Федор Храпов
МХЛ
Кубок Харламова
набережная выстрел
лайфхаки
ленинский забег
бегуны
День России 2025
Лагерь Ромашка
Рисунки мелом
фестиваль исторической реконструкции наследие пре
дошколята власиха
иконы на фронт
Фотографии города
голубые озера
забег в честь дня россии
вишняковский парк
Акрил
власиха триколор
акция письмо солдату
фестиваль с россией в сердце
фенечка
нитки
музей ввс
городской округ щелково
день россии в бронницах
сотрудники мчс
власиха вручение паспоров
никольский пляж
открытый огонь
пленер
власиха библиотека
группа сапсан
ярмаркамастеров
мц подсолнух
Россия -это мы
Мотофестиваль
ассирийцы
площадькосмонавтовдубна
надялеже
Фестиваль крылья победы
Авиафестиваль
Радиоуправляемые самолеты
тактический браслет
ансамбль самоцветы
группа вэда
вокальный ансамбль авангард
хиты прошлых лет
фестиваль исторической реконструкции
русский дом
FMX13
забег с собаками
crazy dog race
Бег гармонии
экстремальный забег с собаками
Парад Московии
Трейл 2025
Кубок Московии
Алексей Бобылев
трубецкая улица
Гимнастическая премьер-лига
Спортивный Звенигород
абрамцевский колледж
колледж абрамцево
студенты абрамцевского колледжа
верблюжья ферма
день куклы
фестиваль кукольника
Турслет педагогов
Профсоюз работников образования
медицина в долгопрудном
Мосотряд-90
изделия из пропилена
пластиковые емкости
ванны
оборудование собственного производства
гибочные машины
сварочные аппараты
стыковые станки
свалка мусора
полтевское шоссе
фок звездный
детские летние лагеря
пионерский костер
тренировка лыжников летом
дошкольники власихи
экотропа в детском саду
экологический квест
ботаника на песках
раменская городская прокуратура
занятие с участниками клуба активное долголетие
коломенский калач
радиовизиограф
Мощи
поддержка медицинских работников
садовый центр Харченко
цветочная компания харченко
садовый центр бояркино
Дым
максим самсонов
спортивный лагерь
ремонт проезжей части
обновление пешеходных дорожек
полусферы
расширение автостоянки
дополнительные парковочные места
текущий ремонт поликлиники
школа лидерства
лен
платная парковка на красноармейской улице
психологическая школа
школа юппи
юные психологи
поликлиника в мисайлово
укус насекомых
аллергическая реакция
РЕМОНТ ДОМА НАРО-ФОМИНСК
сергиево-посадский мясокомбинат
велопутешествие
на велосипеде до Владивостока
Реутов-Владивосток
грузы
власиха волонтеры
жизни
бобмакар
борисмакаров
культуравдубне
селфи-камера
Локации для фотографий
детская педиатрия
телефонные мошенники
полицейские власихи
трибуна
Реконструкция моста
Ярославское шоссе
Строительство детской поликлиники
Артель Валерия Гришанова
Дмитровское благочиние
плаж
Не дай себя обмануть
надземные переходы
остановка кладбище
ветерану 103 года
порт коломна
люберецкий техникум им Юрия Гагарина
авиационная техника
дворец культуры химик
мир наивного искусства
балашихинский историко-краеведческий музей
большой пруд
земснаряд боцман-м
уборка мусора и тины
удаление аварийных деревьев
жилье по коммерческому найму
кожедуба улица
автобус 364
жк онегин
Дмитрий Ланской
Детская профориентация
Цветоводство
деревня ивановское
производство пищевых продуктов
Муза Рузы
Эстафета Бег Гармонии
Изо-студия
дк восток
цигун
федерация цигун россии
плановые отключения горячей воды
ремонт труб в доме
замена труб горячего водоснабжения
универсальный бой
пушкинский день россии
городское отделение ЕР
сказка о рыбаке и рыбке
затишье-2
модернизация сетей
образование в истре
ремонт лицея в истре
концертный зал
Новое Пушкино
новый врач-рентгенолог
кинотеатр в Серебряных прудах
кинотеарт
Центральный дом культуры Серебряных прудов
мап 6
транспортный чачс
мтди
Икона Троеручица
Новые лавочки
бродскийвдубне
бродскому85
бродий
диалог двух культур
березовая роща авиаторы балашиха
Дедовская школа
куст
лесопарк Соколка
благоустройство в истре
котельная 8 в Истре
Дедовская котельная
спорт в лыткарине
японский сад
питомник южный
лучшие
промысел
Полет Чкалова
автор
секция по универсальному бою
ассоциация сво
власиха сво
Контейнеры морского типа
детский лагерь звездочка
правила поведения на воде
вдпо
брошюры и памятки
демонстрация пожарной техники
оборудование и снаряжение
новый учебник истории
шахматныйтурнир
эстафетапоколений2025
шахматывдубне
поликлиника в пушкино
медицина в пушкино
Вступительные экзамены
Рузский кадетский корпус
защита диплома
студенты МАДИ
школа 4 в Красноармейске
Замена плитки
новая школа в пушкино
жк новое пушкино
новый реанимобиль
трасса М-8
Реконструкция трассы М-8
поликлиника 9 в ивантеевке
ремонтдороги
улицацентральная
детская поликлиника в пушкино
Ретро-техника
онлайн консультация врача
рецепт на льготное лекарство
реузультаты анализов
корректировка лечения
запись на прием
инфоматы
региональный портал здоровье
мобильное приложение
гостелемед
рт доктор онлайн
уникальное футбольное поле
летний лагерь в центре хорового искусства юность
социально-экономический институт
Открытие своего дела
сквер чернышева
ирландскиетанцы
советский модернизм
бородино 2025
ремонт общежития
красногорский колледж
детский сад Родничок
детский сад в долгопрудном
детский сад 9 в долгопрудном
ремонт детского сада долгопрудный
пристройка к гимназии 13
гимназия 13 в долгопрудном
школа 7 в долгопрудном
ремонт школы 7 долгопрудный
счетчик
поверка
Стадион в Зарайске
александр твардовский
поисковый отряд бумеранг-досааф
Маревен Фуд Сэнтрал
завод сублимированных продуктов
поселок столбовая
улица вокзальная
улица малая
лесная земляника
сезон сбора земляники
сбор земляники
танцевальные истории
дом для переселенцев в шатуре
ремонт дороги в бронницах
ремонт дороги в каширском переулке
новая школа в дзержинске
Викторина по сказкам
Барынино
ЕГЭна100баллов
ЕГЭпофизике
ЛицейКадышевского
стобальник из бронниц
выпускница из бронниц
школа имени Тимофеева в Бронницах
Новая пешеходная зона
сети теплотрассы
Центральный парк Пушкино
Обновление сквера
река копнинка
строительство объездной дороги
бассейн перспектива
занятия в бассейне
формула
промывка труб хвс
Зарайский бизон
ЗБ
выжигание
места общего пользования
прокурор серебряно-прудского района
кибермошенничество
школьная теплица
МБОУ Гимназия 1 им. Героя Российской Федерации А.
чат здоровье
осетровое хозяйство в серебряных прудах
аббитуриаент
бюджетное место
ОЭЗДубна
герои-панфиловцы
нелидово
Звенигородское лесничество
Птенец
Воробей
рамееский дорожно-строительный техникум
деньпамятиискорби
чтобы помнили дети
технопарк раменское на улице михалевича
строительство нового производственно-логистическо
Все за спорт
библиотекамкрнДепоЛобня
БиблиотекиЛобни
магия науки
Экстремальный исторический забег
След в след
Мозаичное панно Семья"
Мозаичное панно Семья
сергей карякин
мемориал жукову
зажги свечу
отряд вымпел
поисковики власихи
поиск погибших в вов
Фестиваль японских машин
JAPDAYS
Дмитровский городской округ
Возложениецветов
Помнимисторию
режиссер анхель гутьеррес
захоронение праха
писатель антон чехов
актер николай бурляев
эстафетапоколений
международный московский яхтенный порт
яхты и катера
гелендваген
аквагелик
маломерный флот
китайские яхты
реконструкция взу
цмсч 94
бесплатное мороженое
образованиевдубне
костер
центр семейного репродуктивного здоровья
врач-дерматовенеролог
проверь свое здоровье в парке
Элевидис
мышечная дистрофия Дюшенна
тяжелобольной ребенок
этнофестиваль
купала 2025
новая библиотека
книгохранилище власиха
сквер 45-летия
обновление тротуара
замена покрытия
обустройство парковок
развитие дорожного комплекса
молодежный лагерь яркое лето
Культурно-спортивный комплекс
помятник
звезда
цветы в парке
огород в парке бронницкий луг
парад судов
биотеххогвартс
лето в технопарке
ремонтныеработы
сапборды
власиха самбо
Молодой автор
переселенцы из аварийного жилья
Фестиваль Город мастеров
мировой рекордсмен
Проверь здоровье
осетровая ферма
голдфиш
студенческая олимпиада
пациентка
Подготовка к асфальтированию
павленское озеро
квартал изумрудный
микрорайон изумрудный
детский центр Московия
образцовый детский оркестр московия
день балалайки
очистка озер
Маршалы победы
трудовые бригады попова
трудовые бригады лето
стоимость
культканикулы
девиз
прием документов на поступление в колледж
краснокнижные насекомые
центр дружба
Ромашка
улица лопасненских ополченцев
укладка бордюров
врач инфекционист
Сухой порт в Селятино
Логистический центр в Подмосковье
Музыкальный сборник
улитки
дикая орхидея
любка двулистная
краснокнижное растение
капремонт проспекта Ильича
дороги в шатуре
укладка асфальта в бронницах
поселок ильинский улица первомайская
дрессировка
поселок ильинский улица опаринская
Панда-парк
Гимназия 1 им Героя Российской Федерации А.В. Бала
учебник Мединского
дар музею
школа 2 в шатуре
образование в шатуре
памятная акция на площади имени Тимофеева
Выпускной 2025
студенческий сквер
плавучие домики для птиц
утиные домики в бронницах
Историй
защита от мошенников
Город на Осетре
госпитали в абрамцево
егор кончаловский
традиции милосердия
егэ по биологии
девятиклассники
выпускной бал
аттестаты об общем образовании
директор гимназии марина тарасова
победители и призеры олимпиад
доставка
Фонтанный комплекс
строительство комплекса по производству магнитопр
зэт энерго
новые рабочие места в бронницах
модернизация системы отопления
школа на 550 мест
беговая дорожка
высокобалльник
ретротехника
апелляция
результаты егэ
клубника
совхоз имени ленина
киоск клубничка
Логистика
власиха березки
улица южная власиха
деликатесы
Археологическая выставка
Зарайский музей
Стоянка древнего человека
председатель мкд
текущий ремонт подъездов
работа для подростков
баллы
100 баллов на ЕГЭ
Лечение переломов
Траматолог
спортивная 12
прогулочные зоны
велосипедные дорожки
Купол над храмом
100 баллв
десантная 14
спасский бульвар
росхмель
антипино
Теартальная студия
Голоса
настолки
капитальный ремонт котельной в бронницах
Нацпроект Чистая вода
советы от банка
водители ленинского округа
медицина в одинцове
заместитель директора гимназии
елена каргашилова
номинация дебют
пмэф
осп агро
кдц в одинцове
кдц ромашково
Фельдшерский здравпункт в шатуре
царская рыбалка
новый мост через Клязьму
инновационные технологии
умные решения
нестандартные учебные практики
аттестат
деревня кресты
новыедворы
деревня толстяково
Иван-Купала
Почетные жители Звенигорода
вольные копии по мотивам самых дорогих картин мир
котельная в шатуре
вертолет
подъем
москворецкая 3а
Переезд травмпункта
встреча в дк имени воровского
Вопрос жителя
футбольный интенсив
школа на Брагина 3А
пожар во флигеле
Черновой пол
100 баллов за егэ
кпп-2 власиха
Новый вектор
кают-компания мечтайте
Водородные установки
дом культуры им Нариманова
дом культуры в шатуре
детский сад в одинцове
детский сад в жк инновация
мошеничество
тайцзи-цюань
Щи из топора на полях Бородина
музей-заповедник бородинское поле
Берзка
Березка
выращивание зелени
выращивание салата
пристройство щенков
банкротство
кредиты
кредитная история
однажды в сказке
шляпник
день рождение
льюис кэрролл
областные соревнования по кануполо
власиха глава
красный аттестат
выпуск 2025
Голос Звенигорода
день молодежи в раменском парке
экзотические растения
ромео и джульетта
время первых
акция проверь свое здоровье
день молодежи 2025
зеленый своп
обмен растениями
новый памятник
DIYнозавры
потеряшки сергиев посад
кукольное дело
народные сказки
День пожарной безопасности
стена благодарности
стобальники
сергей антипов
усиление фундамента
Вайлдберриз
тактические браслеты для сво
федерация силовых видов спорта Балашиха
турнир по русскому жиму
подъем богатырского бревна
парк Дружба
октябрьская улица
Николо-Кропотки
Интернет-мошенники
цирк мансуровых
летний трудовой десант
тимоховский парк
Кедры из Кореи
Цианотипия
Парк Волен в Яхроме
Велозаезд Gran Fondo
сухое дерево
Новые трубы
благодать
локация для фотосессии
производства БАДов
роботизация
Клуб Русский алмаз
Регина Исачкина
диафильмы
выпускной 9-х классов
бронницкие выпускники
звезды подмосковья-2025
кульпино
Тай-дай
Обновление поездов
Новые электрички
любительский турнир
ветераны бронниц
61 пожарно-спасательная часть
робот пес
компьютерная академия
Инфраструктура для жизни
машинист
День семейного здоровья
пожарная команда
школьный летний лагерь
пожарный расчет
Развитие и функционирование дорожно-транспортного
робот-пес
Слобода Глушенковых
озеро Травинское
Новое расписание автобусов
модернизация инженерной инфраструктуры
участники сво и их семьи
нуждающиеся граждане
продолжение сотрудничества
открытие памятного знака
лучший молодой хирург России
дети и подростки
открытый дк
летняя спартакиада молодежи 2025
соревнование по водному поло среди юниорок
академия дзюдо в Звенигороде
поликлиника в одинцове
поликлиника в ЖК Гусарская баллада
дом в поварово
дом для переселенцев солнечногорск
центр садоводства и питомниководства
Концерт на воздухе
маршрут автобуса 31
изменение маршрута автобуса в бронницах
весенний призыв
вооруженные силы россии
дез лыткарино
городской выпускной
медалисты 2025
ремонт мастерских в колледже
кран
Мастер-класс от пожарных
контейнеры для стекла
за раздельный сбор
НовоеПроизводство
Руза хутор
Эвакуация тц
Обновление улиц
Эконнмика
города и люди
стрелковый клуб
Теплотрассы
Детскийдосуг
Библиотекалевобережья
обновлениетруб
международный день собак
Университет Вернадского Балашиха
кинологический центр Балашиха
можайская бибилиотека
аварийно-спасательная служба
пневматический пистолет
мишешь
мишени
мишень
азарт
точность
скорость
новый спортивный комплекс в бронницах
Экологическая викторина
ремонт проездов
звездный выпускной 2025
софия фанта
выставка гобеленов в раменском музее
ГИБДД Балашихи
встречи
московское центральное кольцо
художница Любовь Рябова
БольшаяВолга
Выставкаграфики
двор-оранжерея
заречная улица
ремонт котельных в бронницах
подготовка котельных к отопительному сезону
музыкальный квиз
учитель химии средней школы 8
входная ворота
историческое сооружение
декоративная косметика
егэ по информатике
молудь
Стокгольм
александр шаганов
ук выстрел
день собак
помоги приюту
рожайка
передовая система теплоснабжения
уникальная ППУ изоляция
система контроля
развитие инженерной инфраструктуры и энергоэффект
минчистоты
полина прощенко
международные соревнования
допуск
санкции
оздоровительный центр дельфин
досуг для детей
зентангл
дудлинг
Предприятие GRC
криогенмаш Балашиха
турбодетандеры
мультистобальники
оккультизм
Библиодворик
Обработка деревьев
академия вратарского мастерства
Вячеслав Чанов
Игорь Акинфеев
райская птица
Незаконная торговля
тротуар вдоль железной дороги в поселке ильинский
тротуар на праволинейной улице в послке ильинский
перенос мемориала
памятник погибшим выпускникам
роботизированный распределительный центр
магнит в подольске
Роборука в магните подольск
rusсвет
сенежский олень
мини-ферма
благоустройство пляжа
пляж в бронницах
пляж на бельском озере в бронницах
Игры на улице
Детская программа
лагерт дневного пребывания в бронницах
трибуны
автохлам
брошенный автомобиль
бесхозный автотранспорт
эвакуация автомобиля
парк чернышева
поселок совхоза сафоновский
безопасностьдетей
квестбезопасность
дкоктябрьдубна
подмосковные производства
новые бордюры
Госавтоинспекции России 89 лет
КТ-кабинет
филиал 3 Балашихинской больницы
пристройка к Немчиновскому лицею
лицей в одинцове
дом для переселенцев подольск
дкоктябрь
художникпокостюмам
школа в одинцове
новая школа в звенигороде
акватермальный комплекс в одинцове
мрсэи
ремонт детского сада егорьевск
детский сад 1 егорьевск
абонент
отдел
стаж
астрофотография
иван вагнер
серебрянные пруды
1-я больничная
елизаветинская больница
д Михнево
фалт
арт-станция
елена поленова
музей-заповедник поленова
абрамцевская резьба
Мост в Усть-Пристане
Нацпроект Инфраструктура для жизни
Проект Выходи во двор
фестиваль в хотьково
абрамцево-кудринская резьба
чествование семей раменского округа
харлей дэвидсон
клуб хог
семен нудельман
лесопарк загорское море
рыболовный фестиваль
компания азот
парад семей в бронницах
шествие семей в бронницах
Дворец спорта Триумф
чествование семей-юбиляров
Денькардиолога
Мсч9Дубна
Деньсемьилюбвииверности
ДеньПетраиФевронии
волоколамский муниципальный округ
проспект ленина егорьевск
благоустройство егорьевск
uma2rman
конкурс чучел
терапевтическая тропа
лесотерапия
отгрузка
100 лет поселку
Развязка у Подосинок
парад бабушек
3-я спецпрокуратура
мошеннические схемы
холдинг деталь бизнеса
Неразлучники
Кадетский корпус Следкома
Поселокзапрудня
Иван ку
старое ярославское шоссе
речное дело
речная навигация лыткарино
день речного флота
стриж 7
МОПЦ Балашиха
волчок и поросенок
Итальянская музыка
капремонт проезжей части
парковочные карманы
Губайдуллины
власиха котельная 2
Эмаль
новая поликлиника на высоковольтной
челюскинцы
исследование арктики
СтадионСпартак
Цикл лекций
раменская школа 5
медалисты и стобальники
многодетнаясемья
улица чехова 59
пешеходные дорожки и тропинки
расширение парковок
скамейки и урны
Некоммерческие организации
Сквер 60 лет Победы в Егорьевске
благоустройство в егорьевске
летний лагерь поповка
Активные жители
Сквер Маяковского
приемнаясемья
ремонт путепровода в воскресенске
ремонт моста на трассе А-108
парк фабричный пруд реутов
благоустройство реутов
игровая зона в парке
офиц мфц мои документы
власиха день семьи
мастер класс ромашка
обновление набережной
раменский горрдской парк
культурно-досуговая программа в день семьи любви
прокуратура Балашихи
уловки мошенников
100 баллов по образование
рубиновая свадьба
джамбу
лыткарино гимназия 1
Косолаповы
капремонт многоквартирного дома
косметика
пляжная зона в химках
парк имени льва толстого
производство БАДов
Светоотражатели
Регистрация брака
Вышка сотовой связи
Катаклизм
дрифтвуд
ключницы
Завод спкб
площадь дк
зарядки для электрокаров
проверка Роспотребнадзора
бетонный завод
очистная станция
прицеп
детские комплексы
видеокамеры
летовдубне
раздача цветов
спортивные игры в лагере
Синьковское водохранилище
Подъячевский пруд
летний интенсив
загрязнение воды
занятие в дубовой роще
Мебельная фабрика
Деревенский двор
парковочный карман
экоцентр царская охота
видновская прокуратура
Волотеры
конецрт
рейд безопасности на пляже
Благостройство
скульптуры из сена
парковые скульптуры
улитки из сена
теруправление волченки
Советы доктора
Даровое
Усадьба Достоевских
валентина устименко
День гинеколога
мамино лукошко
родовое имение
подворье
старая плотина
Будущая профессия
Канал имени Москвы
миодистрофия дюшенна
белый песок
зона отдыха с лежаками
место для загара
пешеходные зоны и дорожки
ампир
боей сво
деревня смолино
Фермеры Смирновы
каникулы с росгвардией
варварушки власиха
раздача питьевой воды в бронницах
жара в бронницах
волонтеры молодой гвардии
ПриюткошекЛеопольд
дол осетр
видео игры
камазы
центральная библиотека наро-фоминск
модульная библиотека
замена дорожного покрытия
план ремонта на 2025 год
жк бутово парк
МОПЦ Балашихи
день открытых дверей в МОПЦ
мастер-класс с Олегом Тактаровым
доула балашиха
всероссийские соревнования по гребле на байдарках
гонки на байдарках и каноэ
соревнования по гребле на байдарках и каноэ памят
Обходы администрации
котельная в долгопрудном
выписка
яздан
котельная на первомайской
видео
котельная на заводской
ремонт котельной в долгопрудном
дороги истра
стадион мещера
стадион егорьевск
спорт в егорьевске
Строительство нового дома
таланты
трубецкой
фотовыставка птицы россии
поселок электроизолятор
туристическо-гостиничный комплекс
инфоаструктурный проект
волоколамский округ
лыщиково
птенцы аистов
рейд на Бабошкино
кенгуро про
сенокос
власиха спортшкола
восересенск
встреча жителей с помощником прокурора
дачи
земля
капитальный ремонт школы в наро-фоминске
наро-фоминская школа 1
секрет успеха
Крановщик
вокальный коллектив эврика
звание образцовый
единый день фольклора
Медицина талдом
завод по переработке пластика
жара в подмосковье
васькино
улица полевая
обращение с отходами
мария стойнова
власиха алтстрой
теплопункт
рейд сбавь скорость сохрани жизнь
госавтоинспекция балашихи
отдых на пляже
сапбординг в воскресенске
фотограф Владимир Думчев
фотосъемка
день фотографа
животноводство в подмосковье
Активна
выездная администрация в парке
румянцево
tenzor sailing club
футбор
музей-усадьба
Мотошоу
Мотофристайл
сенокос в муранове
музей-усадьба мураново
летний кинотеатр
Сенокос в Дубровках
Сырный трейл
Дирижер
Голоса побед
бронницкая казачья молоджная сотня
полевой выход
патриотический клуб в бронницах
курс молодого бойца
ночной забег
трейл раннинг
российский красный крест в воскресенске
мастер-класс по сердечно-легочной реанимации
Луховицкийокруг
Усадьба Быково Проект возрождения
Мотомосква
Мототерапия
расписание парома
безопасность подростков
обучение на пит-байке
костюмированный заплыв
переработка стекла
молодой предприниматель из восересенска
проектная смена
зарубежные гости
карт
автомобили на водороде
цветники в березке
космонавтов 38
сно гуд
банный лес
Киберпреступники
Дмитровский металлоцентр
дыни
чипирование животных в бронницах
вакцинация животных в бронницах
выездная регистрация домашних животных
детский сад золотой ключик
Комунальщики
Симфонический оркестр
М1
расширение м-1
реконструкция м-1
лужайка
подосинки
Град
Солнечный берег
Гербарии в стекле
новый мост в рузе
Поп-музыка
Высадка растений
Школа в Зарайске
ремонт школы искусств в наро-фоминске
гимназия 1 баландина
новые тротуары в раменском округе
тротуары на дороге ммк-нащекино
сенаж
уборка сена
капитальное благоустройство дворовых территорий
лыткарино октябрьская 5
ВелоПушкино
Спорт на районе Пушкино
отец никодим
Благоустройстводвороввподмосковье
фабрика чистая линия
борьба с мошенниками
схемы обмана
дергаевская 8-18 и 26
дергаевская 8-18 и 24
Афанасовское шоссе
музей вов
исследовательский проект
бадминтонный центр
дирижабельная улица
открытие дороги
музей-усадьба лопасня-зачатьевское
пушкин - имя ратное
потомки пушкина
юрий авдеев
Отключение электричества
дорожный проезд
дворец культуры химки
видновская сош 11
врач скорой помощи
Новые теплосети
сход грунта
выставка живописи
влад кравчук
разгул стихии
Концерт для военнослужащих
ильинское
касса самообслуживания
новая детская площадка на речной улице
капитальный ремонт детской школы искусств
капремонт бронницы
телоэнергетика
улица чехова 6а
машина-измельчитель
Орудьевское водохранилище
ирга
сбор ягод
на спортивной волне
Ярмарка фермерских продуктов
личные данные
ремонт трассы
дети власихи
отдых в лагере
озерный в рузе
лето в лагере
тимоновская школа
родительский актив
24 школа Монино
Музей истории
профильные классы
ветеринарный класс
набор учеников
шестая летняя спартакиада молодежи
соревнования по водному поло среди юниоров
сказочный
фонтанвсквереЖуравлева
НовыйфонтаннаБольшойВолге
парк химки
благоустройство парка химки
удаление упавших деревьев
содержание двора
паркивгороде
бабаЯгавДубне
фестиваль заповедное
Стоянка велосипедов
ФНЦО ВНИИСОК
Грибовская станция
Молодые учные
усадьба петровское
котельная 3 в дубне
люк
Создание украшений
Монастырка
Центр НАМИ
МодернизацияЖКХ
НоваяКотельная
ТеплоДляДома
СтройкаГода
Центра НАМИ
утилизация опасных медицинских отходов
укладка новых труб
уникальная изоляция труб
территория смыслов
форум росмолодежь
кафе на озере
озеро голубое
шрифт для города
сергий 700
живой звук
закубежье
Озеро Киово
новый дом в егорьевске
дом для переселенцев егорьевск
камень желаний
MO Basket
замена теплосетй
55-я международная олимпиада по физике в Париже
азиатская олимпиада по физике
второй участок юла
Аварийно-диспетчерская служба
Улучшение в АДС Зарайска
капремонт домов
Тропа поэтов
Усадьба Абрамцево
проект предшкола
день подвижных игр
скорая помощь Балашиха
Спасение лося
зелень
Санитарно-экологическая очистка водоема
перелом бедренной кости
лыткарино гимназия 4
прогулки и занятия с собаками
огороженная зона
трасса а-108
хомяково
каменки
выездная администрация в воскресенске
Езда на лошадях
ремонт балконов
от государя к преподобному
покровский монастырь
обретение мощей
летний сергий
Щелковский музей
Жаркоелето
Молодыеталанты
скамья примирения
газонокосилки
триммеры
заявки жителей
Орешково
НовыеДороги
КомфортнаяСреда
Шум от дорог
детский садик на октябрьской
сильные фигуры
гольф-клуб
пешеходная зона дубна
благоустройство центральной улицы дубна
экология дубна
Дубна Плюс
конкурс дерево года - 2025
власиха лето
деньфольклора
жк EVO Реутов
строительство реутов
рейд по безопасности купающихся
капремонт школы 32
хоккейная команда химик
Пляжи Рузы
кантемировский микрорайон
улица тютчева
котельная 1 реутов
дорога вдоль участков многодетных семей
ремонт дорог бронницы
музейкрылатыхракет
арифмометр
гастрономический сувенир
раменская ириска
благоустройство в раменском
борисоглебское озеро
мурал войны в реутове
строительство школы реутов
новый корпус школы 4 реутов
сбор бойцам СВО
молодая гвардия наро-фоминск
Ольга Варвус
пожарно-спасательная часть 75 балашиха
йога на сапе
пространство детской мечты
гауди
каркасная технология
китайский чай
Поэт Олег анофриев
царь нептун
Дача Маяковского
День рождения Маяковского
Ретро-фестиваль
патрулировани москвы-реки
безопасность отдыхающих
Отдых в Звенигороде
Супоневский лесопарк
Фестиваль радиоуправляемых гидромоделей
пушкинский аварийно-спасательный отряд
пожарные приключение
пушкинское умвд
ночь в парке бронницы
альтернативный рок в бронницах
бронницкие музыканты
сергиево-посадский муниципальный оркестр
спатакиада
IV железнодорожные игры
анжелика варум
серебряные пруюы
серебряны пруды
спорт в реутове
детский сад реутов
реконструкция проспекта мира реутов
проспект мира реутов
капремонт воскресенского колледжа
капремонт дома воскресенск
Павлины
Ликвидация подтоплений
переработка вещей
омвд россии
гимназия 8
власиха дип
раменский
ремонттеплоснабжения
Химводосток
летние трудовые бригады
центр воспроизводства редких видов животных
капремонт парка
тропический дождь
100 лет художнику
мцд павшино
Откачка воды
судомодельный спорт
санаторно-курортное лечение детей
последствия ливней
русская народная культура
многодетная россия 2025
детский сад раменский
ЧП Балашиха
бетонные плиты у дк кучино
новый фок в раменском
бассейн в раменском
аномальный ливень
помпа
колокольный звон
раменские звоны
ЗаменаТрубопровода
КоммунальныеРаботы
Евразийские игры по конному спорту
летняя смена
Хк атлант
защита от кибератак
Устранение последствий ливня
новинка
Личный прием населения
Организация досуга
частный дом
уличная поэзия
голштинская порода коров
дубна инициатива
снт овражный
Серебряный звон
Фестиваль звонарного мастерства
Личный прием в Ершове
Фестиваль Дмитровская горочка
чернореченский лес
ремонт баскетбольной и волейбольной площадки в пе
подтопление авто
автоэлектрик
спасение машины-утопленника
Монтаж пролета
Шатура новости
Новости шатуры
Шатура больница
лодка в форме сердца
романтика
Устранение последний непогоды
компания автотранссервис-16
перевозки детей
аренда автобусов
свадьбы
корпоративы
перевозки льготных категорий граждан
сообщество кашеварочка
язвище
Особаяэкономическаязона
разрушенный мост
Последствие стихии
ПСКФармаДубна
школьника
Медсанчасть9
Деньмозга
морг
север
поселок зеленый городок
олегсотник
Строительство надземного перехода
очистка проезжей части
увлажнение дороги
содержание региональных дорог
уборка дорог местного значения
благоустройство двора на улице советской
власиха участник сво
7 школа
пристройка 1500 мест
Первый кулинарный
Альфа Шеф
власихе теплосеть
власиха площадь дк
менделеевская набережная
капельницы
производствокапельниц
формовочная стрижка
фок мелодия
ремонт моста в воскресенске
волонтерский корпус
ск рф
стройки одинцово
подземный переход раменское
ремонт привокзальной площади
фармакологическое предприятие
строительство предприятия в воскресенске
умный дк
зарядка в парке
тренировки на свежем воздухе
Фестиваль долголетов
детский лагерь наро-фоминск
ю-лыткарино
light industrial
складские помещения
склады
дерматоскопия
городок здоровья
Синьковская плотина
заовражье
долгострой подольск
вишняковский пруд
Соревнования по гребному слалому
новые школьные автобусы
хранение автобусов
техобслуживание
техосмотры
постановка транспорта на учет
благоустройство подольск
Установка ливневки
Снятие асфальта
день флориста
мбу содержание и благоустройство
сергиевская игрушка
музей игрушки
институт игрушки
реставратор
вторая лига
Кошелева
Шатура 2025
Шатура в лицах
омон пересвет
отряд омон
летняя спартакиада молодежи россии 2025
соревнования по вольной борьбе в спорткомплексе б
библиотека розанова
михаил горский
фестиваль уличного кино
улица нати 4
ремонт фронтонов
депутат анатолий чугаев
школа 6 подольск
капремонт школы 6 подольск
зарайску 879 лет
Мастер-классе
благоустройство парка подольск
чемпионат россии по гребле на каноэ и байдарках
гребля на каноэ и байдарках
усадьба подольск
пристройка к школе 29
санитарная обрезка кустов
санитарная стрижка
новый скейт-парк
мясокомбинат клинский
Единый день профилактики
дк талицкий
деревня заовражье
хьюман стори
сап-серфинг в бронницах
активный отдых на воде в бронницах
Грибцово
подростки на уборке
центральный теплопункт
наталья курышева
дарья кравцова
моремедиа
Шатура образование
Шатура школы
Шатура искусство
Авария на кнс
арт-студия эскиз
Мотовернисаж
день памяти детей донбасса
вышивание
плетение
поделки из глины и бересты
изделия из соломы
искусства и ремесла
исторический тир
песни и танцы
фольклорные коллективы
надувные горки
батуты
реконструкция молодинской битвы
квесты конкурсы викторины
Олимпиада по физике
Кануполо
Суперкубок
Суперкубок по кануполо
авиатор
кононенко
Василиса прекрасная
фестиваль военно-патриотической песни
первенство россии по гребному слалому
кубок сильнейших
каяк-экстрим
экстрим-слалом
Яяпродажа арбузов в бронницах
звездное лето в подмосковье
дачный театр
театр фон мекка
дачный поселок
сезон дынь
замееа теплосетей в воскресенске
мастер-класс по джиу-джитсу
СВО гомунитарка
Деревнякошелва
скачки
ипподром
поликлиника красногорск
наркологический центр красногорск
капремонт воскресенск
площадь победы раменский
подмосковный врач 2025
городской парк раменский
новая школа в раменском
ремонт детской площадки
Тепло в дома
Единый центр приема и обработки обращений жителе
мособлтепло руза
котельная руза
скейтпарк красногорск
монтаж оборудования
паспорт рф
дк власиха
ремонт тротуаров и съездов
кадастровый учет
постановка на кадастровый учет
алешинские сады
поселок имени воровского
Фестиваль ретро-авто
Запорожец
Новое освещение
день памяти высоцкого
мокрое валяние
солнечногорский оберег
больница на Батырева
деревня смирновка
Шатура дороги
центр беригиня
проект первого канала
улица чехова 4
восстановление покрытия
обрезка веток
сезонный маршрут автобуса
чемпионы россии
Селоновоникольское
Газос
центр образования для детей и взрослых
гонка героев 2025
дошколята перспективы
занятия для детей
Личные прием
Люли Звенигорода
проспект мира
карманы
поваровская школа
реконструкция темлосетей
КартаДубны
Работа подростков летом
хирург-аритмолог
Модернизация коммунальной инфраструктуры на 2025
мособлтепло
ремонт крыши гимназии
ремонт кровли гимназии в бронницах
переход домов в другую ук
уборка подъездов и дворов
Лето в шатуре
поликлиника сапроново
Авария на сетях
Утечка холодной воды
малеево
грейдирование
героям сво
центр помощи бездомным животным
поселок васильчиново
Якимовка
Уборочная 2025
выставка следственного комитета
райдер
международная смена
агротехнологии
гидропонная установка
микроклональное размножение растений
растения из пробирки
дорога к храму
атмосфера фм
лучший
школа села новый быт
перевозка школьников
администрация чехова
поддержка правительства подмосковья
красные орлы
робот-бариста
Реставрация Успенского собора
Памятники истории
Успенский собор на Городке
хранение
художникидубны
первый кадетский казачий корпус
торговая палатка
Капитальный ремонт школы во Фруктовой
роддом мишутино
вертикальные роды
естественные роды
оперативные роды
кесарево сечение
коноплеводство
военные артефакты
силовое троеборье
выездная администрация в белоозерском
встреча с жителями воскресенск
мастер-класс от десантников
мастер-класс по сборке парашюта
смена в лагере
река торгоша
тураково
Подарок жителям города
надписи вандалов
остановка молодежная улица
йога в пехорке
пехорка парк
пивоварня
рок музыка
трибьют
день дружбы
Ремонт в школах
Благоустройство школ
Бульвар художников
сухановский пруд
власиха ск рф по рвсн
жилка
власиха дошколята
заготовка сена
заготовка сенажа для коров
Богослово
малая эстрада
Троутары
парки видного
улица чехова 8а
пристройка на 550 мест
удаление старых конструкций
ликвидация второй смены
согласование проекта
школьное поле
застройка
подземный переход
Роды в скорой
Фельдшеры
Скорая помощь подольск
михнево
пожар на флерова в Балашихе
большая эстрада
малино
Собачья упряжка
Зооцентр
Большие жеребцы
световой фонтан
Медаль за помощь фронту
строительство теплосетей
хк балашиха
турнир александра овечкина
строительство блочно-модульной котельной
теплоснабжение в бронницах
Сыр пир мир
власиха каток
гребля на байдаруах и каноэ
большая волга
ремонт перрона
целевик
ЗооцентрЗооцентр Святополе
Зооцентр Святополе
сезон бахвевых
разывалы
квартира детям-сиротам
вручение ключей от квартиры
квартира сироте
День города Талдом 2025
коломенское поле
газификация завода
Выставка в память о пргибших участниках СВО
Библиотека села Ершово
Егорьевск новости
ДПД
школа в микрорайоне центральный
ситиборды
армлифтинг
башмет
Фестиваль Поле Фолка
пожар в доме на флерова
собаки в добрые руки
новый дом для животных
кубок московского моря
День города талдом
Талдом день города
Талдом день здоровья
хор радуга
коллектив солнышко
лавка миров
наталия островская
30 лет
ансамбль песни и пляски
йога на сапбордах
йога на воде
пропала собака
теплосети руза
спорт в красногорске
волейбол красногорск
волейбол павшинская пойма
музыкальная школа красногорск
детский сад в красногорске
образование красногорск
расселение бараков дубна
расселение аварийного жилья дубна
фап судниково
народная
детский сад 5 волоколамск
капремонт детского сада волоколамск
котельная сычево
новая котельная волоколомск
реставрация старинного дома волоколамск
ремонт путепровода волоколамск
путепровод ждановское шоссе
больница в ольгино
больница балашиха
Фестиваль SMP ESPORTS
CyclingRace
аниме фестиваль
поле фолка
пелагея
этностудия
этносфера
вдоме
туда-сюда
хор широкий дон
этноколлектив
русло реки Закза
очистка озера власиха
коммунальная служба власиха
мир профессий
Новый аппарат УЗИ
новая подстанция скорой помощи
строительство больницы в ольгино
блочно-модульный тепловой пункт
власиха бтп
новый бтп
заозерный бтп
специальсноть
Стадиондлявсех
Гимназия3Дубна
Сырный фестиваль
приемная кампания в раменском колледже
каширский наличник
стародачное кратово
новая экскурсия
велосипедная экскурсия
Школьная столовая
капремонт дома балашиха
Хорсека
капремонт гимназии балашиха
детский сад в балашихе
ярыгино
резиденция керамики
посадская усадьба
школа керамики
михаил бывших
фарфор попова
бульвар космонавта сереброва
лабораторный стол
класс химии
новая котельная в наро-фоминске
администрация долгопрудного
практика студентов медиков
цдк серебряных прудов
детский лагерь колобок
эвакуационные тележки
школа на крупской в балашихе
школа 32 балашиха
Звенигородские новости
микрорайон восточный серебряных прудов
Ремонт жд станции
Станция Осеевская
памятник родителям сергия радонежского
ремонт теплотрассы дмитров
ремонт библиотеки в наро-фоминске
книгополис
чтение-свет
Остеопороз
Ликвидация последствий ливня
фестиваль непреклонный возраст балашиха
финалист телеигры поле чудес василий строилов
елькино
кусты
Автомобильные дороги
победитель телеигры поле чудес василий строилов
отдельный вход в стоматологическую поликлинику дл
водозаборный узел дмитров
первенство мира по тяжелой атлетике
операция поток
Освобождение Курской области
снос дома
Реконструкция контейнерной площадки
медики власиха
студенты медики
поликлиника власиха
детский садик 22
школа полет
Клубничное поле
Строиетльство школы
Берег добрых дел
социальный цетр
тензор
кинопоказы под открытым небом
школа в истре
образование истра
больница в подольске
медицина подольск
Шатура сво
снт коммунар
песчаный оползень
Киевская трасса
озеро солнечное
озеро гидра
пробы воды
экологические игры
новый мост в дмитрове
мост через канал имени москвы
мотопомпа
перепись воробьев
пункт обеспечения транспортной безопасности
уличное искусство
завод фруктовых наполнителей
предприятия серпухова
улица фестивальная
завод аграна фрут
травинское озеро
Травинская набережная
Берита
Цех по производству кормов
Корм для собак
корм для кошек
флости
Микрорайон Дзержинец
новый тротуар в поселке ильинский
подготовка школьных автобусов к новому учебному г
места для инвалидов
новая котельная шаховская
Пешеходный мост
Мост над железной дорогой
Первооткрыватели
Инклюзивный центр
благоустройство территории в балашихе
дип подхожее
врачи спасли
перелом руки
подготовка школ
цветной бульвар
безопасность в городе
детский сад бронницы
готовность детского сада к новым учебному году
подготовка дошкольного учреждения
Обновление фасада
Федеральный научный центр овощеводства
Новые сорта и гибриды
декоративная капуста
новый клуб
зеленая энергетика
осетровые рыбы
Можайский производственно-экспериментальный завод
восполнение популяции
новый педиатр
Шатура МЧС
Фестиваль рыба моей мечты
новый учебных год
готовность школ
Фестиваль рыба мечты
ремонт спортплощадок
2025 учебный год
международный день кошек
студенческое авиамоделирование
встреча с сотрудниками всероссийского центра кара
съедобный город
диктофон
инди рок
детский рок
детская рок группа
рок школа
учебный год 2025-2026
футбол шоу
Школа средняя
Ремонт школы в поселке северный
дип на првомайской
День офтальмолога
Квашенки школа
Село квашенки
поликлиника в видном
медицина видное
водоотведене
перинатальный центр видное
новый корпус перинатального центра
Шатура благоустройство
проверка школы
Новый дом в Зарайске
Жилье для переселенцев
Выездная администрация шатура
школа малая дубна
Гимназия11Дубна
адаптивный спорт
стрельба для слепых
биатлонный комплекс
электронная винтовка
биатлон для слепых
Тренировка для участников СВО
паралимпийский биатлон
новая школа в ленинском
Реконструкция гимназии 3
Школа в Мендюкино
Готовность школ к учебному году
стадион русич
реконструкция стадиона русич
детский сад 11
детский сад орехово-зуево
рыболовская школа
капремонт рыболовской школы
подготовка гимназии к новому учебному году
Вручение собаки
Оборудование кухни
100 свирская воздушно-десантная дивизия
минералы
ремонт столовой в новохаритоновской школе
Фигуры школьников
ремонт образовательных учреждений округа
благоустройство территории второго здания гжельск
Лингвистическая школа
рекорд европы
парк в орехово-зуево
благоустройство орехово-зуево
детский сад кораблик
жилой комплекс бригантина
заводской район
пристройка на 1300 мест
родительский комитет
рецепт лицея в орехово-зуево
спорт в орехово-зуево
привокзальная площадь орехово-зуево
Пространство
Спектакль на воде
День физ
Талдомский
Всероссийский день физкультурника
Фестиваль от пожарных
Крылатое сердце России
Чемпионат русских троек
марш троянцев балашиха
стальная сотня
мотоджимхана
зарайску879
Мчсталдома
гагино
федор шаляпин
шаляпин-фестиваль
федор шаляпин и иола торнаги
венчание
михаил брызгалов
татьяна маврина
ретро-вечеринка
старинное село
День города Зарайска
Соревнования по конному спорту
Кубок главы по конному спорту
звук
Благоустройство детских садов
Ресонт детских садов
Гимн ссср
Песни великой отечественной войны
Подольские просторы
попкорн
договор соцнайма
новые тротуары и проходы
всероссийский центр карантина растений в раменско
новые феромоны для насекомых-вредителей
школа 34
фгос
34 школа
алкоочки
водители автобусов
пьяный водитель
интерактивные доски
Пушкино 100 лет
институтская часть
Гриль-лодка
Обновленный лицей
гумпомощь на сво
Сборка мебели
Луховицкие аграрии
муляжи детей
образрвание
школа 18 агрогородок балашиха
экскаватор
косилка
интерактивные панели
сверлильный станок
верстаки
кроссовые мотоциклы
Благоустройство газонов
котельная на октябрьском проспекте
Наро-фоминская прокуратура
Дистанционное мошенничество
уборка помещений
Реставрация музыкальной школы
Капремонт музыкальной школы в Зарайске
Восковые фигуры
Хвостатый актер
Собака-актер
Собака на сцене
развивающие комплексы
сектор для прыжков
газоны
fight family
пожарно-тактические учения
карп
активист
дом для уток
кувшинка
благоустройство северного берега озера борисоглеб
жилой комплекс государев дом
Математические классы
капремонт подъездов в Балашихе
министерство образования мо
1 сентября 2025
парусник
диспансер
Лесная опушка
пешеходынй переход
дети-пешеходы
макеты
авиастроение
пожарный гарнизон
яндекс вектор
автоматизация
цифровая трансформация
старая гостиница лавры
проспект красной армии
вокзал дубна
огэ оияи
фасадная плитка
Готовность100
НовыйУчебныйГод
улица чехова 45
спортивная и детская площадка
поле для баскетбола и мини-футбола
качели горки лазалки
сквер на крупешина в балашихе
оц лидер
Обращение к главе округа
назарьевская школа
Лучшие учителя Одинцова
Топ-100 лучших учителей Подмосковья
Педагоги России
внутренние и внешние коммуникации
туалеты
отделка наружных стен
улица калинина
колонтаево
чествование лучших работников строительной отрасл
капитальный ремонт образовательных учреждений окр
красный октябрь
Запрудня водоснабжение
Никольский храм в Кузнечиках
Обновление крыльца
учреждение культуры
новая рига
Обновление пушкинской площади
замена труб отопления и ГВС
маршрут 348
автобус 348
адаптивный бокс
спортивные волонтеры
школа спортивных волонтеров
ниу мэи
Выездная администрация квашенки
софьинская школа
малазийские пчелы
манука
пасечник
пуско-наладочные работы
котобус
Раскрытие женственности
плодопитомник
репродуктор
птицекомплекс
акция собери ребенка в школу
отопительный сезон 2025
макеты школьников
спасение утопающих
озеро пионер
Северный подъезд
улица чехова 20
качели горки карусели лазалки
мягкое резиновое покрытие
лавочки и урны
дома культуры
Назад в СССР
отопление мкд
никоновское
очистные сергиев посад
биологическая очистка
процедурный кабинет
Прополка клумбы
Уход за цветами
карачарово
станция водоочистки
усадьба барятинских
теплосети видное
День поля в Зарайске
Праздник сельского хозяйства
ремонт дороги орехово-зуево
ремонт А-108
гимназия 5 дзержинский
образование в люберцах
поликлиника в дзержинском
медицина в люберцах
благоустройство сквера имени Громцева
благоустройство дзержинский
проверка школьных автобусов
дк русь
ремонт проезда
улицы елецкая и ступинская
сделать переходное или твердое покрытие
коллективное обращение жителей
100 процентов креатив
скатная крыша
березнецово
стропильная система
фестиваль 100 процентов креатив
проспект победы
модернизация теплотрассы
траншеи
подготовка оснований под трубы
песок и грунт
установка дорожных знаков
дергаевский проезд
открытие школы
лингвистика
магистры русского языка
оц старт
вакцинация животных от бешенства в Балашихе
макет ребенка
подвал многоквартирного дома
Обшество
тротуар на улице серова
Юрий Башмет
улица серова
ремонт плотины
подарки от губернатора
пилигрим
строительные станки
Концерт Чайковского
школьники на дороге
безопасный переход
павел флоренский
йод
отец павел
архитектор кекушев
музей павла флоренского
фарфор флоренского
пластмасса флоренского
карболит
мощи сергия радонежского
квд
машино
машино-дубки
Водно-моторый спорт
Мотолодки
конюшня пелагея в балашихе
гжельфест
Поместье Клу
Белая чердачная барахолка
Барахолка
фотосушка балашиха
парк пехорка балашиха
конный театр
трезвый
исторические реконструкции
Шатура строительство
жк егорово парк
военно-историческая реконструкция
антон макаров
Микрорайон ДЗФС
Минжилполитики
Внуковский пруд
Акция Чистый берег
лыткаринская больница
школа в сухарево
образование в мытищах
спортивные залы
читальный зал
чистка окон
детский сад в жк новая алексеевская роща в балаших
комбинат по благоустройству
гидравлика
ремонт зданий образовательных учреждений округа
модернтзация первичного звена
мытищинская теплосеть
конно-спортивный клуб пелагея в балашихе
События Звенигорода
Афиша мероприятий Звенигорода
Аршин
Беспилотник для аграриев
женщина герой
жена участника сво
предпринимательница
небесные явления
персеиды
лунное затмение
лицей имени Стрельцова
День самовара
Создатель комиксов
старое симферопольское шоссе
ремонт шоссе
город наро-фоминск
школа N 1
наро-фоминская первая школа
приют бездомных животных
нижнее шахлово
малая катанинная
Ск труд
ЦДОДружбаДубна
Олег чернов
рейд ребенок пассажир в балашихе
госавтоинспекция балашихинское
колокол
Клуб Паралет
Аэродром возле Батюшково
День воздушного флота
восстановление часовни
Приоброжение
урна
лавочка
камера видеонаблюдения
кастомная одежда
модельер
театр фэшн
вторая международная выставка ассоциации производ
Тактильный мастер-класс
семинар по работе в непригодной для дыхания среде
тураево
библиотека им Ф И Тютчева Балашиха
выставка Балашиха в лицах
центр помощи участникам сво
молодежная площадь
реконструкция площади
Горячая линия в новой школе Зарайска
Волнующие вопросы
родные-любимые
мелотрия
ремонт клуба
новая школа зарайск
очистка Островецкого озера
экология люберцы
спорт в люберцах
новая школа в жулебино парк
новая школа в люберцах
встреча с работниками раменской больницы
Школа вербилки
Туламашагро
Уборка рапса в Зарайске
фестиваль огородников
шаховская школа
Ашукинский образовательный комплекс
резевное питание
грейдирование гравия
Школа П северный
Музей в школе
турция
автопутешествие
качество питьевой воды
комортная городская среда
Всероссийская Федерация самбо
собери ребенка в школу балашиха
капитальный ремонт стадиона
можайский приют бездомных животных
парк сказок
школа в жк приображенский парк
новая школа домодедово
школа в барыбино
образование домодедово
школа в климовске
образование в чехове
ммр
озеро ммр
теруправление наро-фоминск
модернизация системы освещения
городское освещение
питомник агрофирмы поиск
крансая пойма
Угольная улица
крис кельми
алексндр волкодав
аллея памяти футболистов
бмк
столярное мастерство
столярка
Директор года 2025
музыкальный сезон
доллежаль
сош 9
замена радиаторов отопления
благоустройство школьного двора
стадион орион железнодорожный
открытыйДК
культураподмосковья
Образование Красногорска
звонки и сообщения
Электроподстанция
Депо
обновление пищеблока
поле многодетных
поселок для многодетных
Ипотека
Детсады
поселок измайлово
капремонт котельной
безопасный пешеходный переход
безопасное дорожное движение
творческий мастер-класс в туристско-информационно
Школа интернат запрудня
Поликлиника Зарайска
Подъезд к дому
шоколадная паста
установка ограждений
покраска ограды
спортивные комплексы
smp racing
Поселок Останкино
моссмп
смп рскг
гоночный уикенд
Библиотека Ершова
Афиша мероприятий Заенигорода
Эко-парк Рождествено
КФХ Юрко
День флага РФ
рп Октябрьский
День варенья
порк
питбайки
УМЦ авангард
Патриотический форум
деревня ельня
моей родины триколор
Теплоснабжения
роман пичугин
русская хтонь
Балашихинский художественный союз
Звенигород православный
верблюд
сборка
винтовка
головоломки
игроки
Братья Сафроновы
Маги в парках
День города Запрудня
творческое сообщество энтузиасты
фестиваль животных
ремонт дороги зарайск
Новостройка в ДЗФС
соревнования собак
школа в ЖК Митино О2
строительство корпуса к лицею
строительство пристройки к лицею в бронницах
кинокнижный клуб
молодежь в культуре
молодежный совет в музее
новые пешеходные дорожки и тропинки
новые автостоянки
улучшение наружного освещения
места для занятия спортом
журнал
том
Укусы клещей
ткани
бесплатный кинопоказ
уборка и вывоз веток
содержание дорог и дворов
удаление сухостойных деревьев
Рошаль благоустройство
ту-214
туполев
декоративное искусство
бессарабова
гжельские мастера
данила нуриев
обладатель жилищного сертификата в балашихе
новое оборудование в мастерских колледжа бронниц
Автомобильно-дорожный колледж в бронницах
подготовка колледжа к новому учебному году
окрасочно-сушильная камера в бронницком колледже
коммунистическая улица
русроза
цветочный питомник
граждане России
робот-мойщик
благоустройство пришкольной территории
парты
Создание зинов
поликлиника на улице пионерская 4
главный врач Андрей Попов
личный прием жителей
изменение графика приема
проект навстречу здоровью
дни участковых врачей
диалоги о здоровье
запись к врачам
прикрепление к больнице
расширение федеральной трассы
готовность детского сада к новому учебному году
дошкольное учреждение бронниц
детский сад бронниц
комплект эмбрионов
мчс россии 35 лет
франция
Школа 20
прокуратура серебряных прудов
коммунальные работы
союз предпринимателей
индивидуальный предприниматель
интервидение
лекции для пациентов
штат
качели карусели лазалки
микрорайон южный балашиха
площадка для выгула собак в микрорайоне южный
Тропа Боевого братства
пилот бпла
фокусы
идн
теннисныекорты
Теплоснобжение
Запрудня теплоснобжение
Чемпионы мира по плаванию
КББХ
Вид города
Сплрт
МУП ДУ ЖКХ
Диспетчерская теплосервиса
рейтинг лучших школ подмосковья
раменская гимназия 2
адаптация участников сво
лицей 4 в Люберцах
поликлиника микрорайона Зенино
Северное лето
Выездная администрация подольск
Архив министерства обороны
лекарственная терапия
трудоустройство медиков
экспресс-тестирование
пса
гжельский фарфоровый завод
новые теплокамеры
тучово
строительство лукодрома в бронницах
лукодром бронницы
молодежный проект
новый учитель начальных классов
КНС в поселке Останкино
тревелшоу
валерий харламов
усадьба горенки балашиха
артефакты тамары елагиной
новые автобусы в никитской школе
перевозка детей в школу
улица мира 7а
меню в столовой
новые блюда
текущий ремонт помещений
оборудование и мебель
директор гимназии елена рубцова
педагоги и учителя
Бизннс форум
Предпринимательницы
новая парковка у школы
расширение парковки в бронницах
класс
обновляют зебру
Операционный микроскоп
Аэропорт Шереметьево
турнир московской области по художественной гимн
модернизация стадиона
Выставка зарайского художника
Алексей Раскин
Музей Бахрушина
парки подольска
встреча с жителями в школе 10
сшор труд
взу на свободной
строительство нового взу
новый корпус школы в подольске
библиотека им Есенина
реконструция парка
деревня веселево
Звенигородский музей-заповедник
МЧС учения в школе 11 в Балашихе
Подольский троллейбус
школьный стадион на улице левченко
вакцинация детей от гриппа
прививки от гриппа
вакцина ультрикс квадри
прием педиатра
безопасные и эффективные прививки
дни здорового ребенка
предварительная запись
сельскохозяйственное предприятие в бронницах
выращивание быков
закрытие смены
Мост на Московской
Директора школ
Всероссийские антитеррористические учения
педагогический класс
Соколка
Микрорайон Внуковский
Спортивная 7Б
производитель восстановленных шин
установка фонтана
плавающий фонтан
новый фап в Дубках
новый учитель истории и обществознания
в школе имени Тимофеева новый учитель
Лапароскопическая методика лечения
встреча жителей с урологом
экспресс тесты пса
анализы крови
главврач чеховской больницы
консультации
чемпионат мира по самбо
ОбразцовыйколлективКалинка
детскоетворчество
Шатура ЖКХ
ГП 2 балашиха
поликлиника 2 балашиха
кабинеты грудного вскармливания
успение пресвятой богородицы
Августовское совещание
всероссийская антитеррористическая тренировка
водородные технологии
графен
электролиз
улица свободы 6-10
новое село улица ленинская
муниципальная экологическая программа
новая школа в балашихе
школа в жк героев
детский сад 4
новый подрядчик
распределение детей
текущие вопросы
Подъезд-музей в Зарайске
ИИвОбразовании
Школа2
виртуальные декорации
моушн-анимация
новый компьютерный класс в колледже
it обучение в бронницах
новое оборудование в колледже бронниц
заочье
Шатура ЦРБ
Шатура медицина
депутат госдумы александр коган
помощь многодетным семьям
материальная поддержка
школьные принадлежности
Новый врач-эпидемиолог в Зарайске
дети врачей
школа пушкино
новая школа в жк новое пушкино
городок сенеж
тимоновский мост
Команда весна
Деревня Михайловское
маршрут 1224к
маршрут 33к
изменение тарифа
Профессиональный колледж
элекстросталь
макет школьника
Аттрактор волны горения
новая школа в лыткарине
текущий ремонт спортзала
обновление системы отопления
новые радиаторы отопления
покраска стен и потолка
школа 1 в королеве
собери ребенка в школу бронницы
выставка икон
необычное хобби
портретник
портретный репортаж
новая школа в ступине
школа в долгопрудном
образование в долгопрудном
школа в ногинске
очистка Ваулинской плотины
школа в балашихе
НиколовПеревоз
Всероссийскийтриатлон
будильник
Раменский музей
Город профессий
авиаторы
театральныйфестиваль
фестивальМост
фестиваль область танцевальных культур в балашихе
новые музыкальные инструменты
фестиваль иллюзионного искусства
Стрим с родителями
Троллейбусы
Солнечный
День города северный
улица уездная 6
готовность к новому учебному году
первый заместитель главы округа
денис юрков
директор школы 10 константин значков
филиал Рошаля открылся
Новая больница в Одинцовском округе
Больница в Ромашково
Камерная сцена
обновленная гимназия 1 в балашихе открылась в день
школа 32 в балашихе открылась после капремонта
АНО Футбольные мамы
молодые педагоги Подмосковья
школьная история
школа креативных индустрий
Обновленная школа в Монино
гимназия 2 раменское
дамские рукоделия
новый учитель физкультуры
Кирилл Ротастиков
поддержка молодых учителей
Белоомут Школа 1Сентября Капремонт Образование
Первый раз в первый класс
Андрей Воробьв
день знаний в парке
шашки в бронницах
площадка для воркаута на Гурьева 13
университетДубна
новый корпус 4 гимназии
коренево
школа 28
4й лицей
абвгдейка
Кино-театр студия
ЖКХ Одинцовского округа
Сурмино
мчс 35 лет
биг-бен
англия
строительство теплосетей в бронницах
Волрнтеры
Поисковый отряд Русичи
Северный рубеж
новая школа на 550 мест
камеры
вакцинация от бешенства в балашихе
никольско-архангельский парк балашиха
Детский сад Звенигород
Благоустройство дктских садов
поваровская поликлиника
улица уездная
заместитель главы округа александр ротнов
пешеходныепереходы
макетынапереходах
открытие школы после капремонта
стеклянная остановка
3 сентября
Благоустройство детского сада
Ремонт детских садов
головачево
Юбилей театра
Память Беслану
день города видное
оборона
деоевня поповка
Легенда Коренево
95-летний юбилей
Долголет Зарайска
год лошади
Центральный дворец культуры
Дом Милютиных
замена мусоропровода
Эндоскопическое оборудование
Обновлениезалафехтования
прием жителей заместителями главы округа
Вильям Похлбкин
улица гагарина 56
специальные панели
региональная программа Московской области
краткосрочный план ремонта
35 лет мчс
школа ВМ Комарова
Модернизация поликлиники
Освещениедороги
Новыефонари
эпидемиология
отделка фасада
ремонт входных групп
облицовка ступеней
ремонт и обустройство объектов здравоохранения
ПамятьБеслану
сварочное оборудование в колледже
Строительство канализации
Канализационная сеть
строительство тротуара к детскому санаторию в кра
сезонная вакцинация
памятник герою сергею ивановичу солнцеву
дерево памяти
борьба с терроризмом
библиотека Бригантина
дом для переселенцев зарайск
ремонт стадиона в зарайске
музыкальная школа в зарайске
Ассоциация ветеранов СВО Зарайск
Движение первых Зарайск
улица мира 4а
дирекция заказчика капитального строительства
Запрудня дк прогресс
Мальчик в полосатой рубашке спектакль
Усть-Пристань
новые мафы
Благоустройство Талдом
новый учитель математики
фармация
строительство производственно-логистического комп
Водосток в МКД
улица солнышевская
встреча с пенсионерами и ветеранами
заместитель прокурора роман нагаев
помощница прокурора екатерина сикорская
борьба с телефонным мошенничеством
уловки и схемы обмана
способы защиты от мошенников
чеховская прокуратура
препарат
мир без пожаров
люберецкое общество инвалидов
замена трубопроводов
новый врач-хирург в бронницкой больнице
новый хирург в бронницах
безопасность на дороге
строительство мемориального комплекса
военная техника в бронницах
новый мемориальный комплекс
открытие сквера по улице крупешина в балашихе
сквер мфц
цк акрихин
15 лет театру
набор в кружки
Шатура прокуратура
юридическая помощь участникам сво
реки бегут
группа диктофон
звукозапись
Промзона зингер
модернизация детских площадок
ремонт теплосетей в ступине
технолицей в истре
кампусы в технолицее
дорога в павловской слободе
народные ремесла
готовка блюд
цирковое шоу
альпаки
цирковые номера
чеховская кухня
розыгрыш призов
стрелецкий лагерь
конница
кузня
лучный тир
казачий круг
фестиваль казачий круг
дворец культуры имени воровского
яхтинг
африканские барабаны
реки россии
центр спецподготовки Витязь в Балашихе
служба по контракту
День города в Балашихе 2025
парк пехорка в балашихе
Осень в Рузе
Фестиваль осень в Рузе
авиашоу
пилотажная группа
аэродром мячково
мячково
пилоты
верхнее мячково
авиационный форум
выставка самолетов
Добровольная пожарная бригада
выставка мчс
Ярмарка рукоделия
Дорога в Жилконцах
Модернизация очистных сооружений
Современные очистные сооружения
ПЧ-39
Футбольное поле с подогревом
папа может
профессия пожарный
рижский сквер
региональные трассы
строительство сквера в бронницах
новое общественное пространство в бронницах
Жонглирование мячом
воркаут площадка
Образовательный кластер
Савва Морозов
Поликлиника Талдом
диспансеризация Талдом
капремонт синтез
Котофей
Егорьевск обувь
Талдом теплосети
Талдом благоустройство
Алина Романова
садовод-любитель
тротуарная астрономия
кровавая луна
теннисбольшой
ремонткортов
Памятник воинам хлопчатобумажного комбината
ремонт подъездов в бронницах
изделия
Фестиваль Сказки старого города
новыетротуары
Образование шатура
экстремальный спорт
утварь
корзина
выставочные залы
грибники
беседы
серебряный призер всероссийского чемпионата профе
Театр моды эксклюзив
заготовка кормов для коров
сбор кукурузы на силос
сельскохозяйственное предприятие бронницкий
цкии
Леонтьево
новые спортивные площадки
улица чехова 73
горки качели карусели
лавочки урны инфощиты
видеокамеры системы безопасный регион
Ядонор
ДонорствовДубне
Звенигород спортивный
ремонт детской школы искусств
ао евросервис
реконструкция дома культуры
королева шарлотка
благоустройство сергиев посад
новый учитель физики
Театр Мечты
Школа Мечта
автомобильные проезды
дровосеки
Котельная мишеронский
Дом культуры Ивантеевка
Акватермальный комплекс
железная бабушка
художникик
вторая всероссийская летняя спартакиада по спор
учебная пожарная тревога в школе
учебная пожарная эвакуация
ремонт колодца
истории о животных
варвара кузьмина
классное радио
Безопасность в интернете
новая зимняя горка
горка для катания на тюбингах в бронницах
строительство зимней горки
Дети участники вов
Топ 200
Факты о гриппе
благо твори
собачья жизнь
Театральная лаборатория
улучшение освещения
строительство административно-бытового центра
обслуживание грузовых автомобилей в бронницах
Поселок дубровицы
александр мень
протоиерей александр мень
убийство меня
меневские чтения
михаил мень
студент-участник всероссийского чемпионата профес
стадионвдубне
спортвдубне
дом-музей александра меня
фонд имени александра меня
краеведческий музей на месте убиения протоиерея а
сергиевский храм
кпц дубрава
вакцина против гриппа и пневмонии
театр стаса намина
группа цветы
иисус христос - суперзвезда
рок-опера
парк отдыха
Всероссийская ярмарка
спмз
отдел реставрации
музей абрамцево
музей коломенское
реставрация икон
реставрация картин
рублево-успенское шоссе
раздоры
Бегунья из Подольска
Теплосети запрудня
Шахматист
Кубок Карякина
серпухов парк питомник
реконструкция парка питомник в серпухове
благоустройство в серпухове
Парк Защитников Москвы
ремонт спортшкол
уборка пшеницы
направление
Ярмарка продукции
противодествие мошенникам
Детская больница
метод биоакустической коррекции в бронницах
биоакустическая коррекция в детском саду
Гагарин-трейл
Зарайские спортсмены
Зарайский педагог
новаялестница
турнир по художественной гимнастике триумф
культурная жизнь серебряных прудов
открытия кинотеатра
красный октябрь 47а
Пожар в логоцентре Катуар
ЧП в Некрасовском
прорыв канализации
котельная в подольске
жкх подольск
школа 1 в климовске
лесопарк дубрава подольск
очистные в зарайске
дороги в зарайске
благоустройство в богородском
проспект победы ступино
памятник сергею ивановичу солнцеву
знаменитые могилы
годуновы
могилы лавры
захоронения в лавре
кладбище троице-сергиевой лавры
Калинина
расселение бараков ступино
Игры с мячом
очистные в сергиевом посаде
Лицевые счета
дом для переселенцев ступино
медработники
священники
фермерский комплекс
Пристройка к детсаду Сказка
Отключение электроэнергии
раменская городская поликлиника 1
козырьки подъездов
флюрография
новый учитель в бронницком лицее
новый учитель биологии в бронницах
молодой учитель бронницы
пятиборье спасателей
соревнования спасателей
аварус
кварц
искусственный камень
Интервидение-2025
Венесуэла
Омар Аседо
Внуково
национальный парк
подготовке к зиме
поселок голубое
Мосолблгаз
карина колесникова
заводская улица
станки с чпу
3D-моделирование
резиное покрытие
Аксаковская уха
студентка-участница всероссийского чемпионата про
Медецина запрудня
сельхозпредприятия
сбору урожая
зернобобовые культуры
машиностроитель
Гексакоптер
Выборы 2025
Выборы 2025 Балашиха
Сбор рапса
управление народного образования
отопительный сезон 2025-2026
День парикмахера
подмосковье без границ
игорь гундеров
колясочники
фестиваль равных возможностей
забег на колясках
колесница
новая парковка в бронницах
строительство заездного кармана в бронницах
Новая дорога к новой школе
молодые специалисты в медицине
предварительные топки
турнир по фехтованию
дартц
николай лукьянов
фехтование на колясках
бутрулино
Стилист из Одинцова
Кира Гончарь
довыборы
Арбатский
отсыпка щебнем и крошкой
Татьяна Желтова
заявка на ремонт
строительство теплотрассы Мочилы
выборы в совет депутатов 2025 в Балашихе
клуб атлет
подготовка техники к зиме
насосы
замена и ремонт оборудования
программа модернизации объектов теплоснабжения
монтаж трубопроводов
тпу сколково
live арена
Школьная мебель
Географический коридор
Горького
Новое оборудование в школе
ГИБДД шатура
газификация талдом
Юрий Крупенин
Газ Талдом
Рикки тикки
федор смолов
мастер сатурн
broke boys
трудовой
династии
деревня заболотье улица фрегатная
Шатура выбирает
Общественный мониторинг
Председатель уика
посадский спиннинг
мануфактура попова
Легенда хоккея
вос
Совет по правам человека
мастер-класс по оказанию первой помощи
занятие по оказанию первой помощи в бронницах
картофельный разгуляй
дакс
киноуроки школ россии и мира
василий бегинин
александр богатырев
мудрый пес
светлана телицына
собака-поводырь
черемухин
дтцт юность
ракетомоделирование
мир равных возможностей
спортивные состязания
люди с инвалидностью
Фестиваль желаний запрудня
Фестиваль мыльных пузырей
Запркдня солнечный берег
Павел Максимович
леонид поляков
детские лабраторатории
Брейкинг
Область танцевальных культур
Зооволонтеры
модернизация инженерных сетей
система отопления и гвс
Niletto
Братья Сафроновы в Зарайске
Конкурс иллюзионистов
Шоу братьев Сафроновых в Зарайске
мост через нару
новый сквер лыткарино
пробные топки
сезон тихой охоты
конкурс парикмахерского искусства
дом культуры старт
подключение домов к системе гвс
строительство корпуса лицея
Урожай 2025
Урожай пшеницы
шатура освещение
Образование запрудня
Гимназия запрудня
Точка роста талдом
молодежный субботник в жк березовая роща
тепловодоснабжение
Восстановление территории после ремонта
ремонт дорожного покрытия во дворах
дергаевская 30-32
Кубок Главы
герои подмосковья
гжельская роспись
художники гжели
российский день леса
посвящение в лесничие
обучение служением
добро как норма жизни
Школа квн
внеурочные занятия
кругозор
Дорога в лавру
силовые виды спорта
узуново южный 31
школа 2 в серпухове
котельная холодово
благоустройство улиц в серпухове
школе 1 в серпухове
школа 17 в серпухове
школа 9 в серпухове
школа 6 в серпухове
детский сад в серпухове
новостройка в лыткарине
котельная 5
испытания оборудования
жилые дома
замена оборудования
проверка всех систем
жкх в лыткарине
улица молодежная 6а
безопасные игровые элементы
пробные пуски
врезка в систему отопления
Победитель фотоконкурса
Российское географическое общество
вакцинация от гриппа в Балашихе
ФАП в Балашихе
обновленная детская школа искусств в бронницах
новая лестница
самозахват
Расчистка реки
Река Скалба
Теплоснабжение в Талдоме
Талдом подача тепла
Талдом батареи тепло
королевская двойня
дополнительное образование в лицее
центральный парк победы
заготовка урожая
гуманитарная помощь бойцам сво из балашихи
61-й гуманитарный конвой от фонда защита
агрокласс
Гематологическое отделение
Врач гематолог
топки котельных
Новое место для прогулок
робототехника в лицее
трио забава
лучник из Эймсбери
музей толкинистики
Школьные психологи
Генофонд
Клонирование
щекино
стационары
кьюар-коды
коды на дверях кабинетов
отдел качества
обращения пациентов
благодарности
обратная связь
андрей попов
повышение качества медуслуг
Трубино
Реалистичные силуэты
Муляж на пешеходном переходе
Муляжи на пешеходных переходах Зарайска
Пробные топки котельных
фонд александра меня
владимир спиваков
виртуозы москвы
камерная музыка
падел-теннис
командная игра
преподаватель биологии
оргрэс
мостовик
река пажа
капитальный ремонт моста
начало работ
установка новых ограждений
планировка
строительный городок
завоз материалов
устранение второй смены
открытие памятника летчикам 5-ой авиароты
новый памятник в бронницах
наследие империи
планета зож
поколение зож
смузи
ла фреш
просветительский марафон
Микрорайон Кузнечики
школьные обеды
Аграрно-техологические классы
Сельское хозяйство для школьников
Урожай картофеля
Шатура сельское хозяйство
уроженец
Талдом моладеж
Моладежная партия
Общежитие на Бусалова 8
Живое общение с жителями
благоустройство площади
памятник дзержинскому
тц любимый
тульчино
восстановление храма
выездная администрация в балашихе
встреча с жителями железнодорожного
полезные крышечки
Послок Челюскинский
вертолетный спорт
забег ереминой
раменский кобинат хлебопродуктов
добро без границ
движение первых дубна
Подмосковный политехнический колледж
областная больница
точка роста в бронницах
реконструкция трассы м-3
театр ермоловой
данила козловский
олег меньшиков
спектакль чуковский
композиторы подмосковья
класс мчс
юный спасатель мчс
Овощи гиганты
Ботанический сад
мосводоканал
русдент
дроппинг
фестиваль креативных индустрий энтузиасты в балаши
балашихинская хлопкопрядильная фабрика
сообщество энтузиасты в балашихе
мотоциклист
русские мотоциклисты
фестиваль креативных индустрий энтузиасты в бала
день осеннего равноденствия
резчик по дереву
скульптуры из дерева
скульптура из досок
скульптура из горбыля
творческая мастерская
лесной гость
хитрый лис
забелевание
МЧС России в Балашихе
семейный центр непоседы в балашихе
капитальный ремонт перрона
Ремонт крыши запрудня
посадка растений
лечебные травы
Реконструкция Рогачевского моста
Мостоотряд-90
тепло в школах
кибер
дроппер
лесная сказка
красноармейская-михалевича объездной путь
замена котлов
система химической подготовки воды
ремонт и замена оборудования
замена автоматики
ссоциальные объекты
za нашу общую победу
подключение
несанкционированные граффити
ОКБЖКХ
Женщина-герой 2025 полуфинал
женщина-герой 2025
марков лес
решоткино
М4
котлы
модернизация котельных
улиточная ферма
цтп бтп
сестринские посты
выдача справок и направлений
запись на прием к врачу
диспансерный учет
направления на анализы
разделение функционала врачей и медсестер
пробные топки в бронницах
котельная в бронницах
отопительный сезон стартовал в балашихе
школа 11 на шоссе энтузиастов в балашихе
школьная игра
запуск тепла в образовательные учреждения
финалистка конкурса профессионального мастерства
чп долгопрудный
устройство кровли
спас-заулок
планета детства
А-107
расширение м-8
лесной
кощейково
разделительные барьеры
гимназия 1 им героя рф баландина
фестиваль эра дронов
замена аварийного участка теплотрассы
взу клемово
улица полиграфистов
ремонт фонарей
ремонт электропроводки
кск фаворит
сшор пахра
Инклюзия
маша
Прививки от бешенства Талдом
Собаки и кошки
Бешенство прививки
маршрут выходного дня
соц объект
фк знамя труда
фк чайка
отопление соцобъектов
микрорайон Заозрный
бтп Заозерный
всероссийский фестиваль по инновационным видам сп
новый мемориальный комплекс в бронницах
мемориальный комплекс афганская война и специаль
ветераны афганистана бронницы
завод рота-агро
лесное многоборье
юный лесовод
конкурс подрост
слет школьных лесничеств
участки дла многодетных
строительство взу на свободной в серебряных пруда
оздоровительный центр левково
это у нас семейное
сестрорецкий парк
пуск тепла в мкд
котельная в солнечногорске
фильм брат-2
семейный городок серпухов
Фестиваль Конная Россия
демиховский машиностроительный завод
банкомат
экомед
немые свидетели войны
алексей ларькин
лесничества московской области
школьные лесничества
оздоровительный комплекс левково
125 капелле Юхова
Концерт хора
и звезды становятся ближе
конкурс вкс
творчество военных
вейкпарк
вейстанция
фестиваль клевер
досуг для взрослых
трасса м4 дон
День ортодонта
Врач-ортодонт
студентка-финалистка конкурса стилистов звезда es
учения скорой помощи
деревня клюшниково
в бронницах дали тепло
радиоуправляемые модели
препараты от гриппа
совигрипп
флю-м
ультрикс квадри
вакцинация детей
вакцинация взрослых жителей
статистика
интерактивное оборудование
микрорайон полиграфкомбинат
авария на теплосети
утечка теплоносителя
прорыв трубы отопления
устранение утечки
поручение главы округа
Микрорайон Супонево
Ремонтно-эксплуатационная служба Звенигорода
глава люберец владимир волков
Концерт для студентов
отопление в домах
НовыйсквервДубне
Тепло Талдом
Котельная Талдом
улица менделеева
подача тепла в дома
почтовая станция
сквер в шаховской
благоустройство в шаховской
выявление болезней на ранних стадиях
заместитель главного врача
александра мурашкина
новая общественная территория
контрольная выходи решать
Новосиньковские общежития
Крупенин Юрий Васильевич
агролидер
национальная премия
лаборатория безопасности
школььники
открытие нового мемориала на улице солнцева
открытие мемориального комплекса
мемориальный комплекс афганская война и сво в бро
открытие библиотеки
Спортивная площадка в деревне
день воссоединения
Полина Свиридова
Полина Свиридова вошла в книгу рекордов россии
рондат винт
заречный
родительские комитеты
встреча с родителями школьников
обсуждения
доклады
внеурочная деятельность
благотворительные проекты
кружки и секции
лариса сулима
первый заместитель министра образования подмосков
заместитель главы округа
надежда чернятина
ирина заболотнева
Новая стоматология
Медицина в Одинцово
встреча с работодателями
трудоустройство студентов
новый тротуар на улице воровского
Подольск помогает
ситники
лозовское поселение
александр шульгин
стоматологическая поликлиника
врачи-стоматологи
новая клиника
Выездная адмнистрация
Ковчег с мощами
Святитель Тихон
Лор-врач
теплосети власиха
алтстрой
власиха теплотрасса
выставка Кандинского
зарождение
кифато
благоустройство в бронницах
новый сквер в бронницах
новые спортивные площадки в бронницах
Бегунья
питание в садах
зимнее меню
ветхий фонд
гурьева 1г
призыв
теннисвдубне
образовательный форум
гериатрическое отделение
минералогия
утечка на сетях
школа искусств шаховская
российско-китайская палата
Капитальный ремонт дома культуры
Дом культуры им Кекушева
первенство россии по гандболу
загадать желание
беговое сообщество
сергиев трейл
сергиев ран
день пожилого человека в Балашихе
русская атлантида
загадай желание
корги
миссия
день добра и уважения
Дом детского творчества Звенигород
куклы из ссср
неформальное образование в бронницах
бесплатное образование в бронницах
клуб неформального образования маяк
подмосковный институт филиал мади
Филатуризм
Исследователь-путешественник Сушков
Спецгашение марки
Лицей МГИМО
Благоусиройство
Дороги вербилки
Подольский выставочный зал
Моя Русь
всемирный день животных
Остановки талдом
материалы
ивушка
современные технологии
выставка фотографий
новыетротуарывДубне
Дмитровское шоссе
реверанс
обслуживающая организация
проьлема ржавой воды решена
строительство дорог
первенство россии по эстетической гимнастике
юные гимнастки
отравление грибами
консервирование
заготовка грибов
симптомы отравления
деньучителя
частная конюшня
благоустройство конюшни
поздравили учителей
Лопасня
травматологический центр
долгопрудненская больница
донорская кровь
ту наро-фоминск
луховицкая школа 2
отключение фонтана в бронницах
подготовка фонтана к зиме
сухой фонтан в бронницах
православная гимназия
10000 шагов
СШОР Метеор Балашиха
команда из Балашихи стала второй на Кубке России
сломанную тарзанку починили в балашихе по просьбам
Проводы на пенсию
филология
ротонда
день самоуправления в бронницах
день среднего профессионального образования
центральный архив министерства обороны рф
цамо
подвиг подольских курсантов
академия Андрияки
художественная выставка в дк сатурн к 100-летию г
Краснополянский рубеж
топ-5
рейтинг самых зеленых городов
Новый переход
Хронограф
питомник аллейных деревьев в бронницах
экспорт деревьев в бронницах
икона Святая Троица
соревнования по боксу посвященные ветеранам боевых
александр головашкин
каширский резной наличник
пожарники
труд всем
Спартакиада дошкольников
Спортивная дошкольная лига
утечки
Швейная машинка
История Подольска
Сергей чураков
фотограф-анималист
фотограф-натуралист
первозданная россия
фото журавлей
сайгаки
золотая черепаха
Первенство МО по пневматическому пистолету
Борис Крейдлин
Кирилл Мартынов
СШОР Метеор им Елены Донской в Балашихе
Dmitrov Golf Resort
мощи святителя тихона
утечки на сетях
закрытие мотосезона 2025 в Балашихе
мотоклуб белые вороны
бег по пересеченной местности
тропою сергия
добрые прогулки в Балашихе
конный клуб пелагея в балашихе
Полумарафон-2025
сезонный каток
дединовская школа интернат
утилизация электроники
старая техника
школа утилизации электроники
радон
радиоактивные отходы
хранение рао
мини-мотокросс
осенние каникулы
кружки и секции во время каникул
нормативы ГТО
история пациента с редкой патологией
Снос многоквартирного дома
Подсадные утки
Соревнование охотников
Сергиевские игры
роспись по стеклу
медиация
Парк Ежик
детский стоматолог
зубной врач
абрамцевский дуб
Благоустройство запрудня
эгология
ддт1 в наро-фоминске
День рождения дивизии
Поздравление военных
фап в зарайске
k-1
Анна Черняева
Андрей Черняев
строительство тротуара в кривцах
новый тротуар в кривцах
раменскмй округ
Шатура экономика
Концерт вокалистов
Вокальный ансамбль элегия
Запркдня
Корсаков
А-108
Арт-резиденция Гало
ДорогиДубны
Новыйасфальт
Всероссийская просветительская викторина для школь
Лесопарк березки
Теплосети талдом
Талдом благоустро
Запркдня теплосети
Теплотрасса Талдом
русский хоккей
чемпионат московской области по настольной игре
Сергей Грачев
курсант
патриотический марш
детский сад 5 на пионерской
администрация городского округа королев
подпорная стена
7 октября в Доме культуры Кучино» состоялся концер
посвященный 100-летию блаженной кончины Патриарха
техника жкх
промывка сетей
устранение засора
красногорская площадь
старая лаврская гостиница
биография путина
книги о путине
день рождения президента
Синхронистки
Датчики
литературный концерт
поэт деревни
поэт серебряного века
Семейный центр имени А.И. Мещерякова»
котельные в бронницах
цифровые датчики в котельных
Строительство детсада
игры к новому году
строительство участка теплосети
новая теплосеть в бронницах
выставка планета пауков
герб школы
гимн школы
кадетские классы
Анна Шевченко балашиха
рисунок Майкла Лунна на остановке у городской фаб
молодой водитель
ХК зоркий
замена задвижки
Новые технологии в образовании
диспетчерская
цифровой контроль
Поселок Автополигон
выставка восковых фигур
Урок патриотизма
Воссоединение новых регионов с россией
туман
ФИЦ ВИЖ имени Эрнста
социальный раунд засветись гибдд балашиха
Замена коллектора
кросс наций
спортивный бег
Фонда по сохранению и воссозданию исторического о
Копнинка
новыеокнавшколах
выездная администрация в раменском
выездная администрация в ульянино
Служебные собаки
Служба в полиции
Планета талантов
Путешествие по странам
Умные датчики
Мост дружба
Черное озеро
День рождения Лермонтова
новые тротуары в поселке кратово
Дмитровский водоканал
Каналопромывочная машина
Автономная котельная
Система мониторинга котельной
сво музей победы красногорск
сгорел автомобиль
форд фиеста сгорел
семьи сво
храм Воскресения Христова
православный фестиваль
духовная культура
Первенство Московской области по хоккею
центр общественного здоровья и медицинской профил
русский реализм
Головин
станиславский
МУП ЖКХ лесной
Городское хозяйство пушкино
экскаватор-погрузчик
база отдыха
отдых под бронницами
отдых на свежем воздухе
джиппинг
Пушкинский филиал газпром теплоэнерго мо
Московские железные дороги
ивантеевская теплосеть
датчики температуры и давления
Увековечивание памяти
Балашиха переходит на цифровой контроль теплоснабж
цифровые котельные в балашихе
петра и павла
встречи с выпускниками
история успеха
карьера в IT
Одинцрвский округ
Золотые колеса Подмосковья
Врач-невролог
Russian Event Awards
ремонтдорогДубна
ремонтдорогвДубне
новый экскаватор
обустройство зоны отдыха у воды на берегу Борисог
риск-м
капитальный ремонт стадиона
богатые и знаменитые
Умка 2
мурманск
Мисс московская область
Мировые рок-хиты
Асфальтвчастномсекторе
лига героев
изумрудная свадьба
фрирайдер
татарский десант
татарская культура
Агродиктант
НовостиПодмосковья
новые тротуары в деревне паткино
группа мир
помощь при дтп
волонтеры мир
аптечка первой помощи
Филиал МГТУ имени Баумана
Звукорежиссура
груз для сво
из первых лап
передача корма
лекарства для животных
филя
возьми друга из приюта
Мисс квАРТал
Первый партизанский
посвящение в читатели
первоклассники в библиотеке
чемпионат московской области по голболу
пилорама
бруски
парк Островского
остролистные клены
СК Юность
Новый сезон
храм Пантелеймона
Спортсмен-экстремал
дети с овз в серпухове
школа 8 в серпухове
строительство спорткомплекса в школе
Совет Первых наро-фоминск
детское самоуправление
наро-фоминску сто лет
Абрамцевские чтения
Парафин
Средства защиты
роддом в химках
медицина в химках
всемирные игры
жкх химки
диспетчерская химки
велошкола
Акри
вело-дом
исторический клуб
медицина в балашихе
прививочная кампания от гриппа в балашихе
благоустройствовДубне
победители соревнований
Деская больница
богородский горлдской округ
Умный маршрут здоровья
Крест
дополнительный кабинет вакцинации
вакцина от пневмонии
пневмовакс
адреса прививочных кабинетов
универлига факультетов
асск россии
Центр приема обращений
натуральные холсты
тэк
мобильная вакцинация
Пожар в подольске
Усадьба Апраксиных
Кафе-музей в Ольгово
детская мебель
волейбольная площадка
мособлтепло можайск
новая спецтехника
неделя чтения
студент-победитель всероссийского чемпионата
яндекс вектор в балашихе
благоустройство в балашихе
встреча с коммунальщиками подмосковья в балашихе
благотворительный мастер-класс
мастер-класс от футболистов
Мехово
Сергиево-Посадская районная поликлиника
Премия Russian Event Awards
Событийный туризм
Врач-реаниматолог
Отделение реанимации
Подольская детская больница
Лига молодых матерей
автоматизация теплосетей
цифровизация котельных
инвентарь и инструменты
гсм
разнорабочие
содержание и уборка территорий
программа яндекс вектор
автоматизация работы
компания работодатель в бронницах
экскурсия для студентов
межданородный фестиваль
Точкарф
московское малое кольцо
тестирование
МБУКББХ
БудущееПрофессий
детская журналистика
реконструкция м-8
переход лесной
деревня демихово
лучшие кадры
учитель информатики и математики Раменской средне
форум недропользователей ЦФО
оанб
спортивно-туристский фестиваль в бронницах
туристские мастер-классы
бронницкая молодежь
Ремонт моста в мытищах
Мост через яузу
Медицинские работники
обратная засыпка траншей
детский сад 6 звездочка
завоздушивание
Раза
максим горький
путь к безопасности
Дубненскаяшколаискусств
Школаискусств
заявитель
Цифровые датчики
театр танца седьмое небо
выборг
художественный руководитель
татьяна гавриленко
репетиции
Центральная библиотека Зарайска
Культурные коды Зарайска
скоропусковский
картинная галерея Ника
Лев Белов
проект карьера в родном городе в балашихе
ольга егерева балашиха
коммунальное хозяйство подмосковья
выездное обследование
открытые страницы выборг
первое занятие в школе искусств
завершен ремонт детской школы искусств в бронница
яблоневый сквер
ранняя помощь детям
снос аварийного дома
комфортное жилье
колосово
софринский образовательный комплекс
школа 1 в софрино
ремонт школы 1 в софрино
Всемирный день здорового питатья
Система Хорриот
Лицей 1
грунтованный текстиль
художник-анималист
школа 2 в софрино
творческое объединение дружба димы лесникова
тайная жизнь уборщиц
экологический урок
коммунальные предприятия
инициатива губернатора подмосковья
министерство жкх московской области
мбу благоустройство балашиха
экскурсия для школьников на мбу благоустройство б
жкхТалдом
50 лет октября
условная авария на сетях
мобильный маммограф
скрининг рака молочных желез
онкологический скрининг
больницаТалдом
высадка дубов
ямочный ремонт на донинском шоссе
КП Журавли
Выставка художника
добыча и подача питьевой воды
Встреча с прокурором
Детский абонемент
образ
волоколамская
худжник
волоколамскаяволоколамская гимназия
муай тай
Александра Теличко
Магомед Камилов
вечер поэзии
демиховский дворец культуры
школа моделей
молочный комбинат в чехове
детская поликлиника чехов
Школьный телескоп
новая пристройка
зона для мытья колес грузовиков
временная подъездная дорога
стройгородок
устранение второй смены в гимназии
Центр детского творчества Зарайск
Кружок по дереву
Декоративные поделки из дерева
встреча с жителями по благоустройству горенского л
Выездная администрация в Лобне
Зацепинг
я только спросить
дк видное
Силикат
Капитальный ремонт дороги
КраснаяПойма авария ЖКХ Котельная
Авиатехникум
АгропромышленныйТехникум
пластун
оркестр Московия
оркестр народных инструментов
отцовский парк
обновление сетей
Кубок Юного разведчика
МУП Благоустройство Сергиев Посад»
день работников дорожной сферы
женщина энергетик
Пожар на складе
музыкальная щкола
деньоткрыхдверей
научный фестиваль
Новые экспонаты
Дом Морозовых
двойня
ТалдомскийЖКХ
Талдомкзимеготов
ЭкоСтупино
производственная база чехов
подготовка к рейсу
маршрут 1365 чехов москва
водитель валерий ковик
Программа по привлечению медиков
амбассадор добра
урок мужества в музее войск пво в балашихе
Пожар на ярославском шоссе
демиховская школа искусств
день добрых дел МЧС
мероприятие для детей с ОВЗ
конкурскрасоты
дефилеЗасветись
центральный офицерский клуб
12 управление МО РФ
дом юнармии
передвижная выставка У моего порога 1941 в балаших
народные ополченцы
Музей христианского искусства
выставка Лики России
Городошный центр
Всероссийский день открытых дверей
рукопашники
аграрный колледж
Николай Японский
ремонт дороги на леволинейной улице
СХК Дмитров
НСХЛ
благоустройство в люберцах
Площадка для детей в лесу
дши им якова флиера
встреча с актером
фкгс
велошкола Победа
Сообщество Чистый Дмитров
Экоакция Фримаркет
эвакуация раненых
сво гуманитарка
dota 2
мужчины и женщины
поликлиника на пионерской 4
профилактические осмотры
урологи
гинекологи
акушеры
снижение рисков
бесплодие
елена лапшина
заведующая женской консультацией
музей автотранспорта
выставка ретро-автомобилей
грузовики
легковые машины
проездные билеты
архивная фотохроника
бесплатная выставка
данилино
дебютная выставка
Русское народное творчество
пересенцы
рукод
ИТ-образование
Врачи-терапевты
благоустройство клумб
Династия музыкантов
Ансамбль Гудьба
добрые вещи на доброе дело
учения при чп
арт-проект коллекция
эллинг в бронницах
производственно-логистический парк ДорХан Можайс
мир для всех отметил сво девятнадцатилетие в балаш
Зубачево поле
фехтование в бронницах
Воспитательно-образовательный комплекс
Пешеходная сеть
смешанные единоборсьва
Герард Подалевский
Дон
Установка опор спортивной площадки
раменская црб
гто в бронницах
фестиваль гто в бронницах
планеты
строительство путепровода у деревни черное в балаш
капитальный ремонт отмостки
обновление цоколя
улицастанционная
Родительский котроль
Школа 30
Топ 50
Благоустройство в Горках-2
стг
матание ножей
папивинский бульвар
отцы
березовый парк
улица гагарина 48
покраска стен и потолков
замена батарей отопления
ремонт в подъездах
место
лестницы
электропроводка
дошкольное отделение школы 24
сквер в бронницах
префабрика
домокомплекты
музейный комплекс Конный двор
Любовью и единением спасмся»
НЕСМЫВАЙ
Это_не_разлагается
Канализационная система
пожарной службе 20 лет
псч319
вычислительный эксперимент
помощь ветеранам сво в трудоустройстве
ветерана сво устроили на работу на рубин в балаши
межрелигиозные отношения
жкх в серпухове
центр поддержки участников сво
строительство комплекса
уникальное производство в бронницах
Иван Рябинкин
конкурс добровольцев
Гуманитарная помощь на Донбасс
ии в образовании
Екатерина Мизулина
асфальтобетон
подготовка основы
геотекстиль
начальник управления благоустройства
александр тетерин
бани алексеева
Переход над жд
СПКимениЛенина
Уборочная2025
новая детская площадка в бронницах
игровой комплекс на солнечной
Стадион Москвич
Подогрев футбольного поля
транспортная доступность
иванисово
Кабинет охраны зрения
Медицинская помощь детям
Благоустройство поликлиник
школа инновационной педагогики
Вербилки парк
Прогулка по Вербилкам
продукты регионов россии
Центр спортивной медицины
Поликлиника 3
улица садовая
кружок бпла
беспилотные летательные аппараты
занятия со школьниками
дмитрий кузнецов
сборка бпла
управление аппаратами
кгс
Дубнапарковки
Дубнадороги
Талдом дороги
донорская акция в дк кучино в балашихе
доноры балашихи
сезон уборки листвы
поселок 31 октября
улица мичурина
межсезон
первые за чистое Подмосковье
иностранцы
установка видеокамер
монтаж камер видеонаблюдения
универсальный павильон
серверная
новый автомобиль для сшор
машина для перевозки лодок
бронницкие гребцы
гребля на байдарках и каноэ в бронницах
ремонт исторического здания
производство елочных игрушек
поликлиника сергиев посад
нейроспорт
нейромаркетинг
бос-системы
дзержинец
иван вахрушев
вшивцев владимир
боулинг
филиал мострансавто
подготовка автобусов к рейсам
руководитель пб чехов
алексей коркин
медосмотры
набор сотрудников
волантеры
осенний забег
семейный сквер
Спасательная техника
таможенный контроль
автомобильно-дорожный колледж бронницы
образовательный центр 8
транспорт пушкино
канализация ашукино
пушкинский союз садоводов
швейная мастерская
швеи
шитье для девочек
курсы кройки и шитья
благотворительная организация
Ермолино
центр военно-спортивной подготовки
сборка беспилотников
управление дронами
занятия с детьми участников сво
общественная академия национальной безопасности
отряд юных разведчиков
роман балабаев
ростислав круглов
инструкторы с боевым опытом
штурмовая подготовка
Учения бпла
посев газона
сельскоехозяйсвто
осп 5
поликлиника в люберцах
Жк литейный
клуб стекольный
бунин
лаборант
биноскоп
наблюдение
подосковье
новое покрытие
встреча с сельскими старостами
тротуар между литвиново и загорново
сквер Полякова
памятник трактору бронницы
водители пожарных машин
Зарайские студенты
побелка потолков
папе-маше
маски из папье-маше
STARTEEN
деревня давыдово
неделя спорта и кино
Профориентационный фестиваль
Школа танца
Мечта детства
Антер
Надземный пешеходный переход
парикмахер-колорист
чемпионат россии по парикмахерскому искусству
Запрудня благоустройство
Уборка тратуаров
вирусные заболевания
правдинская развязка
мост через скалбу
велодорожка в лосино-петровском
Школа бородино
средняя школа
предкадетский класс
посвящение в предкадеты
артем чурилов
программа герои подмосковья
гимназия им танеева
путеводитель
ремонт автомагистрали
Работа в таможне
Аэропорт Внуково
просветительские лекции
оьразование
Богородский промысел
Фестиваль ледовых скульптур
юбилей колледжа
реконструкция Молодежной площади
трансформация пространства
наро-фоминск перемены
Впкцинация
Памяти героев ВОВ
Патриотичнские выставки
Патриотические выставки
сенсорная комната
день школьных библиотек
Выставка Герои операции «Поток» открылась в Балаши
охраняемая зона
балашихинский историко-художественный музей
колопроктолог
проверка техники
богородица
сергей захаров
директор центра мещерякова
адаптация инвалидов
фонд защита балашиха гуманитарная помощь бойцам св
сергей чураков балашиха
благоустройство горенского лесопарка обсудили с жи
балашиха горенский лесопарк
благоустройство горенского лесопарка в балашихе
Фестивальскалолазания
выставка собак в бронницах
выставка ретриверов в бронницах
российский ретривер клуб
математический фестиваль
школа 19 раменское
день комсомола
комсомольцы-добровольцы
Добрый концерт
ДК им Ю. А. Гагарина
укус ската
врач-терапевт приемного отделения
мбу благоустройство бронницы
экскурсия для школьников в мбу
служу отечеству
андрей балин
музыкально-просветительская программа
военный госпиталь наро-фоминск
многофункциональный павильон
сэндвич панели
установка и монтаж
лаборатория валькирия
Музей истории Лобни
Советская квартира
Светское собрание
покровское
компания шанс
турникеты боевые специальные
тбс
работа для ветеранов сво
Моладеж
Форум Арт-код
день памяти ракетчиков
митрофан неделин
школа дронов
профессии жкх
филейное вязание
фриформ
госуправление
тропа защитников отечества
встреча в монастыре
награждение кадетов
рабочий день
биография артема чурилова
скалодромДубна
арбористы
театрКвадрат
премьераспектакля
встреча помощника раменского городского прокурора
Соболевка
капитальный ремонт дворца культуры
автобус 83
чирлидингДубна
Мама в декрете
станция подзарядки
чемпионат по боксу
театр Наш дом
калека с острова Инишмаан
Строительство бассейна
суворовские пруды
котельная от минобороны в бронницах
обмуровка котла
новая поликлиника в лосино-петровском
школа в лукино-варино
улица пионерская 8
кабинет экг
дежурные врачи
электрокардиограмма
ремонт взрослой поликлиники
4 ноября праздник
дошкольное воспитание
белоомутская школа интернат
деревня никитское
строительство рынка в бронницах
лыткаринский колледж
новое шоссе
советская статуя
влажные салфетки в канализации
источник Саввы Сторожевского
молодежный сквер
60 лет фотоклубу
соревнования по спорту слепых
кубок чемпионов россии по дзюдо
влажные салфетки
лесной каток
прайм парк
питание дошкольников
обед
Свято-Троицкий Белопесоцкий монастырь
векпром
улица митькина
повреждение кабеля
дизайнер украшений
детский сад ивушка
бассейн в монино
бассейн щелково
замена кровельного покрытия
двускатная крыша
новые строительные материалы
набережная юности щелково
благоустройство щелково
встреча с участником сво
выставка поискового отряда
стратегия развития сергиев посада
день бабушек и дедушек
изменение автобусного маршрута 1к
ремонт школы 24 щелково
дом культуры лосино-петровский
высоково
выборочная рубка
санитарно-оздоровительные мероприятия
виктория раменскова
золотая медаль бронницкой шпажистки
спортивная школа олимпийского резерва в бронницах
сшор имееи сыроежкина в бронницах
городское первенство
школа им дагаева
ремонт школы лосино-петровский
Спортсмены монино
мойка для автобусов
автомойка
автоматическая мойка
очистка транспорта
техническое обслуживание
подготовка к рейсам
технический персонал
директор пб чехов
медицинскийфорум
ВолонтерыПодмосковья
выставка экзотических насекомых
пристройка к лицею бронницы
черновая отделка помещений
новый корус лицея в бронницах
сквер в лосино-петровском
консультация для будущих мам
новая дорога в лосино-петровском
светофоры
лицей им менделеева
рождение ребенка
Софья Шинкарева
Детский лагерь юнармеец
Выездная администрация Талдом
Выездная администрация запрудня
Запркдня дк
ввс монино
Пескоструйная очистка
турнип памяти владимира невского
фок Ока
математический конкурс
история волонтера
сквер в щелкове
благоустройство в щелкове
площадь перед дк щелково
каменная кладка
кирпичная кладка
перегородки из кирпичей
зонирование
Люберецкое телевидение
ЛТВ
бронницкие волонтеры
Пристанционная
Колхозная
епископ Сергиево-Посадский и Дмитровский Кирилл
поселок песоченка
дом 4
современная детская площадка
горка качели карусели
песочный городок
освещение и ограждение
местное управление благоустройства
муниципальная программа
Ночь исскуств
школа 24 в монино
пешеходная зона в щелкове
молодежная набережная щелково
школа 5 в щелкове
лицей 14 в щелкове
Дк прогресс
корабль союз
новый предмет
Мособлводоканал
парковка без оплаты
демонтаж аварийного дома
взу власиха
взу центр
трансформация
укладка керамической плитки
монтаж подоконников
сергиево-посадская городская прокуратура
дтдм истоки
День тренера талдом
Талдом атланта
конкурс женского предпринимательства
нежный грант-2025
Газпром газобезопасность
артулочкартк
посад поет
царская деревня
музыкальный проект
известные хиты
подземные пешеходные переходы
фестиваль песни
шаинский
финалистки конкурса нежный грант-2025 в раменско
кабинет неотложной помощи в бронницах
график работы кабинета неотложной помощи
неотложная помощь в бронницах
комиксы
военный городок чехов-7
уборка придомовой территории
ремонт качелей и горки
жительница деревни
екатерина кузьмина
Концертклассическоймузыки
деревня щемилово
навес для колясок
Вручение ключей от автомобиля
музей валенков
НПО машиностроения
возведение перегородок
прием специалистов ники детства в раменской детск
школа будущих родителей
парта героя в автомобильно-дорожном колледже
выборы в школе
детская дума
дос
дом офицерского состава
власиха дос
Дом купца Воронцова
диспансеризация в зарайске
ветхое здание
льготная аренда
Осенний салон
майданово
история физтеха
Купол храма
Храм в Лобне
биеннале
духовная музыка
профессиональные пробы
больница в можайске
молодежный центр атмосфера
мгэр
центр культуры и досуга
патриотическая конференция
День народного единства запрудня
Библиотека талдом
село новоселки
компания полимер компаунд
производство полимерных смесей
уплотнители
шланги
кабели
новые виды продукции
земля без торгов
постановление губернатора подмосковья
заместитель главы округа наталья маминова
управление промышленности инвестиций и предприним
екатерина зыкова
генеральный директор алексей чижмаков
занятие со школьниками
стадион имени толубко
команда рвсн
благие дела
раздача пищи
социальная столовая
шатура ярмарка
коледж
всероссийский турнир по трем видам борьбы
четырнадцатый турнир памяти майора михаила кузнец
турнир по борьбе памяти майора михаила кузнецова
российский актр александр левин стал гостем турни
российский актер александр левин стал гостем турни
лшкола
библиотека им гайдара
перформанс
акция ночь в музее
рисунки чехова
чехов и музыка
китайская пианистка
цзыцин цзэн
произведения бетховена
виртуозное исполнение
музыкальная программа
массовый забег в бронницах
гермес икс кросс бронницы
солнечногооск
основы безопасности
скрипач георгий ибатулин
пианист егор сидоров
художник антон чубаков
скульптор елена милейко
набор детей в греблю
праздничные дни
3д-печать деталей для бпла на сво в балашихе
комплекс
воздушное судно
романовы
кризисный психолог
школьники Балашихи изготовили необычные обереги дл
кмз
климовский машиностроительный завод
педагог наталья яшина
акция ночь искусств
министерство культуры и туризма подмосковья
создание кукол
марковская республика
акварелакс
робоспайн
моснейро
нейрософт
психологические тесты
внутренние коммуникации
кондиционеры
центр русской культуры
русская калиграфия
роспись русского севера
обустройство автостоянки
проезды и проходы
поручение губернатора подмосковья
Детский музейный центр Матрёшка»
детский оркестр народных инструментов Московия
центр Московия
оркестр телерадиоцентра Орфей
чардаш
фестиваль бокса и кикбоксинга
Музей Зоя
исторический квиз
Соревнования по танцевальному спорту
Кубок высшей лиги по танцевальному спорту
ночь искусств в балашихе 2025
программа россия родина единство
конкурсы и викторины
архангельцы в бронницах
сбор гуманитарной помощи в бронницах
ансамбль рвсн
красная звезда
концерт во власихе
Деньнародногоединства
в парке пехорка отпраздновали день народного единс
Ночь искусств шатура
Филимоновские игрушки
день народного единства в бронницах
день народного единства в зарайске
русский карильон
золино
парк орехово-зуева
ансамбль авангард
ансамбль подмосковный сувенир
патриотические акции
флаги народов россии
песня небо славян
детская развлекательная программа
Творчество Подмосковья
долгопрудненский историко-художественный музей
яства
летучий корабль
День народного единства вербилки
День народного единства Талдомский округ
национальные диаспоры
флаги регионов россии
акция дружба народов
исторический тест
выставка достижений диаспор
диаспоры ленинского округа
доброкот
дкдц Полет
водники
праздничный концерт в дк сатурн
театрализованная экскурсия
Золочение креста
отдарок на подарок
тряпичная кукла
Павловопосадские платки
передернина
гохуа
опехово-зуевский округ
проходы и проезды
центр творчества
Школа 16 подольск
новая секция
атлетика
Ремонт соматического отделения
библиокафе
новое пространство
в парке пехорка балашихи установили новогоднюю елк
статуи
деревня костомарово
улица лесная
председатель совета депутатов
галина козина
татьяна никитас
программа инициативного бюджетирования
подводное плавание
контрабас
ДеньОВД
Деньполиции
деревня Напольское
Юрий Емелин
Голованов
новощапово
айти-куб
Власиха творчество детей
детский творческий конкурс
детский сад власиха
ремонт спортивного учреждения
вперед в будущее
в парке пехорка балашихи устанавливают каток 2025
балашиха парк пехорка
анна ахматова
грабли
клены
Геодезисты
новый врач-ортопед
расширение м-9
дворец торжеств шаховская
школьные автобусы раменский округ
ФОК Орбита
Переаттестация
титул
строительство котельной
новостройки в волоколамске
ветхое жилье в волоколамске
гепард
улица Чайковского
Замена светофора
бронницкая детская школа искусств
преподавате фортепиано в бронницах
МБУ Благоустройство СП
благоустройство тропинки
Большой этнографический диктант
медицына
Подольский союз молодежи
В спорткомплексе Метеор» Балашихи открыты бесплатн
благоустройство 2026
Фестиваль народов мира
завод горячего цинкования в можайске
Сергиево-Посадская районная больница
Ремонт остано
творческий мастер-класс по изготовлению оберегов
обновление дорог в можайском округе
жители дома
Добрые сердца Голицыно
День рождения волонтеров
госпитальная
Тратуары
Асфальтирование тротуаров
Тротуары у пруда
кмж
клуб по месту жительства
народный жим
штанга
новый автобус бронницы
бронницкое патп
автобус лиаз в бронницах
без гаджетов
гфз
трасса водоснабжения
укладка новых труб хвс
траншея
теннисный центр шаховская
школа в колычево
школа в можайском
давыдково
сергиево-посадское лесничество
минерализованные полосы
скажина
строительство камеры
краны вентили
улучшение качества водоснабжения
встреча со школьниками
городской прокурор
вадим шишкин
защита от телефонных мошенников
помощник прокурора екатерина сикорская
дропперство
интернет-платформа роблокс
подставные лица
соучастники преступлений
Открытие моста
Дубненскаяверфь
Врач-рентгенолог
Поаздник
В микрорайоне Янтарный Балашихи прошла встреча по
икона неупиваемая чаша
В новой больнице в Ольгино в Балашихе приступили к
ольгинская больница в балашихе
диспансеризация в бронницах
маршрут 46
власиха одинцово
автобус 46
туристическая премия
депутаты власихи
многонациональная страна
фнс
День рентгенолога
дк чулковский
Центральная городская библиотека имени А С. Горло
Центр культуры и искусств
арт-выставка vr-погружение в коломну
Уборка листвы талдом
выставка доисторические насекомые в янтаре открыта
ульянки
распределительный пункт
северные электрические сети
пушкинский сквер
дороги многодетным
Контейнеры для одежды
кандидат медицинских наук поделился опытом с раме
авиационный кружок
краснозаводская школа 1
центр сво
медаль Суворова
дши им чайковского
школьный концерт
народный гармонист россии
концерт гармонистов
Победа 80-летие
Зима в Подмосковье 2025
центр подготовки витязь в балашихе
сабля
гонка дронов
диорамы
осенний бал
муп инженерные сети
иван да марья
усадьба брюса
спорткомплекс Луч
Авторская кукла
тюльпановый остров
savebykovo
Прокат инвентаря
Веломобили
медицинские классы
футбольная лига в бронницах
подростковая футбольная лига
гимназия имени пушкина в бронницах
одинцовская детская музыкальная школа
история игрушки
савельев
осенний кубок квн
полимер компаунд
полимерные смеси
отечественная продукция
директор компании алексей чижмаков
новые рецепты смесей
помощь землякам
впк
Дом ветеранов СВО
молодежный медиацентр
Снегоуборочная кампания
Готовность техники к зиме
грануляты
уплотнители для холодильников
оконный профиль
пвх
гидрант
облицовка фасада
наружные стены
окна и форточки
остекление дверей
стеклянные панели и блоки
погрузочные работы
Прогулка с ребенком
Прогулка с детьми
Клуб мам Лобни
сенежское лесничество
санитарная вырубка леса
рошаль мчс
МБУ Благоустройство СП»
Школа искуств запрудня
Врач - эндокринолог
племзавод пойма
спорткомплекс метеор им еа донской балашиха
мама особенного ребнка из Балашихи рассказала о по
санитарная рубка леса
малоинвазивные операции в урологии
профилактика и лечение мочекаменной болезни
день сотрудника органов внутренних дел
Новая волна
председатель дома
обустройство подоконников
остекление дверей и форточек
обезвреживание опасных медицинских отходов
кластер для обезвреживания отходов в воскресенске
наставник z
Мишутино
Школа 22
Золотые ручки
откосы вокруг окон
гимназия им татищева
Штукатурка стен
строительство стадиона
Спорткомплекс Звезда
александр поволоцкий
ЖКХ Балашиха
трубы теплоснабжения заменили по улице Сверлова в
МОВИР
коррекционная школа-интернат
100-летие
благоустройство прилегающей территории
кормушки для птиц
музей-усадьба пушкиных
горячая линия главврача
вызов врача на дом
жалобы и проблемы
отзывы
личный прием главврача
телефон 122
Люберецкий авторемонтный завод
Лом
богородск
Московский областной открытый фестиваль конкурс Об
владимир мочалов
карикатура
ук посадское обслуживание домов
мягкая крыша
установка парапетов
жкх в бронницах
новые теплосети в бронницах
аэропорт жуковский
Центр нейропсихологии и коррекции речи
Здоровый ребенок
новая блочно-модульная котельная в бронницах
деревня жучки
косыгинские
Никита коньшин
Спасение педагога
Подольский комбинат благоустройства
капремонт здания
замена окон и дверей
в парке пехорка заливают каток 2025
прием в фапе
Софринское водохранилище
Ступинская Нива
ЭкоНива
сушка кукурузы
улица михеенко
площадь хотьково
малые технологические компании
дымокамера
Киношкола
Блаустройство
конкурс учитель года
отборочный тур
плановые работы
Рынок запрудня
Талдомскиц округ
качели-балансиры
Дворец культуры Октябрь
Спил веток
Пильняк и Коломна
открытый урок по физике в раменской средней школе
производство домокомплектов в кашире
завод в кашире
монтаж оконных блоков
детская площадка в видном
день сотрудника МВД
Моя полиция меня бережет
юбилей всероссийского общества слепых
завод в можайске
обновление крыши
новые перекрытия
снос нто
Мы - граждане России
монтаж металлоконструкций
пожарная лестница
перегородки
открытый урок по истории в раменской школе 5
Интересные люди Подмосковья
Борис Львович Непомнящий
лучший староста подмосковья
экогуд
единый дорожно-транспортный центр
борьба с сугробами
медиа класс
учитель-логопед в бронницах
методы работы догопеда
день логопеда
информационный пилон
путешестие
Школа юного инженера в Орехово-Зуеве
съедобные кормушки
центр поддержки инициатив
лесная зона отдыха
монтаж и покраска
монтаж полов
замглавы округа александр ротнов
союз Содействие женскому предпринимательству в бр
конкурс нежный грант в бронницах
женщина-предприниматель
Центр Истоки
Филиал на Февральской
очистные в кашире
машина для сво
социальный спектакль
центр профилактики общественного здоровья
реставрация церквей
богородицерождественская церковь в клемово
Обустройство пешеходных тротуаров
VR-проект
центральная детская библиотека
керамист
день ракетных войск и артиллерии
станица
чистое поколение
Световая проекция
образование и культура
центр хорового искусства юность россии
праздник посвящения в музыканты
ангелы победы
теплый плед
добрые инициативы
благоустройство в кашире
улица советская кашира
котельная в кашире
креативный кластер стачка
новая набережная
котельная на улице коммунистическая
педколледж
Школа имени Героя России
лосины
верблюжья варежки
детский сад 13 в кашире
капремонт детского сада в кашире
Всемирный день борьбы с диабетом
Площадку для выгула собак в микрорайоне Южном Бала
благоустройство балашиха
аренда коньков
День памяти жертв дтп
стоматологическая установка
механический завод
водопроводный колодец
парковкидляинвалидов
нефрология
90-лет юбилей
владимир школьный
конкурс воспитатель года
переработкашин
шамиль тарпищев
Пушкинский парк
Подольский драматический
золотая осень-2025
день работников сельского хозяйства и перерабатыв
награждение аграриев
всероссийское общество слепых
мир животных
мир животных в мире искусства
отдел художественных ремесел
Стеклянный зверинец»
конкурс моя россия балашиха
Снежки
маша постная
уборка снега в бронницах
жкх наро-фоминска
Центральный парк Лобни
жестянщика
Министр здравоохранения Подмосковья
ахпк
художественно-промышленный колледж
университет строганова
резьба по кости
Максим Лаврентьев
Сергиево-Посадский окгуг
день недоношенных детей
детская реанимация
мисс долгопрудный
пройди свою кругосветку
Лор-отделение
я гражданин россии
театр-студия сказка
СП ДРСУ
ЦМСЧ 94 ФМБА
Музыкальный инструмент
видное za победу
мтди мо
подъездные пути
основа для фундамента
штурмовка
международный день недоношенного ребенка в балаши
школьник из балашихи стал серебряным призером межд
гимназия 1 ярослав мишуровский
фестиваль современного искусства
пижемская роспись
улица ильича 34а
лицей 4
утепление наружных стен
пожарные лестницы
наружные работы
Культурный центр ландау
Молодые театралы
капремонт школы в морозово
Подмосковная лига КВН
спортшкола наро-фоминск
вынос кабелей
система электроснабжения
Спецтехника для Водоканала
научный лекториум Капицы
Сергей Язев
уникальность солнечной системы
Бригада приступила к подготовке траншеи в Балашихе
теннисный корт на быковского балашихи
трамвайчик
чистовая отделка
облицовка панелями
квестбук
фестиваль Перезагрузка
парковые качели
курсы для детей
здание администрации Сергиев Посад
папивино
Новое общественное пространство
мобильный храм
храм часовня
ремонт ухтомской больницы
выставка картин виктора неплюева в раменском исто
кубатуры
Папанинская дача
благотворительная акция крупинка добра в парках ба
робот Монти
окна производство
восемнадцатиметровую новогоднюю елку собирают на п
футбол для слепых
фпср
водное поло
спорт для жизни
стальной характер
спорт для ветеранов сво
соревнования для ветеранов сво
деулино
деулинская слобода
естественное лесовосстановление
завод импортозамещающего оборудования для ЖКХ
завод в коломне
Чтецкие программы
музыкальная школа коломна
МГЕР 20 лет
школатв
тренинг по вокалу
Дк металург
Микрорайон Львовский
Львовский
парк 50-летия Октября в коломне
благоустройство коломна
УЗИ для урологии
ключи от квартиры в бронницах
переселение из аварийного жилья в бронницах
голицино
пожарная часть 65
тск
белки в парке
поликлиника на улице гагарина 37а
кабинет маммографии
отрыта запись
цифровой аппарат
всероссийский турнир тот самый физрук
НТО
Павильоны
ул Горького
виж имени эрнста
Болшево
мамонтово
снт озерки
прокуратура рассказала медикам балашихи об уловках
быстрые шахматы
чеховская школьная лига
федерация шахмат чехова
евгений рябинин
главный судья елизавета крылова
единая школьная лига московской области
фестиваль-конкурс живица
Жители Балашихи оценили ремонт подземного перехода
Северные пруды
Культура Одинцово
Династия дирижеров
Нонна Гришаева
буратино
Танино
велошредер
оксана скала кошелева
Модернизация водозаборного узла
Парковка спецтранспорта
зональный этап в раменском
горизонт коломна
молодежный центр коломна
технологический инцидент
Майя Плисецкая
медицинский центр
пондус
кральцо
ммк
Поселок молодежный
Выездной маммограф
буйгород
Поликлиника 1
выставка заслуженного художника россии
амбассадор
тренер по вольной борьбе
Первенство по шахматам
деревня капустино
капремонт плотины
система водосброса
мбу экология и природопользование
сергей дьячков
ЖК Равновесие
КаткиПодмосковья
Катокнанабережной
КатокуВолны
Выставка производств в ОАЭ
здание прокуратуры
прокуратура солнечногорска
Вербилки благоустройство
программаторы
ритм сердца
центр культурно-общественных связей
водовыпуск
земляной вал
каток в видном
подстанция скорой помощи ленинский
скорая помощь суханово
премия ученым
каток в центральном парке наро-фоминска
выездная администрация в бронницах
обращения жителей бронниц
вопросы жкх и благоустрайства
уборка подъездов
урожай 2026
растеневодство
наталья алимова балашихинская больница
завод косметики солнечногорск
студентам Балашихи рассказали о героях отечества
гу мвд россии по московской области
танцплощадка
контейнеры для покрышек
Снос домов
начало зимнего сезона
органный зал
в созвучии с органом
Арсений Чумак
храм новомученников орехово-зуевских
освящение росписи храма
трасса м-3
дороги наро-фоминск
Мир исторической реконструкции
скейт-площадка ленинский
образосание
суз
Нижний пруд
Жителей Балашихи познакомили с Театром кукол» Серг
сергей анохин
елена елистратова
МузейДубны
всероссийские педагогические чтения
запись на обследование
система врач-врач
первичный прием врача
направление на маммографию
терапевт мария корнюхина
сельский дк
борьба с курением
проект здоровье для всех
золотая корона россии
главная корона подмосковья
кристаллография
Колледж знание
Научнаяконференция
ГУД
лекториум капицы
квантовая физика
искуствоведение
искусствовед
врач пациент
территориальный отдел
День хирурга
техногогии
экологичная упаковка
традиции востока
бульвар 65-летия победы
Конкурс лучший двор
детские павильоны
горки качели песочницы
гимназия 15
жилье для ветерана сво
лаборатория волновых процессов
гуманоидные роботы
робоспорт
забег роботов
тяжелый гуманоидный робот
власиха микрорайон спортивный
улица маршала жукова власиха
брусья
центральная библиотека люберец
реконструкция объекта культурного наследия
открыто для всех
незрячие
опека и попечительство
ребенок сирота
Дорперы
Всероссийский родительский комитет
Региональный родительский комитет
ледовый сервис
Теплотрассы талдом
Запрудня теплотрасы
резиденция деда мороза в бронницах
зимний сезон в парке
снегурочка берегиня в бронницах
кубок России по нардам
Крытый рынок запрудня
музей-резиденция
спч 52
новая отмостка
день гармониста
Медицинский лифт
Строительство лифта
Понтонныймост
Стеша и Микеша
новые автобусы в бронницах
пассажирский автобус бронницы
новый год 2026
дк радуга
шатура новая котельная
Благоустройство СП
зимнее содержание коров в бронницах
Аудиосериал
Театр студии Лилиум
Юные артисты
роборорука
ильинское-усово
кружок робототехники
митьки
шатура выездная администрация
мурал Чуйков
Притягательный завод
Ирина Виниченко
расписание общественного транспорта
заведующая удельнинской поликлиникой анна конченк
детский сад солнечногорск
новая ферма
санитарные рубки
Фонд капремонт МО
анемия
анализ
выставка Золотой век
гравюра
экзотические животные в бронницах
экзотические животные в квартире
змеи в бронницах
Развитие инженерной инфраструктуры и отрасли обра
канализационный коллектор
диляра садриева
год единства народов россии
Стройка для переселенцев
спорт в солнечногорске
Паромы
ассоциация ветеранов СВО серебряные пруды
разговор на равных
помощь беженцам из херсона
помощь беженцам из сирии
парикмахер-стилист
электроизолятор
каток в солнечногорске
стадион школы 4 в солнечногорске
привокзальная площадь павловский посад
благоустройство в павлово-посадском
Звенигород мероприятия
Николай Рерих в Звенигороде
Урок для школьников
Производство лазеров
каратэ эншин
матери бойцов сво
Маркова
Марковка
чемпионат ползунков
библиотеки солнечногорска
центр образования истоки
центр образования павлово-посадский
фап в назарьево
фап в павлово-посадском
благоустройство в электрогорске
детский сад 15 павловский посад
парк меленки
благоустройство павлово-посадский
стадион Филимоновский
стадион Филимоновский в Павловском Посаде
рыболовный спорт в бронницах
турнир по ловле рыбы на спининг
Игрушки ручной работы
георгий жуков
новый 2026 год
зими в подмосковье
украшения города к новому году
украшение бронниц к новому году
открытие зимнего сезона в бронницах
шатер из гирлянд
новогодняя инсталляция
гигантская коробка
шишки
Зимний парк Леко
центральные улицы
фирменные баннеры
гирлянды и игрушки
плакаты
чемпионат дошкольников
зима 2025
шатура парк
Устройство
Иновации
Балашиха готовится к новогодним праздникам 2025
театрализованное представление
катание на санях
программа зимний калейдоскоп
прокать коньков
Зажгли елку
1 декабря Талдом
Елки запрудня
Городские украшения
Начало зимы
празник в парке
Зима в Подмосковье
открытием резиденции Деда Мороза дали старт зимнем
парк семейного
Звенигородская афиша событий
БратьяСафроновы
парк ивановские пруды
Зажглиелку
Нии
Рыси
металлочерепица
акция для бойцов
ансамбль живица
русский фольклор
Сестры милосердия
голд фиш
Выставка советского быта
Новые остановки
Машина с ручным управлением
азбука футбола
тренировка по футболу
дши голубкиной
авария на трубопроводе
детские вещи
косино
завершение прививочной кампании
российская вакцина
условия приема
эстафета добрых дел
Сергиев Посад Серебряный век
Лучшие издания по истории России
старые игрушки
двойной успех
профессия для старшеклассников
Зимний квиз
Квиз для детей
благоворительность
Новый дом для переселенцев
Новый год запрудня
Запрудня 2026
детский сад аистенок
Деньинвалида
школа орехово-зуево.
сторонники
прокуратура долгопрудного
встреча с жителями в средней школе 35
Конная спортивная школа
Глава Котельников
ребенок инвалид
Мкханический протез
пристройка к школе 7
Дополнительные маршруты
Ренгенолог
канализационные трубы
гостевая парковка
рост количества приемов
выписка льготных лекарств
закрытие больничного листа
электронные рецепты
результаты анализов
направления
запись на онлайн консультацию
портал здоровье
мобильные приложения
лазерно-гравировальный станок в школе
лазерная лаборатория в школе имени Тимофеева
лазерная лаборатория в бронницах
Реконструкция котельной в Одинцово
Шкала сахарного диабета
изолятор пик
главврач чеховской больницы андрей попов
объем качество сроки ремонта
справка в одно окно
терапевты
прием врачей
узкопрофильные специалисты
Мемемориальная доска
строительство рыночного комплекса в бронницах
лесопарк стрелки
рисование вслепую
ветхоежилье
бутовская сош 2
исторический объект
Аккумуляторы
ремонт ступеней
кункурс
Кабинеты хниз
Новая книга волкова
белая церковь
Митинг на площади Победы
Международный день добровольца
татариново
поселок зубово
новогодние арт-объекты
резонит
Уроки Второй мировой
Урокр добра
Фок олимп
День контарнуступления
Мемориал славы вербилки
воспитание молодежи
кардиологическое отделение
коробовский лесопарк
группа компания самолет
лучший врач года
замена электрооборудования
блог
социальные сети
новая философия воспитания
центральный каток округа
парке имени Воровского
Андрей Владимирович Васнецов
Поленовская дача
выставка клуба александровских художников
волонтер года 2025
Ремонт теплотрассы Запркдня
Тепло в Запрудне
Родильныйдом
глава долгопрудного
маскировочная накидка
деревня данилово
дк данилово
дк ашукино
Научно-исследовательский центр
советская игрушка
турнир александра невского
соревнования силовых структур
ОМВД серебрянопрудский
ремонта паллиативного отделения
Фестивальнауки
быт
новый выставочный зал
Тц
вячеслав бутусов
форум встреча
главный каток
каток под открытым небом
церемония открытия
заточка коньков
предварительная регистрация
расписание сеансов
срочники
корова-рекордсменка
гжель в царицыно
валентин розанов
Краеведческий проект
день художника
Новостройки в мкр Левобережье
государственная третьяковская галерея
классицизм
Семья Романовых
Программа капитального ремонта
передвижной музей СВО
волонтеры и добровольцы
сухие пайки
образцы вооружения
видеоролики
первый в россии передвижной музей сво
впервые в чехове
чеховская кашеварочка
добровольный гуманитарный волонтерский полк
сво-797
ирина черникова
максим позывной ветер
Режиссер из Зарайска
Победитель в конкурсе
Новыйпереход
Высокотехнологичная медицина
станислав ибрянов
криа
шипперке
бельгийская овчарка
собака-диверсант
отделение стоматологии
продуктовые наборы
ударные дроны
Новая черноголовская школа
Ирина безрукова
новогодний автомобиль
светящаяся машина в бронницах
машина в гирляндах
новый год в балашихе
аксиньино
Стройтехсервис
Благоустройство Вишняковского лесопарка
путепровод платформа черное
путепровод в балашихе
соццентр
возведение стен
герои власихи
Ремонт детсада
выставка художницы
транспортный инкубатор
длинномеры и большегрузы
площадка для разгрузки и разворота
башенный кран
основание под кран
фундаментная плита
подбетонка
каркас из арматуры
ооо воздвижение
мойка для машин
мойка для колес машин
Герои Зарайской земли
береговая территория Борисоглебского озера
благоустройство зоны отдыха у воды
гризодубова
герои отечества
Руберг
герои Советского Союза
подмосковныйврач
премияврачей
декабрь
маргаритки
открытие парты героя в бронницкой школе
каток в парке Пехорка
каток в балашихе
Археологический форум
елка в парке Талалихина
новый год в подольске
елка в подольске
Кубок имени Эрнста
лесопарк в люберцах
путепровод в люберцах
день героев
каток в люберцах
елка в люберцах
Модельная библиотека раменское
каркас для фундамента
армирование
арматура
вывоз грунта
Проект Смотри Знай Думай
Минюст
Мининформ
рошаль дороги
Уборка снега талдом
Снегопад талдом
физкультурно-оздоровительный комплекс в бронницах
Подключение воды
комплекс по производству шунтов для трансформатор
Первенство Азии
пристройка к школе 9
школьники на экскурсии
авторские куклы
арт-студия абажур
терраформинг
метапоэтическое зеркало
поэзия хайку
суп для бойцов
Новый пешеходный переход
временные неудобства
Ремонт поликлиники Талдом
Талдом медецына
Талдом здоровье
библиотека им горького
месяц добрых дел
Подарки для особенных детей
бронза
лор
рудн
Галина аксенова
Елена княжева-карцева
спортобъект
ледовый городок
спортивная школа парус
реставрация кукол
сила веры
открытый космос
астронавт
каток в парке Талалихина
каток в подольске
Поисковое объединение
консорциум вузов ЦФО
Новые мемориальные доски
монтаж перегородок
Телеканал Радуга
межведомственный семинар
витражное остекление
Новогоднеенастроение
декабрята
ель из рузы в кремль
Лемана ПРО
Логоцентр Северная звезда
новогодняя шоу-программа
ликвидация аварии на теплотрассе
Строительство новой котельной в Зарайске
основание под веранду
рошаль медицина
рошаль в лицах
вузы россии
благоустройство озера
дрезненская дши
дом-музей чайковского
детский сад при школе 27
140-летие абрамцевского колледжа
филиал строгановки
мастера народных промыслов
пристройка к школе 16 в подольске
Реабилитация бойцов
Вождение машины
госюрбюро
мобильный офис
река сухмань
слободка новоселки
дорога Торгашино-Кубринск
искусственное сооружение
инновационные проекты школьников в бронницах
Налоговая конференция
Налоговая реформа
освобождение
тепло сердец мы дарим нашим пациентам
Шаг в науку
законы
русская матрешка
дети до 13 лет
фигуры
главный судья полина прощенко
Компания Инно-Инжиниринг
командные состязания
бассейн олимпийский
комби
Дополнительный автобус
Деревня Ермолино Талдом
Школа в Ермолино
Школа 50 лет ермолино
полимерная глина
выставочный зал карапаева
Павловичи
правовой экзамен день конституции рф
реконструкция городского стадиона
12 декабря
Волковское шоссе
чай с вареньем
серебряные прулы
выставка игрушек
Ирина Митюрина фонд защита балашиха
театр школа
Пкб
спортивная школа орбита
скобелевские сборы
любительский турнир по гандболу
любители и профессионалы
разные возрастные категории
рекордное количество команд
круговая система
отборочные игры
матчи плей-офф
расписание игр
крупнейший в россии турнир
всероссийские соревнования по гандболу
министерство спорта и туризма подмосковья
новогодний праздник в парке
интервью с дедом морозом
парки сказки торжество
зимв в подмосковье
дерись только на ринге
паркисказкиторжество
конкурс костюмов
Технологический университет
снежная пушка
группа ночъ
Зимушка Зима
Сноуборд
первый снежный день зимы жители балашихи вышли на
истравидение
Активый отдых
бесплатные сеансы катания
Каток в Пушкино
лазутинка
новогодняя атмосфера
почта деда мороза в раменском парке
Зарайский парк культуры и отдыха
Резиденция Деда Мороза в Зарайске
зимняя сказка
парк на набережной
светящие инсталляции
парки в подмосковье
Подольская теплосеть
рейд ск
таболово
газификация подмосковья
кулинарный мастер-класс
группа дюна
наталья сенчукова
добро вера
Горенское лесничество
акция наш лес
ледовые фигуры
пироговский лесопарк
благоустройство в мытищах
парк Папанинская дача
парк в королеве
детский сад 5 в королеве
каток в королеве
каток у дворца культуры королев
компания Ялка» расширяет производственные мощности
вадим кенин гендиректор компании ялка
Коттеджный послок
новогодние автобусы в бронницах
автобусы зима в подмосковье бронницы
брендированные автобусы в бронницах
елка в королеве
новогодняя елка на центральной площади королева
Первомайский
открытие съезда
Свечи ручной работы
3d фонтан
Зарайские пловцы
Афиши
медвель
новогодние елка
дс восток
международная школа
мфгс
праздничные украшения
школа 16 орехово-зуево
капремонт школы 16
школа 20 орехово-зуево
капремонт школы 20
победитель муниципального этапа
техникум в орехово-зуево
елка в ликино-дулево
кен-ко
учебный центр ксрк вос
учебные курсы
курсы для слепых
реабилитация для слепых
мобильные устройства для слепых
Молодой медик
национальный проект семья
Конкурс мчс
елка в лесу
шариха
Ветеран СВО из Балашихи стал управленцем по програ
илья агафонов ветеран сво балашиха
эра
робот софия
тасс
собкор
контакт-центр соцзащиты
цисс
центр инноваций социальной сферы
клинское подворье
музей елочных игрушек
композитные панели
новые пластиковые окна
обновление входных групп
Уполномоченный по правам предпринимателей
старатели
Выставка модернизма
библиотека горловского
немчиновская амбулатория
Прокуратура Зарайска
Встреча прокуратуры Зарайска с жителями
КриоАЗС
криогенная газозаправочная станция
Киберпреступность
ремонт стен и потолков
радиаторы отопления
внутренние инженерные сети
финишная отделка
Евгений Шварц
виртуальный актер
школа в кабаново
тренер по плаванию
система долговременного ухода
новогодний арт-объект в бронницах
новая фотозона в бронницах
Луховицкая школа 1
авторские игрушки
дк луч
день памяти военных корреспондентов
выставка про военкоров в бронницах
Выездная администрация в Балашихе ребёнку-инвалиду
Выставка елочных игрушек
Пцущино
конкурс на новогоднее оформление
Незаконная вырубка елок
Патрулирование лесов
Горнолыжный сезон
встреча с сотрудниками организации в поселке родн
клинский филиал лесничества
гимназия им ушинского
электротсаль
Три сестры
навигация туристическая
Министерство культуры и туризма Московской област
юбилей школы имени Тимофеева
115 лет школе в бронницах
старейшая школа Подмосковья
новая сцена
профессиональная сцена
можайские юнармейцы
профилактика гриппа и орви
Итоги 2025
капремонт канализации
новообразования кожи
клубочек
Ремонт моста в Зарайске
Мост через Осетрик
сохранение истории
Новости Звенигорода
квартирники
Акция ель домой
Ель на новый год
Питомник елей
областная олимпиада старшеклассников
социальная реклама
поделки из гипса
рвсн 66 лет
лариса новикова
управление благоустройства
Победитель в Большой Перемене
Заболеваемость гриппом
обработка территории
Розетка
Кукольные истории Татьяны Бирюковой»
Реклама в транспорте
лотошинский дк
точка старта
Стипендия Правительства РФ
урбантех
пассажирам
новогодний забег
Онконастороженность
незаконная реклама
Молодежный центр космос
Никольский фестиваль
конькобежный центр коломна
Слет дедов морозов
олег дадонов
фестиваль про_морозов
шествие дедов морозов
Елки в Королеве
елка в парке 30-летия Победы в Орехово-Зуеве
Мосагрофуд-Д
ИТ-сфера
Будут нужны сборщики и технологи около ста жителей
ялка балашиха
новые павильоны
теневые навесы
игровые зоны
качели горки карусели
капремонт социальных объектов
цифровизация библиотек
серебряные полонтеры
инвентаризация библиотек
Лекция профессора
Открытие после ремонта
бизнес во власихе
предпринимательство власиха
власиха недвижимость за рубль
ассоциация ветеранов СВО солнечногорск
Елка губернатора
усадьба кузнецовых
елка на воде
новогоднее шоу
дельфин
английская конюшня
наливной пол
мощность
конкурс волонтеров
поющие хором
прааздник
выставкаживописи
благотворительная новогодняя акция
елка желаний в бронницах
В новой больнице в Ольгино Балашихи приступили к у
больница ольгино балашиха
Одмнцовскому филиалу МГИМО 10 лет
Система образования МГИМО
глафира
Открытие памятников погибшим в СВО
Новые памятники на аллее славы ДК Леонова
комитет по соцполитике
новый год в ногинске
елка в ногинске
каток в ногинске
семьиадминистрация люберец
проищводство изделий из металла в бронницах
завод металлоконструкций в бронницах
Северный подъезд к Лобне
выдающиеся люди
ремесленная
переходная зона
световая инстоляция
Водороная энергетика
фонд благие дела
поликлиника в ногинске
новыйгод2026
Новый год с Даринкой
путепровод на обуховском шоссе
путепровод в солнечногорске
окончание ремонта
вакцинация от пневмонии
Новаяулица
Рафаэль. Версии»
газификация дома ветерана СВО
льгот ветеранов СВО
детсад аистенок
ремонт улицы гагарина в лобне
благоустройство в лобне
сквер юбилейный химки
каток в химках
торгашино
елочка-2025
елка под охраной
сбор текстиля
экобокс
Мособлводоконал
фдрц кораблик
Детский реабилитационный центр
ароматы
школа в павшинской пойме
елка в красногорске
каток в красногорске
вывоз
власиха уборка снега
улицы власихи
снег на улице
тоннель на Путилковском шоссе
дороги красногорска
ублрка снега в бронницах
устранение снегопада в бронницах
семьи в трудной жизненной ситуации
волонтеры можайска
уборка улиц и дворов от снега
муниципальное отделение фонда Защитники Отечества
Поздравление ветеранов вов
Поздравление с наступающим новым годом
обработка улиц
очистка тротуаров и пешеходных дорожек
научные эксперименты
Вербилки теплосети
Кубок святых воинов Руси
бронницкие автомобилисты
Капремонт сельских клубов
Открытие двух ДК в Зарайске
путь к олимпу
Отполение
тэк 2
фитофтороз
молекулярная биология
колесный робот
рождественская выставка